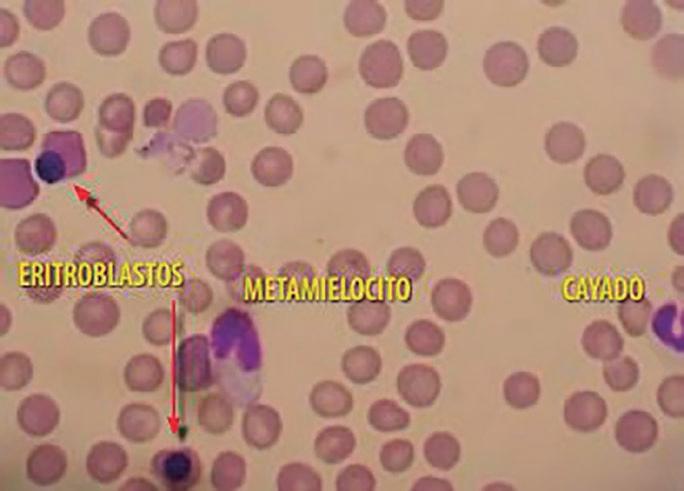

Proyecto de especialización

SEO local Cirugía de urgencia (y III)
• Abordaje del politraumatismo en gatos
• Manejo anestésico en una gata sometida a craneotomía
• Displasia de cadera
• Tratamiento quirúrgico de la subluxación atlantoaxial
![]()




SEO local Cirugía de urgencia (y III)
• Abordaje del politraumatismo en gatos
• Manejo anestésico en una gata sometida a craneotomía
• Displasia de cadera
• Tratamiento quirúrgico de la subluxación atlantoaxial




5
La OCV impulsa el proyecto de especialización en veterinaria con el apoyo de diversos agentes del sector


10
Atrae más clientes a tu clínica veterinaria con el SEO local

“Organizar la profesión de acuerdo con un baremo de conocimiento y competencias solo puede ser beneficioso para todos” Entrevista a Antonio Cruz (AVEDE) 4
La OCV impulsa el proyecto de especialización en veterinaria con el apoyo de diversos agentes del sector 5
Saludables y deliciosos: así son los nuevos snacks dentales y funcionales de Farmina, un mimo saludable para la sonrisa de tu perro Entrevista a Raquel Baeza (Farmina) 6
16 EN PORTADA
Traumatogía y neurología

38 Complicaciones quirúrgicas en cirugía de urgencia (y III): tórax y abdomen

EN PORTADA / PRÓXIMOS NÚMEROS
• Gestión y marketing
• Traumatología y neurología
• Cardiología
• Patología de la piel y el oído
• Anestesia
Si desea publicar un artículo sobre estos u otros temas, escríbanos a argos@grupoasis. com
“Nuestro equipo de I+D trabaja día a día para mejorar la calidad de los ingredientes, la adecuación nutricional y la apetencia de nuestros productos” Entrevista a Rosanna Cabré (Cotécnica) 8

Atrae más clientes a tu clínica veterinaria con el SEO local 10
Abordaje del politraumatismo en gatos
16
Anestesia total intravenosa con alfaxalona como parte del manejo anestésico en una gata sometida a craneotomía supratemporal para exéresis de un meningioma 20
Displasia de cadera (I): etiopatogenia, signos clínicos y pruebas diagnósticas 26
Tratamiento quirúrgico de la subluxación atlantoaxial 30
FORMACIÓN CONTINUA
Complicaciones quirúrgicas en cirugía de urgencia (y III): tórax y abdomen
Hemangiosarcoma esplénico en el perro (I): caso clínico, investigación y algunas nuevas terapias
Obtención y criopreservación de espermatozoides epididimarios caninos 48
SECCIÓN DIAGNÓSTICA / Diagnóstico de la leishmaniosis canina: estrategias eficaces en la práctica veterinaria
HABLANDO DE NUTRICIÓN CLÍNICA / Manejo nutricional de la insuficiencia pancreática exocrina en perro y gato
SECCIONES
Noticias
Síguenos en nuestras redes sociales: https://www.facebook.com/RevistaArgos

La categorización profesional que hizo pública la OCV el mes pasado no es el final del camino: es solo el primer paso. Para que sea efectiva la escala profesional, diseñada por esta entidad junto con diversos agentes del sector, el Ministerio de Sanidad tiene que estar dispuesto a atendernos (en concreto, a la OCV, que es el interlocutor válido para ello), aceptar la propuesta y hacerla oficial, con su correspondiente publicación en el BOE. Y hasta que llegue ese día, si llega, pueden pasar años. Que dependamos de un factor externo al sector, es decir, del Ministerio, limita la posibilidad de seguir dando pasos y de que estos se den con agilidad. Pero el primero ya está dado y, en teoría, hemos allanado el camino (le estamos dando la escala hecha al Ministerio) y ahora “solo” podemos esperar. O desesperar. Por si hay algún lector despistado al respecto, en este número incluimos un breve resumen del acto organizado por la OCV para presentar el proyecto de especialización y, también, una entrevista a Antonio Cruz, presidente de AVEDE (Asociación de Veterinarios Especialistas Diplomados de España), que ha participado en su desarrollo y expone su opinión sobre lo que esta categorización profesional puede suponer para el sector, así como para la sociedad. Este tipo de categorizaciones profesionales está instaurado en otros lugares del mundo y en diversos sectores. Vamos, que ni siquiera hay que inventar la rueda, aunque es comprensible cierta incertidumbre en esta etapa inicial.
Por otro lado, si alguien se está preguntando si cambiará de alguna manera la realidad del clínico veterinario generalista a corto plazo tras la presentación del proyecto, supongo que la respuesta es: “no, en nada”. Ahora se trata, en mi opinión, de entender la propuesta, de formarse una opinión propia y de asumir que quizá se ha iniciado un cambio.
“El pesimista se queja del viento; el optimista espera que cambie; el realista ajusta las velas”, decía el escritor William George Ward. O, lo que es lo mismo: de cada uno depende cómo hacer frente a la incertidumbre aunque, en mi opinión, como en casi todo en la vida, ajustar velas suele ser la respuesta más práctica.
Sheila Riera Forteza Veterinaria y socióloga Medios de Comunicación s.riera@grupoasis.com

“Organizar
conocimiento
El presidente de la Asociación de Veterinarios Especialistas Diplomados de España (AVEDE), Antonio Cruz, comenta lo aspectos más destacados de la nueva escala formativa veterinaria que acaba de aprobarse.

LV, MVM, MSc, PhD, MRCVS, DACVS, DECVS, DACVSMR Presidente de AVEDE
¿Qué importancia tiene esta nueva escala formativa veterinaria? ¿Cómo cree que impactará en el desarrollo de la profesión en España?
El desarrollo de la escala profesional ligada a una formativa creo que va a ser transformadora para nuestra profesión en España. Por primera vez en nuestra historia se organiza la profesión de acuerdo con unos baremos en los que prima el conocimiento y la competencia, lo que clarifica para el profesional y el público nuestras habilidades. Además, también proporciona al profesional veterinario una forma de progreso que irá ligada necesariamente a un reconocimiento en el ámbito laboral. Esto generará una demanda formativa que debería de facilitar la entrada de diplomados en los claustros académicos en el rango que nos merecemos por reconocimiento dentro del máximo nivel, que es el nivel
“Ahora la profesión queda estructurada en tres niveles: veterinario generalista, Certificado (por especies) OCV y Diplomado (por disciplina) OCV”.
8, del European Training Framework. Así mismo, espero que esta escala profesional facilite nuestro diálogo con el Ministerio de Sanidad, porque no hay que olvidar que como profesión sanitaria dependemos últimamente de él para realizar una ordenación profesional que pase por el BOE. Y, por último, si la sabemos usar mejorará sin duda nuestro prestigio y cohesión profesional.
La escala cuenta con tres niveles. ¿En qué consiste cada uno de ellos, y qué diferencias clave existen entre ellos?
Se establecen niveles básico, intermedio y superior. Se han organizado programas formativos rigurosos en el nivel intermedio, denominados Certificados OCV (Organización Colegial Veterinaria), que es una titulación intermedia por especies y reconoce, por ejemplo, también a los ya acreditados de AVEPA o el previo Certificado Español en Clínica Equina. El veterinario graduado tendrá la oportunidad de formarse a través de un programa educacional diseñado para compatibilizar la actividad laboral y reconocido por VetCEE a nivel europeo, y así obtener el Certificado OCV por especies, lo que le posicionaría en el mercado en una escala intermedia para seguir a una superior si así lo desea, aunque no sea estrictamente necesario. Finalmente, en un
tes ámbitos de la profesión y del cual he formado parte por mi experiencia previa, en el que hemos trabajado todos para que este proyecto fructifique. La voluntad de diálogo entre todos es de muy agradecer.
Esta nueva organización supondrá un beneficio para la profesión, pero ¿también conllevará beneficios para la sociedad en general?
Sin duda. Organizar una profesión de acuerdo con un baremo de conocimiento y competencias solo puede ser beneficioso para todos, para nuestro prestigio, para que el consumidor pueda elegir de forma educada y sencilla y finalmente para que el paciente se beneficie de todo ello. Es importante decir que las diferentes escalas se complementan entre sí y todas son necesarias en el equipo de atención sanitaria de un paciente.
“La escala proporciona al profesional veterinario una forma de progreso que irá ligada necesariamente a un reconocimiento en el ámbito laboral”.
nivel superior se establece una titulación de competencias por disciplina (cirugía, anestesia, medicina Interna, etc.) y a la que se accede siendo Diplomado Especialista Europeo, Americano o Británico (RCVS), consolidando y reconociendo así la figura del veterinario formado al máximo nivel, y que se denominará Diplomado OCV en la disciplina correspondiente, por ser esta una escala nacional. Es decir, la profesión queda estructurada como veterinario generalista, Certificado (por especies) OCV y Diplomado (por disciplina) OCV. Por poner ejemplos, habrá un Certificado OCV en pequeños animales, o un Diplomado OCV en neurología veterinaria.
¿Cuánto tiempo llevaba fraguándose este logro, y qué partes y organizaciones de la profesión veterinaria se han visto implicadas? Era un asunto pendiente digamos que de forma perenne. Organizar una profesión es inherente a su propia existencia, y no organizarla es negligente, en mi opinión. El anterior presidente de la OCV no fue capaz en 18 años de sentar a todas las partes y gestar un diálogo que el actual presidente sí ha hecho en dos. Ha habido muchas partes implicadas y las negociaciones han sido complejas, por lo que se ha necesitado voluntad, coraje y diálogo entre todos. Pero ya era hora. Puedo decir que para mí a nivel personal es un objetivo cumplido en el que me impliqué desde mi regreso a España. Es necesario mencionar que la OCV creó un Comité de Desarrollos con 11 miembros ad hoc de diferen-
¿Considera que va a haber problemas o dificultades a la hora de implementar la nueva escala formativa?
Eso ya dependerá de nuestra madurez como profesión. La herramienta se ha creado y las universidades se han mostrado dispuestas a colaborar mediante la organización de los programas formativos bajo los baremos establecidos por la OCV y su control. Ahora falta que sepamos ver la profesión con profesionalidad, valga la redundancia. Como reza el dicho, puedes llevar un caballo a la balsa pero no le puedes hacer beber. Para mí, el foco debe ser
“En España hay muy buen nivel de veterinaria clínica y hay que darle su espacio y la importancia que merece. Esta escala lo hace, y fomenta su crecimiento”.
no ahora sino como vemos la profesión en 15 o 20 años. En España hay muy buen nivel de veterinaria clínica y hay que darle su espacio y la importancia que merece. Esta escala hace eso y fomenta su crecimiento. De este modo nos unimos a un grupo selecto de países que gozan de una organización profesional similar, y sin duda somos un ejemplo para otros países de la Unión Europea.
AVEDE llevaba tiempo luchando por esta categorización. ¿Cómo han acogido sus socios su puesta en marcha? De forma extraordinaria, como no podría ser de otra forma. Entiendo que habrá compañeros escépticos de todo esto, pero eso es parte inherente al cambio. No puedes esperar tener un 100 % de aceptación, siempre cuesta un poco. Por ello hay que tener paciencia, espíritu colaborativo y solidario. Esto es el comienzo y probablemente no sea perfecto, pero solo puede mejorar. Era importante no retrasar más este cambio. Es como cualquier producto: el mercado lo mejora. Si esperas a que sea perfecto, nunca sale.
Miguel Ángel Ordovás Argos – argos@grupoasis.com

La escala profesional constará de tres niveles: diplomados OCV (máximo), certificados OCV (intermedio) y graduados/licenciados (básico).
Diplomados OCV (máximo)
La Organización Colegial Veterinaria (OCV) presentó el pasado 18 de septiembre el proyecto de especialización veterinaria. Luis Alberto Calvo, presidente de la OCV, considera fundamental la ordenación profesional mediante títulos reconocidos oficialmente. “Estamos creando un sistema que proyecta todo el trabajo de la especialización más allá de la propia acreditación, apostando por la formación continuada como uno de los pilares fundamentales en el posgrado, lo que permitirá la adaptación del sistema a las circunstancias de las ciencias veterinarias en cada uno de los momentos”, afirmó Calvo.
Escala profesional
Han quedado establecidos tres niveles: diplomados OCV, certificados OCV y graduados/licenciados.
La OCV reconoce a los Diplomados Europeos, Americanos y RCVS como máximo nivel de la escala profesional.
Certificados OCV (intermedio)
Certificados con aval VET CEE
Posee doble valor académico –equivale a un posgrado de 46 créditos- y profesional. El aprendizaje será online, con 30 créditos teóricos y uno sobre deontología colegiales, a los que se suman 15 de tipo práctico, en talleres, de manera presencial. Para garantizar la calidad de la enseñanza, la ratio no superará los 25 alumnos por profesor. Además de una división por especies, contempla los certificados en salud pública, seguridad alimentaria y peritaje. La reacreditación se efectuará cada cinco años ante la propia OCV.
Certificados sin aval VET CEE
Tiene un reconocimiento exclusivamente profesional y presenta como prin-
cipal novedad el Certificado OCV en Pequeños Animales, iniciado en su día por AVEPA. El existente hasta la fecha en équidos, realizado entre los años 2019 y 2022 por esta Organización, queda cerrado. Se articula por áreas (oftalmología, dermatología, etc.), estará abierto de manera permanente y lo gestionará AVEPA con el respaldo de la OCV. Se exigirá una experiencia mínima de cuatro años con animales de este tipo y estar colegiados. La obtención del certificado también incluirá aspectos deontológicos y de estatutos. La reacreditación será efectuada por AVEPA cada 5 años, con la intervención de la OCV.
Graduados/licenciados Es el nivel básico.
Modelo preexistente
Abel Anguera, director del proyecto de especialización, señaló que este modelo es muy semejante al de otras profesiones no

necesariamente sanitarias, así como al de la profesión veterinaria en otros países, sobre todo en lo concerniente a la formación permanente y a la reacreditación. El marco normativo para desarrollar estos títulos propios está recogido en el RD 822/2021 de Organización de las Enseñanzas Universitarias. También se ha consultado la Ley 44/2003 de Ordenación de las Profesiones Sanitarias, que atañe en especial a los Certificados con aval VET CEE.
Consuelo Serres, presidenta de la Conferencia de Decanos de Veterinaria, destacó que esta formación cuenta con el reconocimiento de la Universidad, “para lograr por fin estratificar la profesión” y que “el sello VET CEE representa una garantía de calidad y de continuidad”.



¿Quieres colaborar con nosotros?


Si quieres enviarnos un caso clínico, publicar un artículo de revisión o difundir otra información relevante para nuestros lectores de carácter independiente, no vinculada a marcas comerciales, escríbemos a argos@grupoasis.com y te informaremos. ¡Te esperamos!


Cada uno de los nuevos snacks Farmina tiene una función específica, además de cuidar la higiene bucodental canina.

¿Cuáles son las principales ventajas de los snacks Farmina?
Farmina tiene un enfoque integral en el bienestar animal, y este bienestar no se limita a la alimentación, sino que también incluye otros aspectos de la salud física y emocional.
La acción de dar un snack como premio a tu mascota refuerza el vínculo con ella. Además, también se utilizan para educarla y modificar conductas no deseadas.
En lo que a nutrición se refiere, Farmina utiliza ingredientes naturales, sin conservantes ni colorantes artificiales. Los Snacks Farmina están formulados con carnes de alta calidad, frutas y verduras, lo que asegura una fuente nutricional sana para las mascotas. Son altamente nutritivos, ya que están enriquecidos con nutrientes esenciales como vitaminas y minerales, proporcionando beneficios nutricionales además del disfrute. Además, algunos están elaborados sin cereales, lo que los hace ideales para mascotas con alergias o sensibilidades alimentarias. Farmina ofrece snacks funcionales, que se adaptan a las necesidades específicas

de salud de la mascota, como el control de peso, el mantenimiento de la piel y el pelaje o el apoyo digestivo. Además, ofrece sus snacks de la gama veterinaria VETLIFE, que hace posible premiar a la mascota con un snack sin interferir con la nutrición clínica que están siguiendo.
¿Qué beneficios aportan?
Los nuevos snacks Farmina cumplen una doble función: un snack saludable que además ofrece un cuidado dental. Por ello, nuestro eslogan es “un mimo saludable para la sonrisa de tu perro”. Para sacarle el mayor partido al snack, debería ser utilizado como complemento al alimento que ya consume la mascota. Si, por ejemplo, come N&D Quinoa Digestion, que se utilice el mismo snack de la misma línea. El paquete contiene 7 palitos, uno para cada día de la semana, y es aconsejable dar el snack a la mascota entre comidas. De todos modos, por si hubiera alguna duda en caso de elegir el Snack más adecuado a cada mascota, ofrecemos Consultoría Nutricional, un servicio totalmente gratuito para resolver cualquier tipo de duda al respecto.
Gastrointestinal: de fácil digestión, con alcachofa para el apoyo gastrointestinal e hinojo, que tiene propiedades antibacterianas.
Hypoallergenic: monoproteicos con arenque o cerdo, enriquecidos con ácidos grasos omega-3 y fibra para reducir el riesgo de reacciones alimentarias adversas y favorecer un sistema digestivo sano.
Struvite: bajo en grasa con acidificantes de la orina para controlar el pH urinario, minimizando la formación de urolitos de estruvita.
Renal: bajo en fósforo y sodio para frenar la progresión de la enfermedad renal.
Joint: repleto de ácidos grasos omega-3, condroitina y glucosamina para una salud óptima de las articulaciones.
Obesity: bajo en calorías con colina, L-carnitina y espirulina, perfectos para un programa de pérdida de peso sin sacrificar el sabor.
son snacks de doble función, ya que pro mueven la salud bucal del perro a la vez que ofrecen otros beneficios. Esta gama consta de:
• N&D Quinoa Digestion, para mejorar la digestión, a base de hinojo, con acción antibacteriana, y fructooligosacáridos, con acción prebiótica.
• N&D Quinoa Skin& Coat, que es monoproteico y rico en omega-3.
“Los snacks Farmina tienen una forma de estrella de 6 puntas y la textura perfecta que al masticar raspa suavemente los dientes, reduciendo la acumulación de bacterias”.
Los snacks Farmina son el complemento perfecto de sus líneas de producto, pero, ¿qué puede decirnos sobre su función en el cuidado dental?
Los snacks Farmina tienen una forma de estrella de 6 puntas y la textura perfecta que al masticar raspa suavemente los dientes, reduciendo la acumulación de bacterias. Mejoran el aliento, ya que ayudan a reducir la placa y el sarro. Mantener una buena higiene dental puede ayudar a prevenir enfermedades bucales graves, como la periodontitis, que puede afectar la salud general del perro. Las bacterias bucales pueden llegar al torrente sanguíneo y afectar a órganos importantes como el corazón, el hígado o los riñones.
¿Están diseñados para un tamaño de perro en concreto?
Tenemos dos tamaños de snacks, mini y medium-maxi. La fórmula es la misma, y lo que cambia simplemente es la longitud del snack
¿Qué destacaría de la línea de Snacks N&D Quinoa?
La quinoa no es un cereal, por lo que no contiene gluten. Tiene un bajo índice glucémico y es rica en nutrientes esenciales como proteínas, fibra, vitaminas y minerales. N&D Quinoa + Dental Care,

• N&D Quinoa Weight Management, el snack dental más ligero, ideal para el control de peso.
• N&D Quinoa Fresh Breath, con menta para un aliento fresco.
• N&D Quinoa Flatulence, con espirulina, que mejora el metabolismo, yucca, que ayuda a contrastar el mal olor, y fructooligosacáridos con acción prebiótica.
¿Qué efecto tienen los snacks N&D White y N&D Brown sobre el pelaje?
Los snacks N&D White están diseñados para ayudar a mantener y mejorar el pelaje claro o blanco de las mascotas, abordando problemas comunes como las manchas en los lagrimales o el amarilleo del pelaje. Además, contribuyen a mantener un pelaje suave y brillante, realzando el color natural del pelaje blanco.
Los snacks N&D Brown están formulados para nutrir y realzar el pelaje oscuro o marrón, ayudando a mantener su color y brillo natural, evitando la pérdida de pigmentación y mejorando el brillo.
¿En qué casos pueden utilizarse los snacks N&D Pumpkin y N&D Tropical?
Los snacks N&D Pumpkin son ricos en calabaza, que ofrece beneficios digestivos, nutricionales y generales para la salud de las mascotas, con un enfoque especial en
ingredientes naturales y la exclusión de cereales. Es ideal para mascotas con estómagos sensibles, alergias, o necesidades dietéticas especiales.
Los snacks N&D Tropical, elaborados con frutas tropicales, contienen antioxidantes que ayudan a fortalecer el sistema inmunológico, protegiendo al animal de enfermedades y promoviendo una buena salud general. N&D Tropical, aparte de tener una acción prebiótica, contiene glucosamina para fortalecer la mucosa de la vejiga.
¿Comprometen de alguna forma la dieta clínica que consume el paciente? Por supuesto que no. Los nuevos snacks VetLife cambian las reglas del juego a la hora de mimar a nuestras mascotas, ya que cada uno de ellos tiene una función específica, además de cuidar de su higiene bucodental. Los snacks VetLife están meticulosamente formulados para cumplir estrictos requisitos patológicos y garantizar una salud bucodental óptima.
A partir de ahora, los perros con afecciones médicas que necesiten una dieta clínica podrán recibir snacks que no solo se ajusten a sus necesidades dietéticas, sino que también contribuyan a su cuidado dental.

“Nuestro equipo de I+D trabaja día a día
Cotécnica ha optimizado la fórmula de su gama low grain Superpremium Ultra para maximizar su digestibilidad. También ha mejorado su proceso slow cooking, así como el envase de los productos, para mejorar la experiencia del tutor.

Acaban de relanzar su gama Superpremium Ultra. ¿Qué mejoras específicas se han introducido en la nueva formulación respecto a la versión anterior?
Hemos hecho pequeños retoques en la fórmula, siempre con el objetivo de maximizar la digestibilidad. Ownat Ultra es una gama low grain, elaborada única-
“Incluye un elevado porcentaje de carnes frescas de pollo, pavo y cordero, concretamente un 30 %, que aportan proteínas de alto valor biológico, de elevada digestibilidad, apetencia y sabor”.
mente con arroz y avena, siempre integrales. Hemos eliminado las habas para reducir flatulencias y, en el caso de las variedades Junior, también se han añadido proteínas hidrolizadas para facilitar la digestión y ácidos grasos de cadena corta y nucleótidos para mantener en buen estado la mucosa intestinal.
Además, hemos mejorado nuestro exclusivo proceso slow cooking, mediante el que cocemos los ingredientes al vapor para conseguir el punto exacto de cocción.
“La incorporación en nuestras recetas de avena y arroz en su versión integral (es decir, su grano completo) permite que se conserve intacto su contenido en vitaminas y minerales”.
¿Qué destacaría de su contenido en carne?
Incluye un elevado porcentaje de carnes frescas de pollo, pavo y cordero, concretamente un 30 %, que aportan proteínas de alto valor biológico, de elevada digestibilidad, apetencia y sabor.
¿Qué otros ingredientes naturales incluyen?
Como en Ownat estamos convencidos de que la base para la salud y el bienestar de los animales de compañía empieza con una alimentación de verdad, en nuestras recetas empleamos ingredientes natura-

les de calidad, frescos y con todo su valor nutritivo.
Aparte de la carne fresca y los cereales en proporciones reducidas, incluye tubérculos (patata y mandioca), legumbres (guisantes y algarroba), verduras y frutas frescas (manzana, zanahoria, brócoli, calabaza), huevo, prebióticos (raíces de achicoria), algas marinas, arándanos y plantas aromáticas (té verde, equinácea, flor de manzanilla e hinojo) que refuerzan el sistema inmunitario y mejoran el bienestar digestivo.
Sus productos son low grain. ¿Qué beneficios aporta el uso de arroz y avena integrales?
El arroz y la avena integrales destacan por su elevado aporte de fibra, beneficiosa para el buen funcionamiento del sistema digestivo. Además, la incorporación en nuestras recetas de dichos cereales en su versión integral (es decir, su grano completo) permite que se conserve intacto su contenido en vitaminas y minerales.
“La tecnología slow cooking se trata de un exclusivo proceso de cocción de los ingredientes al vapor que permite mantener al máximo el valor nutritivo original de los ingredientes y obtener alimentos de gran digestibilidad y sabor”.
¿En qué consiste su exclusivo proceso slow cooking?
La tecnología slow cooking se trata de un exclusivo proceso de cocción de los ingredientes de manera natural al vapor que permite mantener al máximo el valor nutritivo original de los ingredientes y obtener alimentos de gran digestibilidad y sabor.
El proceso empieza con la calidad en los ingredientes: seleccionamos solo los ingredientes más frescos y naturales con todo su valor nutritivo intacto. A continuación, los cocemos de forma natural al vapor y en lotes de producción limitados. Finalmente, formamos las croquetas del tamaño y forma adecuadas a cada variedad de animal y las envasamos con toda su frescura.
¿Qué cambios se han realizado en el diseño del packaging y cómo contribuyen estos cambios a mejorar la experiencia del cliente?
Para mejorar la experiencia del tutor, hemos incorporado cierres Aplix en nues-
tros envases, lo que optimiza la conservación del producto.
En cuanto a la exposición en el punto de venta, los envases pequeños ahora cuentan con un diseño Flat Bottom, que permite una presentación más atractiva y estable en las estanterías.
Respecto al diseño, hemos potenciado la elegancia del clásico color negro, manteniendo su sofisticación. Además, hemos reorganizado los conceptos clave de la gama y ajustado la proporción de las imágenes de los ingredientes, dando mayor protagonismo a la carne fresca, que ahora refleja mejor la esencia de nuestras recetas.
“Hemos incorporado cierres Aplix en nuestros envases, lo que optimiza la conservación del producto. En cuanto a la exposición en el punto de venta, los envases pequeños ahora cuentan con un diseño Flat Bottom, que permite una presentación más atractiva y estable en las estanterías”.
Revisan sus recetas constantemente. ¿Qué puede decirnos de su departamento de I+D?
Nuestro equipo de I+D trabaja día a día para mejorar la calidad de los ingredientes que incorporamos en las recetas, así como la adecuación nutricional y apetencia de nuestros productos. En paralelo, desde Cotécnica estamos trabajando para utilizar envases cada vez más sostenibles, fabricados con un solo tipo de material para facilitar su proceso de reciclaje. Ahora mismo estamos en fase de implementación y su puesta al mercado está planificada en el medio plazo.
En términos de sostenibilidad y proximidad, ¿cómo asegura Ownat la calidad y frescura de los ingredientes utilizados? Nuestra empresa, Cotécnica, es una cooperativa compuesta por 10 miembros que son, entre otros, productores de cereales, frutas, verduras y animales de abasto; por lo que nuestros socios son al mismo tiempo nuestros proveedores locales. Esta ventaja nos permite elaborar recetas con productos frescos y de proximidad, garantizando la calidad desde el origen y asegurando el suministro de la materia prima.
Sheila Riera Argos argos@grupoasis.com

El comportamiento del consumidor ha cambiado y la visibilidad online es ahora crucial para las empresas. El objetivo del SEO local es posicionar tu clínica veterinaria en los primeros lugares de los resultados que aparecen tras las búsquedas y, de esta forma, atraer más clientes potenciales.
Josep Vallès
SEO para Veterinarios Veterinario y Experto en SEO Local hola@josepvalles.es josepvalles.es
El SEO local es una estrategia de marketing digital que te permite optimizar la presencia online de tu clínica para que aparezca en los primeros resultados de búsqueda de Google cuando tus clientes potenciales te busquen en su zona.
¿Por qué es tan importante el SEO local para las clínicas veterinarias?
• Te diferencia de la competencia.
• Aumenta las visitas a tu web y las llamadas a tu clínica.
• Genera confianza y credibilidad.
En este artículo te explicaremos de qué se trata y cómo puedes utilizarlo para atraer más clientes a tu clínica veterinaria.
La visibilidad online de tu clínica veterinaria
Hace años, la visibilidad de una clínica veterinaria dependía de señales físicas: un letrero llamativo, un coche rotulado o un anuncio en la guía telefónica. Eran tiempos en los que las recomendaciones boca a boca eran clave (siguen siéndolo) y la reputación se construía principalmente a través de interacciones personales. Pero el mundo ha evolucionado y, con él, la forma en que las personas buscan servicios locales. ¿Recuerdas la última vez que buscaste un negocio? Lo más pro-
Si tu clínica no aparece en los resultados de búsqueda locales, te arriesgas a perder clientes potenciales que buscan servicios en tu zona.
bable es que hayas recurrido a internet para encontrar la mejor opción cerca de ti. Esto es lo que hacemos la mayoría de las personas hoy en día: confiar en internet para encontrar desde restaurantes hasta servicios médicos, incluidos los veterinarios.
Este cambio en el comportamiento del consumidor ha convertido la visibilidad online en un factor crucial para las clínicas veterinarias. Y si tu clínica no aparece en los resultados de búsqueda locales, te arriesgas a perder clientes potenciales que buscan tus servicios en tu zona (figura 1).
El 88 % de los consumidores confían en las reseñas online tanto como en las recomendaciones personales (Fuente: BrightLocal).
Las estadísticas no mienten: el comportamiento del consumidor ha cambiado y la visibilidad online es ahora crucial para las empresas locales:
• El 46 % de todas las búsquedas de Google son para buscar negocios locales (Fuente: HubSpot).
• Más del 90 % de las personas utilizan internet para encontrar empresas locales (Fuentes: Search Engine Journal, BrightLocal).
• Las búsquedas de “cerca de mí” han aumentado en más del 900 % en los últimos dos años (Fuente: Chatmeter).
• El 88 % de los consumidores confían en las reseñas online tanto como en las recomendaciones personales (Fuente: BrightLocal).
• El 78 % de las búsquedas locales desde el móvil terminan comprando en el negocio físico dentro de las 24 horas siguientes (Fuente: SEO Tribunal).


locales.
¿Qué son las búsquedas locales?
Las búsquedas locales son las consultas que se realizan en internet (mayoritariamente a través del buscador de Google) para encontrar información sobre empresas o servicios en una ubicación específica.
En el caso de los servicios veterinarios, las búsquedas más frecuentes incluyen términos como “veterinario”, “veterinario cerca de mí” o “veterinario + ciudad”.
los tres primeros resultados que aparecen en Google Maps para búsquedas locales. Muestran la ubicación, información de contacto y ficha de Google Business Profile (GBP) de las empresas. Da la opción de mostrar más resultados.
• Resultados orgánicos: enlaces a páginas web que aparecen debajo del Local Pack y los anuncios. Optimizar tu sitio web para el SEO local puede aumentar tu visibilidad en estos resultados. Para desarrollar una estrategia efectiva de SEO local es necesario entender la
Cuando alguien realiza una búsqueda como “veterinario cerca de mí”, Google comprende que esa persona está buscando atención veterinaria inmediata y está listo para mostrar los resultados más relevantes en función de su ubicación.
La importancia de las búsquedas locales radica en la intención del usuario. Y aquí es donde entra en juego el concepto de “intención de búsqueda” de Google. Cuando alguien realiza una búsqueda como “veterinario cerca de mí”, Google comprende que esa persona está buscando atención veterinaria inmediata y está listo para mostrar los resultados más relevantes en función de su ubicación (figura 2).
El objetivo del SEO local es posicionar tu clínica veterinaria en los primeros lugares de los resultados que aparecen tras estas búsquedas y, de esta forma, atraer más clientes potenciales.
Los resultados locales
Hay varios tipos de resultados que Google nos puede mostrar en respuesta a estas búsquedas locales (figura 3):
• Publicidad (Google Ads): anuncios que aparecen en la parte superior de la página y están marcados como “Anuncio” o “Patrocinado”. Ofrecen visibilidad inmediata, pero requieren inversión. No siempre aparecen.
• Local Pack: es un elemento crucial para las búsquedas locales. Corresponde a
diferencia entre estos tipos de resultados, pero también hay que tener en cuenta que los resultados a esas búsquedas se adaptan a la ubicación del usuario. Es decir, la misma búsqueda puede mostrar distintos resultados si se realiza en distintos puntos, a veces no muy lejanos entre sí. Lo veremos con más detalle al hablar de RankMap (una herramienta muy utilizada en SEO local).
Por tanto, una clínica veterinaria puede aparecer en los resultados locales de Google de tres maneras diferentes:
• Como anuncio (en Google Ads).
• Dentro del Local Pack (realmente aparecerá su ficha de empresa -también llamada ficha de Google Business Profile (GBP)- con su ubicación, reseñas, información de contacto, etc.).
• Dentro de los resultados orgánicos (un enlace a la web de la clínica). Es posible que una clínica veterinaria aparezca en las tres categorías al mismo tiempo.
La web y la ficha de empresa
La web y la ficha de Google Business Profile (GBP) son los dos pilares fundamentales de la presencia y visibilidad




online. Ambos trabajan en conjunto y se potencian entre sí.
La web: tu carta de presentación digital
Tu sitio web, además de informar a los usuarios de tus servicios, equipo, horarios, etc., es imprescindible para aparecer en los resultados orgánicos de búsqueda.
Una web bien diseñada y optimizada para el SEO local puede aparecer en las primeras posiciones de los resultados orgánicos y, por tanto, ayudarte a destacar entre la competencia y atraer más tráfico cualificado a tu sitio.
usuarios buscan en tu área geográfica y que se relacionan con tus servicios veterinarios. Integra estas palabras clave de forma natural y relevante en el contenido de tu sitio web, incluyendo títulos, metadescripciones, textos y URL.
• Optimización de la estructura y el contenido: asegúrate de que tu sitio web sea fácil de navegar y que el contenido esté bien organizado. Incluye información detallada sobre tus servicios, horarios de atención, ubicación y testimonios de clientes satisfechos. Asegúrate de que tu sitio web sea responsive y se adapte a dispositivos móviles.
La web y la ficha de Google Business Profile (GBP) son los dos pilares fundamentales de la presencia y visibilidad online Ambos trabajan en conjunto y se potencian entre sí.
La ficha de empresa en GBP: tu entrada al Local Pack
La ficha de empresa en GBP, antes conocida como Google My Business (GMB), es tu puerta de entrada al Local Pack de Google. Esta ficha muestra información crucial sobre tu clínica veterinaria, como tu dirección, tu número de teléfono, tus horarios de atención y las reseñas de clientes satisfechos.
Su optimización permite asegurarte de que aparezca en el Local Pack cuando los usuarios realicen búsquedas locales relevantes.
Optimización básica
Ya hemos mencionado que la optimización de la web y de la ficha de Google Business Profile (GBP) es fundamental para mejorar el posicionamiento en los resultados de búsquedas locales. Veamos algunas estrategias clave para optimizarlas.
Optimización de la web
• Investigación de palabras clave locales: identifica las palabras clave que los
• Creación de contenido de calidad: publica regularmente contenido relevante y útil en tu blog o sección de noticias. El contenido de calidad no solo mejora la experiencia del usuario, sino que también puede ayudarte a posi-
cionarte en los resultados de búsqueda orgánica.
• Optimización de los metadatos: asegúrate de que los títulos, las descripciones y las etiquetas alt de las imágenes estén optimizados con palabras clave relevantes. Estos metadatos ayudan a Google a comprender el contenido de tu sitio web y a mostrarlo en los resultados de búsqueda para las consultas relevantes.
• Registra tu web en directorios locales y crea enlaces de retroceso (backlinks): esto puede ayudar a mejorar tu autoridad online y tu visibilidad en los resultados de búsqueda locales.
• Solicita y responde a reseñas: anima a tus clientes satisfechos a dejar reseñas positivas en tu ficha de empresa en GBP. Además, asegúrate de responder a todas las reseñas, tanto positivas como negativas, de manera profesional y cortés. Las reseñas son un factor importante para el posicionamiento en el Local Pack. Implementar estas estrategias de optimización en tu web y tu ficha de GBP te ayudará a:
• Mejorar tu visibilidad en los resultados de búsqueda locales.
• Atraer más tráfico a tu sitio web.
• Convertir visitantes en clientes potenciales.
• Fortalecer tu posición en el mercado local.
Google da prioridad a las empresas que ofrecen información completa, precisa y relevante, por lo que asegurarte de que tanto tu web como tu ficha estén bien optimizadas puede marcar la diferencia entre ser encontrado por potenciales clientes o ser ignorado en la vastedad del internet.
Auditoría web y RankMap
Antes de iniciar cualquier estrategia de optimización, es vital realizar una evaluación profunda de tu sitio web y tu ficha de Google Business Profile (GBP). Aquí es donde entran en juego la auditoría web y
Registra tu web en directorios locales y crea enlaces de retroceso (backlinks): esto puede ayudar a mejorar tu autoridad online y tu visibilidad en los resultados de búsqueda locales.
Optimización de la ficha de empresa en GBP:
• Completa toda la información: proporciona información detallada y precisa sobre tu clínica veterinaria, incluyendo el nombre, dirección, teléfono, horario de atención, descripción de tus servicios, categorías relevantes, sitio web, fotos.
• Verifica y reclama tu ficha: verifica y reclama tu ficha de empresa en GBP para asegurarte de que tengas control sobre la información que se muestra y para acceder a herramientas adicionales. Google te guiará a través del proceso de verificación.
• Agrega fotos de alta calidad: agrega fotos de alta calidad de tu clínica, tu equipo y tus servicios. Las imágenes atractivas pueden aumentar la confianza de los usuarios y mejorar la visibilidad de tu ficha en los resultados de búsqueda.

el RankMap (o geogrid), dos herramientas esenciales para:
• Comprender el estado actual de tu presencia online
• Identificar áreas de mejora y oportunidades de optimización.
• Establecer una base sólida para tu estrategia de SEO Local.
Auditoría del sitio web: radiografía digital de tu clínica veterinaria Una auditoría del sitio web es como una revisión exhaustiva de la salud digital de tu clínica veterinaria. Se analizan diversos aspectos técnicos, de contenido y de rendimiento para identificar áreas de mejora y oportunidades de optimización. Los principales aspectos para evaluar incluyen:
• Análisis de SEO on-page: se examinan elementos como los metadatos, la estructura del sitio, la velocidad de carga y la optimización de imágenes.

• Revisión del contenido: se evalúa la calidad, la relevancia y la originalidad del contenido en todas las páginas del sitio.
• Comprobación de enlaces: se analizan los enlaces internos y externos para garantizar una estructura de enlace saludable y relevante.
• Optimización para dispositivos móviles: se verifica si el sitio web es compatible con dispositivos móviles y si ofrece una experiencia de usuario óptima en todos los dispositivos.
RankMap (o geogrid) de la ficha de empresa en GBP: visualiza tu presencia en Google Maps
El RankMap te permite visualizar la presencia de tu ficha de empresa en Google Maps en diferentes ubicaciones geográficas (figuras 4 y 5). Te muestra cómo se clasifica tu ficha en cada área y te ayuda a identificar áreas de oportunidad para mejorar tu visibilidad local.
Con el RankMap, puedes:
• Identificar áreas con baja visibilidad: descubre las áreas geográficas donde tu ficha de empresa no está siendo tan visible como debería y toma medidas para mejorar tu presencia en esas áreas.
• Comparar con la competencia: compara tu posicionamiento con el de tus competidores en diferentes ubicaciones y encuentra oportunidades para destacar.
• Optimizar la información de tu ficha: ajusta la información de tu ficha, como la descripción, las categorías y las fotos, para mejorar tu clasificación en las áreas donde deseas tener más visibilidad.
La combinación de la auditoría web y el RankMap te proporciona una visión completa de tu presencia online. Esta información te permite:
• Desarrollar estrategias de SEO Local personalizadas y efectivas.
• Mejorar tu posicionamiento en los resultados de búsqueda locales.
• Atraer más clientes potenciales a tu clínica veterinaria.
• Monitorizar tu progreso y el impacto de tus estrategias.
• Ajustar tu enfoque según sea necesario para optimizar tu visibilidad local.
Anima a tus clientes satisfechos a dejar reseñas positivas en tu ficha de empresa en GBP. Además, asegúrate de responder a todas las reseñas, tanto positivas como negativas, de manera profesional y cortés.
Beneficios del SEO Local para clínicas veterinarias
El SEO Local ofrece una serie de ventajas significativas para las clínicas veterinarias que desean destacar en su área de servicio y atraer más clientes. Aquí están algunos de los principales beneficios:
• Mayor visibilidad: al optimizar tu presencia en línea para búsquedas locales, tu clínica veterinaria estará más visible para las personas que buscan servicios veterinarios en tu área. Esto aumenta las probabilidades de que los usuarios encuentren y elijan tu clínica sobre la competencia.
• Atracción de clientes cualificados: al aparecer en los resultados de búsqueda locales, tu clínica será descubierta por
aquellos que están buscando específicamente servicios veterinarios en tu área geográfica. Estos usuarios son clientes potenciales altamente cualificados que tienen una alta probabilidad de convertirse en clientes reales.
• Mayor tráfico a tu sitio web y a tu clínica: con una sólida estrategia de SEO local, aumentarás el tráfico a tu sitio web y a tu clínica. Esto puede traducirse en más citas, más consultas y, en última instancia, en un aumento en tus ingresos.
• Fortalecimiento de la reputación y la autoridad: una presencia fuerte en línea,
respaldada por reseñas positivas y una clasificación alta en los resultados de búsqueda, ayuda a fortalecer la reputación y la autoridad de tu clínica veterinaria en tu comunidad.
• Costo-efectividad: en comparación con la publicidad tradicional, el SEO local suele ser más rentable a largo plazo. Una vez que has optimizado tu presencia en línea, puedes seguir atrayendo clientes de forma orgánica sin necesidad de invertir grandes sumas en publicidad continua.
• Fidelización de clientes: al ofrecer una experiencia positiva tanto en línea
como fuera de línea, puedes fidelizar a tus clientes y convertirlos en defensores de tu marca. Esto puede generar recomendaciones boca a boca y ayudar a impulsar el crecimiento de tu clínica a largo plazo. En resumen, el SEO local es una herramienta poderosa que permite a las clínicas veterinarias aumentar su visibilidad online, atraer clientes cualificados y fortalecer su reputación en el área de servicio. Se trata de un proceso continuo que requiere atención constante, pero los resultados a largo plazo justifican el esfuerzo invertido.

Marta Lázaro. Veterinary Manager. Farmina Pet Foods España

Marta Lázaro, Veterinary Manager de Farmina Pet Foods España, es la responsable de canal veterinario de la compañía italiana líder en nutrición de perros y gatos. Marta se encarga de traernos la información más reciente sobre el lanzamiento de Intestinal Ultracare Low Fat, que se incorpora a la gama de dietas veterinarias VetLife especificamente diseñado para el tratamiento de enteropatías crónicas en perros. El desarrollo de esta dieta innovadora se ha llevado a cabo en paralelo con el reconocido y prestigioso especialista Dr. Kenneth Simpson, Dip. ACVIM y ECVIM de Cornell University, en Nueva York, EEUU. Basado en un estudio científico del que ahora hablaremos, propone opciones nutricionales prometedoras para el tratamiento de enteropatías crónicas en el perro.
La Enteropatía Crónica (EC) es un problema complejo en medicina veterinaria que recoge diversos trastornos inflamatorios crónicos que afectan el tracto gastrointestinal en perros. La EC se caracteriza por síntomas gastrointestinales persistentes que duran más de tres semanas. El diagnóstico de EC requiere un enfoque exhaustivo con una historia detallada, examen físico, análisis de sangre, evaluaciones de cortisol, urianálisis, exámenes fecales y niveles séricos de vitaminas. Para complementar, se utilizan métodos de diagnóstico más avanzados como ecografía abdominal, endoscopia biopsia intestinal y TLI (tripsina inmunorreactiva).
Un subconjunto clave de la EC es la Enteropatía Perdedora de Proteínas (PLE), marcada por bajos niveles de albúmina sérica, que
Las modificaciones dietéticas normalizaron los niveles séricos de cobalamina y folato, con dietas de ingredientes limitados que contienen pescado hidrolizado y aceite de pescado, siendo una promesa para casos de PLE.
requiere un tratamiento más específico, incluidos medicamentos. Los perros con EC a menudo sufren malabsorción de vitaminas esenciales como B12, B9 y D, por tanto, es fundamental un correcto manejo nutricional.
Las dietas especializadas, particularmente aquellas con antígenos novedosos o proteínas hidrolizadas, han inducido remisión en el 60% al 88% de los perros con EC y niveles normales de albúmina sérica. Esto sugiere que la restricción de ingredientes puede ser más crítica que el enfoque en antígenos inmunogénicos específicos.
Este estudio es el primero en demostrar que la intervención dietética por sí sola puede mantener los niveles de vitaminas séricas sin suplementación adicional.
El Hospital for Animals de Cornell University realizó un estudio exhaustivo para evaluar la eficacia de diferentes dietas en el manejo de EC no perdedora de proteínas (no-PLE) y PLE en perros. En el estudio participaron perros de clientes con EC. Los propietarios proporcionaron comentarios semanales durante 12 semanas, seguidos de un seguimiento a largo plazo de 26 semanas. Se probaron tres dietas: control, HF (hydrolyzed fish) y HF+. Las dietas HF y HF+ incluían pescado hidrolizado, almidón de arroz y aceite de pescado; HF+ también contenía prebióticos, cúrcuma y niveles más altos de vitamina B12. La dieta control incluía pollo y pescado no hidrolizados, maíz, arroz, grasa de pollo y aceite de pescado.
En este ensayo clínico doble ciego y controlado aleatoriamente, los perros recibieron una de las tres dietas durante 2 semanas. Los que respondieron continuaron con la misma dieta durante 12 semanas, mientras que los que no respondieron cambiaron de dieta durante el mismo período. Se evaluaron las respuestas clínicas, con seguimiento a las 26 semanas. Se permitieron medicamentos para los perros con PLE.
Los parámetros clave incluyeron el Índice de Actividad Clínica de Enteropatía Crónica Canina (CCECAI), puntuación fecal, cobalamina sérica y folato sérico. En el grupo no-PLE de 23 perros, los participantes se dividieron entre dieta control (7 perros), HF (7 perros) y HF+ (9 perros). Después de 2 semanas, 19 de 23 perros presentaron mejoría clínica, con una tasa de éxito del 83% a las 12 semanas. Cuatro perros recidivaron, pero lograron remisión a las 12 semanas después de cambiar de dieta. Dieciocho de los 23 perros estaban disponibles para el seguimiento a las 26 semanas, todos manteniendo la remisión. Cinco perros se perdieron en el seguimiento.
En el grupo PLE de seis perros (cinco en HF y uno en HF+), todos completaron el ensayo de 12 semanas con sus dietas iniciales. Simi-
Te presentamos a Argos: antes y después de un ensayo dietético de 6 semanas de duración con Intestinal UltraCare Low Fat.


lar al grupo no-PLE, las evaluaciones se basaron en mejoría clínica pasadas 2 semanas. Dos perros en HF+ recidivaron a las 6 semanas y cambiaron a HF, uno logró la remisión y el otro se retiró por inapetencia. Los siete perros con PLE permanecieron en remisión al seguimiento a las 26 semanas.
Estos resultados destacan la eficacia de las intervenciones dietéticas para lograr remisión a largo plazo en EC no-PLE. Las modificaciones dietéticas normalizaron los niveles séricos de cobalamina y folato, con dietas de ingredientes limitados que contienen pescado hidrolizado y aceite de pescado, siendo una promesa para casos de PLE.
El análisis sérico a las 12 semanas mostró niveles aumentados de cobalamina en todos los grupos de dieta. Después de una disminución inicial en el folato sérico a las 6 semanas, las dietas reformuladas con niveles más altos de folato mantuvieron niveles normales de folato en perros con y sin PLE. Este estudio es el primero en demostrar que la intervención dietética por sí sola puede mantener los niveles de vitaminas séricas sin suplementación adicional.
Como conclusión, este estudio demuestra que la remisión clínica a largo plazo puede lograrse en perros con EC mediante dietas de ingredientes limitados, cuyo éxito está vinculado a la restricción de ingredientes más que a objetivos inmunogénicos específicos. Las modificaciones dietéticas normalizan eficazmente las concentraciones séricas de cobalamina y folato, apoyando así la recuperación en perros con PLE y destacando los beneficios de enfoques dietéticos personalizados en el manejo de enfermedades gastrointestinales en perros.
Según estos hallazgos, Farmina desarrolló Vetlife Intestinal UltraCare Low Fat, una dieta de ingredientes limitados específicamente formulada para la EC en perros, que presenta pescado hidrolizado y aceite de pescado como fuentes únicas de proteína y grasa, y está enriquecida con folato y cobalamina para normalizar los niveles vitamínicos en casos de malabsorción.
Según estos hallazgos, Farmina desarrolló Vetlife Intestinal UltraCare Low Fat, una dieta de ingredientes limitados específicamente formulada para la EC en perros, que presenta pescado hidrolizado y aceite de pescado como fuentes únicas de proteína y grasa, y está enriquecida con folato y cobalamina para normalizar los niveles vitamínicos en casos de malabsorción.
Para leer el artículo original, utiliza el código QR.



• Abordaje del politraumatismo en gatos
• Manejo anestésico en una gata sometida a craneotomía
• Displasia de cadera
• Tratamiento quirúrgico de la subluxación atlantoaxial
Una correcta evaluación permite identificar lesiones, determinar intervenciones y evaluar si los cuidados definitivos pueden lograrse con los recursos locales.
Kelly E. Hall
DVM,
MS, Dipl. ACVECC.
Clinical Sciences Department, Colorado State University, Fort Collins, Colorado (EE. UU.).
Los traumatismos en los gatos son frecuentes. A pesar de una buena supervivencia general hasta el alta, es una de las principales causas de muerte1,2. En el registro de traumatismos del ACVECC-VetCOT, la caída desde una altura, el atropello por un vehículo y la causa desconocida de la lesión (es decir, el gato aparece lesionado después de haber desaparecido) son las tres principales causas de lesiones contundentes en los gatos, mientras que la herida por mordedura y la lesión penetrante desconocida encabezan la lista de causas penetrantes (datos no publicados, registro del VetCOT de 2017-2019). Las cinco principales causas de mortalidad en gatos (que reflejan lesiones complejas) son el atropello, la expulsión de un vehículo, la herida por mordedura no penetrante (lesión por aplastamiento), la lesión balística y la lesión por asfixia/tracción. Los factores que influyen en el resultado incluyen el grado de la lesión y los recursos disponibles (médicos y económicos) para identificar y tratar las lesiones3. Por estas razones, se recomienda un abordaje sistemático de lo que puede ser una situación compleja y dinámica4,5. Una evaluación primaria completada rápidamente, seguida de una evaluación secundaria, permiten identificar las lesiones, determinar las intervenciones y evaluar si los cuidados definitivos pueden lograrse con los recursos locales frente a la necesidad de derivar a un hospital veterinario con recursos adicionales (p. ej., productos sanguíneos, técnicas de imagen avanzadas, atención especializada).
El objetivo de la evaluación primaria es identificar y tratar rápidamente las lesiones que ponen en peligro la vida del paciente en el orden en que lo hacen. La evaluación primaria se revisa y se vuelve a realizar cada vez que cambia el estado del paciente. Un punto clave en un paciente con lesiones leves es que la evaluación primaria puede realizarse en menos de 30 segundos mediante una exploración física visual y breve, anotando la frecuencia y el esfuerzo respiratorio, palpando el pulso e interactuando con el paciente (capacidad de respuesta). En el subgrupo de pacientes con lesiones graves, puede ser necesario intervenir durante la evaluación primaria, lo que alarga el tiempo de realización. La evaluación primaria debe completarse antes de pasar a la evaluación secundaria.
Desangramiento catastrófico
Este primer paso se ha incorporado recientemente a la evaluación primaria del campo de la medicina humana para tratar las hemorragias catastróficas de las extremidades o del tronco que conducen inminentemente a la parada cardiaca (p. ej., una lesión de los vasos mayores)6,7. La evidencia empírica en medicina veterinaria parece indicar que los pacientes felinos con este tipo de lesiones rara vez llegan a un veterinario. En el caso de que un paciente felino se presente con esta complicación, la recomendación es que un miembro del personal comprima o tapone para detener o reducir la hemorragia mientras otros miembros del equipo proceden al resto de la evaluación primaria.
Vías respiratorias
Las lesiones faciales relacionadas con caídas y las lesiones cervicales debidas a
Tabla 1. Evaluación primaria.
X Desangramiento (del inglés exsanguination) catastrófico
A Vías respiratorias (del inglés airway)
B Respiración (del inglés breathing)
¿Hemorragia catastrófica evidente en las extremidades o en la cavidad corporal?
¿Hay una vía abierta y adecuada para que el aire llegue a los alvéolos?
¿Capacidad adecuada para mover el aire (velocidad/ profundidad)?
heridas por mordedura son ejemplos que pueden comprometer las vías respiratorias superiores8,9. Si el paciente tiene dificultades para mover el aire a través de las vías respiratorias, puede ser necesaria la sedación inmediata con intubación o la implantación de una traqueostomía temporal. Lo idóneo es proporcionar a los pacientes suplementación de oxígeno (mediante flujo, mascarilla), ya que las lesiones leves de las vías respiratorias pueden responder, y mejorar la difusión de oxígeno puede tener beneficios sistémicos. La pulsioximetría puede ser un complemento útil siempre que no se retrase la continuación de la evaluación primaria y que el paciente lo tolere.
Tanto los mecanismos contundentes como los penetrantes pueden provocar lesiones que afectan a la frecuencia, la profundidad y el esfuerzo respiratorios, como el hemotórax, el neumotórax, la hernia diafragmática y las contusiones pulmonares. La evaluación de la respiración puede verse dificultada por el dolor y el estrés del paciente. Además de suplementar el oxígeno (como se ha mencionado anteriormente), la auscultación torácica o la evaluación mediante ecografía en el punto de atención (POCUS) pueden ayudar a determinar la necesidad de toracocentesis o de sedación rápida, intubación y ventilación. La utilización de la POCUS durante la evaluación primaria debe limitarse a la identificación de líquido o aire para la toracocentesis; la evaluación completa de la POCUS se reserva para la evaluación secundaria. Si se sospecha la presencia de aire o líquido pleural, se puede realizar perfectamente una toracocentesis sin guía de POCUS. Si el paciente no respira, debe iniciarse inmediatamente la reanimación cardiopulmonar.
Compresión/taponamiento
Toracocentesis
Sedar, intubar, ventilar RCP
C Circulación ¿Perfusión adecuada? Catéter IV Fluidos (v. texto)
D Discapacidad
Auscultación POCUS torácica
Hto/ST o Hb Lactato Gases en sangre POCUS (identificar fuentes de sangrado) Presión arterial
¿Evidencia de lesión en la cabeza o en la columna vertebral? Alivio del dolor Camilla rígida Puntuación de mGCS
E Exposición Entorno Consciencia de los factores del entorno Cubrir las heridas abiertas Minimizar el estrés del paciente y la pérdida de calor
Hb, hemoglobina; Hto, hematocrito; IV, intravenoso; mGCS, puntuación en la escala de coma de Glasgow modificada; POCUS, ecografía en el punto de atención; RCP, reanimación cardiopulmonar; SpO2, saturación capilar periférica de oxígeno; ST, sólidos totales.
del grupo de trabajo del Módulo 1 del Curso de Estabilización del Traumatismo.

Cabeza
Tórax y región cervical
Abdomen
Pelvis y periné
Sistema neurológico
Extremidades
Tabla 2. Evaluación secundaria
Hallazgos y lesiones comunes/posibles
Laceración, hemorragia, proptosis, defecto corneal, lesiones o fracturas dentales/maxilofaciales, hemorragia auditiva
Pinchazos, laceración, fracturas de costillas, tórax inestable, neumotórax, hemotórax, contusiones pulmonares, hernia diafragmática
Hemoabdomen, uroabdomen, evisceración, lesión penetrante gastrointestinal, hemorragia de otros órganos sólidos o lesión por aplastamiento, defecto de la pared abdominal, desgarro del tendón prepúbico
Fractura(s) pélvica(s), hemorragia, laceraciones, daño rectal/uretral
Lesión cerebral traumática, lesión de la médula espinal, lesión de los nervios periféricos
Fracturas de huesos largos, hemorragias, laceraciones, lesiones por aplastamiento, dislocación, abrasiones (de superficiales a profundas)
Complementos de la evaluación
Laringoscopio Otoscopio Oftalmoscopio Radiografías/TC
POCUS
Pulsioximetría/gasometría Toracocentesis Radiografías/TC
POCUS
Abdominocentesis Radiografías/TC
Examen rectal
Radiografías/TC
Puntuación de la mGCS
Examen neurológico completo
Radiografías
mGCS, escala de coma de Glasgow modificada; POCUS, ecografía en el punto de atención; TC, tomografía computarizada.
Modificado del grupo de trabajo del Módulo 1 del Curso de Estabilización del Traumatismo.
Circulación
El shock hipovolémico (p. ej., la hemorragia) puede ser el resultado de una lesión traumática contundente o penetrante. La cuantificación de la sangre perdida supone un reto debido a la pérdida de sangre externa en el camino y a las dificultades para cuantificar el volumen perdido en las cavidades (p. ej., torácica, abdominal, retroperitoneal, gastrointestinal) y en los órganos sólidos (p. ej., contusiones, compartimentos musculares). En consecuencia, los parámetros de la exploración física se utilizan inicialmente para evaluar la capacidad circulatoria: el color de las mucosas y el tiempo de relleno capilar, la frecuencia y la calidad del pulso, el estado mental y la temperatura de las extremidades. Se recomienda iniciar un bolo IV (5-10 ml/kg durante 10-20 minutos) de un cristaloide isotónico equilibrado si se sospecha un shock basado en los resultados de la evaluación primaria. El objetivo de la reanimación con fluidos es asegurar la perfusión y la capacidad de transporte de oxígeno a los tejidos, al tiempo que se minimizan los posibles efectos negativos de la sobrecarga de volumen, el edema de órganos, la dilución de los factores de coagulación y el daño al endotelio.
En el informe del registro del VetCOT de 2013-2017 de más de 3.400 gatos con lesiones traumáticas, el 16,5 % tenía evidencia de lesión craneal.
En resumen, un bolo inicial de cristaloides y el control de la hemorragia en curso con la consideración temprana de la administración de hemoderivados en un paciente traumatizado con hemorragia grave que no responde a los cristaloides son las recomendaciones actuales. Lo idóneo es medir mínimamente el hematocrito y los sólidos totales (Hto/ST) desde el centro del catéter durante la colocación del catéter IV para la reanimación con fluidos con los valores de lactato, gasometría (para incluir el exceso de base [EB]), electrolitos y glucosa claramente recomendados durante la evaluación primaria (y solo requieren un pequeño volumen de sangre para muchos instrumentos de diagnóstico).
Si no hay retraso en la evaluación primaria, la obtención de muestras para un hemograma completo, un perfil bioquímico, el grupo sanguíneo y las pruebas de coagulación pueden ayudar a orientar la atención.
Si el paciente está gravemente comprometido, es necesario identificar y abordar la determinación de la hemorragia en las cavidades principales. El uso de la POCUS para identificar el líquido pleural, pulmonar, pericárdico, peritoneal y/o retroperito-
Perfusión Cardiaco
MM rosas y húmedas
TRC de <2 s Temperatura rectal ≥37,8 °C
Pulsos femorales fuertes o saltones
FC: 120-200 Ritmo sinusal normal
neal puede utilizarse como complemento en pacientes que están gravemente comprometidos durante la evaluación primaria; de lo contrario, la POCUS completa se realiza durante la evaluación secundaria. En los perros, una puntuación de líquido abdominal de 3 o 4 (cuando se evalúa la evidencia de líquido en cuatro cuadrantes abdominales) se asoció con la necesidad de transfusión10. Otros valores asociados a la transfusión de sangre en perros con lesiones traumáticas incluyen un EB <–6,6 mmol/l y calcio ionizado <1,24 mmol/l (<2,50 mEq/l)11,12. Aunque estos valores no se han establecido en los gatos, con esta combinación de hallazgos se debe considerar la determinación del grupo sanguíneo y la prueba cruzada, la evaluación de la disponibilidad de productos sanguíneos y la estimación del propietario para la transfusión de sangre.
Discapacidad
En el informe del registro del VetCOT (Veterinary Committee on Trauma Registry Report) de 2013-2017 de más de 3.400 gatos con lesiones traumáticas, el 16,5 % tenía evidencia de lesión craneal y el 8,7 % de traumatismo de la columna vertebral2. Durante la evaluación primaria se ha de determinar la puntuación de la escala de coma de Glasgow modificada para evaluar la lesión cerebral, y deben realizarse y determinarse la palpación
Respiratorio
Frecuencia respiratoria regular sin estridor No hay componente abdominal en la respiración
MM hiperémicas o de color rosa pálido; MM pegajosas
TRC de 0-2 s Temperatura
rectal ≥37,8 °C
Pulsos femorales adecuados
FC: 200-260 Ritmo sinusal normal o CVP <20/ min
Ritmo de respiración y esfuerzo leves ↑ ± algún componente abdominal Sonidos leves ↑ de las vías respiratorias superiores
Ojo/músculo/ tegumento
Grado 0
Abrasión, laceración: de espesor nulo o parcial Ojo: no hay captación de fluoresceína
Grado 1
Abrasión, laceración: espesor total, sin afectación del tejido profundo Ojo: laceración/ úlcera corneal, no perforada
Grado 2
MM rosas
muy pálidas y muy pegajosas
TRC de 2-3 s
Temperatura
rectal <37,8 °C
Pulsos femorales detectables pero débiles
MM grises, azules o blancas
TRC de >3 s Temperatura rectal <37,8 °C
No se detecta el pulso femoral
FC: >260 Arritmia constante
Esfuerzo respiratorio moderado ↑ con componente abdominal, abducción del codo Sonidos moderados ↑ de las vías respiratorias superiores
Abrasión, laceración: espesor total, afectación de tejidos profundos, y arterias, nervios y músculos intactos
Ojo: perforación de la córnea, perforación del globo o proptosis
Grado 3
de la columna vertebral y la evaluación rápida de la función de las extremidades, respectivamente. Además de proporcionar suplementación de oxígeno (como se ha indicado anteriormente), es importante tener en cuenta consideraciones adicionales para la fluidoterapia en pacientes con indicios de lesión cerebral traumática en un esfuerzo por asegurar la perfusión y minimizar la lesión cerebral secundaria. Se debe inmovilizar a los pacientes con evidencia de lesión medular para evitar daños mayores hasta que se realice una evaluación secundaria y se obtengan estudios de imagen avanzados.
Una vez determinada la evaluación neurológica preliminar, se ha de administrar la analgesia adecuada.
Exposición/entorno
Deben tomarse medidas para garantizar que las heridas abiertas se cubran hasta que puedan abordarse definitivamente tras la evaluación secundaria. Además, están indicadas las medidas para reducir la pérdida de calor en aquellos sin temperatura corporal elevada. Los equipos médicos han de ser conscientes de no exacerbar el estrés del paciente. Entre las posibles intervenciones se encuentran el vendaje estéril tvemporal para cubrir las heridas abiertas, las intervenciones de recalentamiento pasivas y activas (p. ej., la colocación de una manta o toalla entre el paciente y la mesa
Esqueleto
Carga de peso en tres o cuatro extremidades, sin fractura palpable ni laxitud articular
Fx apendicular/costilla cerrada o cualquier fx mandibular
Laxitud/luxación articular única, incluida la articulación sacroilíaca
Fx pélvica con SI-ilionacetábulo unilateral intacta
Fx abierta/cerrada de una extremidad en o por debajo del carpo/tarso
Múltiples situaciones de grado 1 (v. anteriormente)
Fractura abierta de un solo hueso largo por encima del carpo/ tarso con hueso cortical conservado
Fractura de cráneo no mandibular
Neurológico
Central: consciente, alerta ligeramente apagado; interés en el entorno Periférico: reflejos espinales normales; movimiento intencionado y nocicepción en todas las extremidades
Central: consciente pero apagado, deprimido, retraído
Periférico: reflejos espinales anormales con movimiento intencionado y nocicepción intacta en las cuatro extremidades
Central: inconsciente pero responde a los estímulos dolorosos
Periférico: ausencia de movimiento intencionado con nocicepción intacta en dos o más extremidades o nocicepción ausente solo en una extremidad ↓ Tono anal y/o de la cola
FC: ≤120 Arritmia errática
Esfuerzo respiratorio marcado o jadeo/ respiración agónica o esfuerzo irregular Paso de aire poco o nada detectable
complejos ventriculares prematuros;
Penetración en la cavidad torácica/ abdominal
Abrasión, laceración: espesor total, afectación de tejidos profundos y compromiso de arterias, nervios o músculos
Fractura/luxación del cuerpo vertebral (excepto coccígea)
Fractura abierta múltiple de hueso largo por encima del tarso/carpo
Fractura abierta de un hueso largo por encima del tarso/carpo con pérdida de hueso cortical
Central: no responde a todos los estímulos; convulsiones refractarias
Periférico: ausencia de nocicepción en dos o más extremidades; ausencia de nocicepción en la cola o en la zona perianal
de metal, los líquidos calentados) y las técnicas de manipulación Fear Free.
Evaluación secundaria
La evaluación secundaria debe iniciarse solo después de que se haya completado la evaluación primaria, y se haya evaluado al paciente como estable o de que las anomalías que amenazan su vida estén tratándose activamente y mejorando. Si el estado del paciente empeora en algún momento, se recomienda volver a realizar la evaluación primaria de forma sistemática.
La tabla 2 representa un abordaje «de la cabeza a las extremidades» para la evaluación secundaria, incluidos los hallazgos comunes en pacientes con traumatismos felinos y las herramientas complementarias que pueden ser necesarias para completar la evaluación.
El objetivo de la evaluación secundaria es garantizar que toda la información pertinente sobre las lesiones del paciente se determine de forma oportuna para crear un plan, determinar los recursos necesarios y comunicar al propietario el estado actual y los pasos siguientes. Gracias a los avances y a la disponibilidad de muchas herramientas de cabecera, la mayor parte de la evaluación del paciente puede realizarse a pie de cama. Dicho esto, puede ser necesario realizar un diagnóstico mediante estudios de imagen (p. ej., radiografías, tomografía computarizada) para identificar plenamente el alcance de las lesiones y los recursos necesarios para su reparación (p. ej., fracturas, procedimientos quirúrgicos, etc.). Dado que hay un coste adicional y potencialmente una anestesia asociada con el componente del diagnóstico por imagen de una evaluación secundaria, los hallazgos identificados a pie de cama son aún más importantes en medicina veterinaria para establecer las recomendaciones para los siguientes pasos diagnósticos y terapéuticos.
Mientras el clínico realiza la evaluación secundaria se aconseja, si los recursos del personal lo permiten, obtener una anamnesis abreviada del propietario. Se recomiendan preguntas breves sobre el historial que incluyan cómo se produjo la lesión, el estado del paciente entre la lesión y la llegada a la clínica (capacidad para respirar, caminar, interactuar), cualquier alergia, medicamentos actuales y enfermedades o diagnósticos recientes. Si está disponible, un compañero de equipo adicional puede (re)obtener y documentar las constantes vitales del paciente (temperatura, frecuencia y calidad del pulso, frecuencia respiratoria, peso corporal) y la puntuación de la escala de triaje de traumatismos en animales (ATT, Animal Trauma Triage) (tabla 3) que se ha validado como puntuación de «grado de lesión» en pacientes felinos3,13 Preparación, comunicación y trabajo en equipo
Aunque la mayoría de los pacientes felinos con traumatismos tienen lesiones relativamente menores y las evaluaciones primaria y secundaria pueden completarse rápidamente por uno o dos miembros del equipo, es importante que el equipo se prepare cuidadosamente para las situaciones en las que los pacientes felinos con lesiones más graves lleguen a interrumpir el flujo clínico diario. Los protocolos de preparación establecidos y/o las listas de comprobación pueden tener un impacto positivo en el resultado del paciente y en la confianza del equipo5,7 Debe tenerse en cuenta:
• Carro de paradas designado con los suministros necesarios para la reanimación traumatológica (evaluación primaria) o la RCP.
• Formulario de consentimiento establecido y presupuesto de estabilización para los propietarios que incluye los honorarios asociados con las evaluaciones primaria y secundaria (p. ej., tarifa de evaluación, suplemento de oxígeno, catéter IV, fluidos iniciales, base de datos mínima, POCUS, alivio del dolor).
• Personal de recepción capacitado para obtener el consentimiento informado de los propietarios en situaciones de urgencia ± obtener información histórica pertinente para la evaluación secundaria.
• Relación con otros centros y protocolo de transporte para los pacientes que necesitan recursos médicos adicionales para la atención definitiva (p. ej., pro-
ductos sanguíneos, monitorización de 24 horas, intervenciones especializadas).
• Equipo capaz de adaptarse fácilmente a las funciones de los casos más graves (es posible que una persona tenga que desempeñar varias funciones):
- Líder (realiza las evaluaciones primaria y secundaria).
- Colocación de catéteres IV.
- Colocación de equipos de monitorización y realización de análisis de sangre a pie de cama.
- Preparación de los medicamentos y los fluidos para su administración.
- Registro de los hallazgos y las intervenciones.
- Comunicación con el propietario.
Bibliografía disponible en https://www.grupoasis.com/argos/ bibliografias/politraumatismo262.docx
Este artículo es un extracto de la obra Urgencias y cuidados intensivos en medicina felina
Disponible en https://ediciones edra.com/ Tel.: 976 461 480


Los resultados observados en este caso sugieren que la alfaxalona puede ser una buena alternativa al propofol para el mantenimiento anestésico intravenoso en cirugía intracraneal en gatos, si bien se requieren futuros estudios al respecto.
Alejandro Sánchez López1, Ana Ernesto González1, José Luis Caldera Burguillos2, Iago Asorey Blázquez1
1Servicio de Anestesia y Analgesia.
2Servicio de Neurología.
Hospital Veterinario Puchol Imágenes cedidas por los autores
Introducción: regulación del flujo sanguíneo cerebral y la presión intracraneal
La doctrina de Monroe-Kellie establece que el volumen total dentro del cráneo permanece constante debido a la restricción impuesta por la bóveda craneal. La función del cerebro depende de que la circulación cerebral se mantenga en este espacio. Dentro del cráneo hay tres componentes principales que determinan el volumen total: el parénquima cerebral (que compone un 80-85 %), el líquido cefalorraquídeo (10 %) y la sangre (arterial y venosa, 10-15 %)1,2,3
Según esta doctrina, debido a la naturaleza fija del cráneo, la suma de sus volúmenes debe permanecer constante para mantener una presión intracraneal (PIC) fisiológica de 5-12 mmHg. Cualquier aumento en el volumen de uno de estos componentes debe ser contrarrestado por una disminución correspondiente en el volumen de otro componente para mantener estable esta presión1. Aunque los elementos intracraneales son mayormente no compresibles, el líquido cefalorraquídeo y la sangre venosa pueden redistribuirse hacia sistemas de baja presión fuera del cráneo si la PIC aumenta1,3
Cuando este mecanismo compensatorio se agota, la PIC aumenta rápidamente, lo que lleva a cambios en la presión de perfusión cerebral (PPC) y el flujo sanguíneo cerebral (FSC)1 (figura 1).
la resistencia vascular sistémica (RVS) son esenciales1
En pacientes con enfermedad intracraneal, es recomendable mantener la PPC >70 mmHg, lo que se correlaciona con una PAM de 70-80 mmHg. En caso de un aumento de la PIC, se producirá un aumento de la PAM por vasoconstricción, para así mantener la PPC constante; como consecuencia, se estimulan los barorreceptores aórticos y carotídeos, dando lugar a una bradicardia refleja. Cuando la vasoconstricción es muy marcada, se produce el reflejo de Cushing, caracterizado por hipertensión, bradicardia refleja y respiración paradójica1,3,4
La resistencia vascular cerebral (RVC) se autorregula en el cerebro sano, manteniendo el FSC constante dentro de un amplio rango de presiones (PAM 50-150 mmHg)5,6. Sin embargo, en un cerebro enfermo, la autorregulación puede estar comprometida, lo que hace que el FSC dependa más directamente de la presión arterial sistémica. Por lo tanto, es crucial monitorizar de forma continua y precisa la presión arterial para asegurar PPC adecuada4,7 (figura 2).
Los cambios en la presión arterial de CO2 y el O2 (PaCO2 y PaO2) pueden influir en el FSC: la hipercapnia y la hipoxemia producen vasodilatación, aumentando el FSC. Por el contrario, la hipocapnia produce vasoconstricción, lo que reduce el FSC3,8. Es esencial mantener un equilibrio adecuado de estos factores para asegurar una perfusión cerebral óptima durante la anestesia. El empleo de fracciones inspiradas de oxígeno (FiO2) en torno al 40-60 % y la aplicación de ventilación mecánica con el fin de mantener una fracción inspirada de CO2 (EtCO2) en torno de 30-40 mmHg, son recomendados (figuras 3 y 4).
A la hora de abordar la anestesia de un paciente con aumento de PIC el objetivo principal es mantener lo más constante
En un cerebro enfermo, la autorregulación puede estar comprometida, lo que hace que el FSC dependa más directamente de la presión arterial sistémica. Por lo tanto, es crucial monitorizar de forma continua y precisa la presión arterial para asegurar PPC adecuada4,7
La PPC es la presión sanguínea mínima para irrigar el cerebro y asegurar el aporte de oxígeno (O2) suficiente. Se calcula como la diferencia entre la presión arterial media (PAM) y la PIC. Por tanto, dado que la PPC está directamente relacionada con la PAM, la monitorización y mantenimiento de la PAM, el gasto cardiaco (GC) y
posible el FSC, lo que va estrechamente relacionado con una adecuada estabilidad hemodinámica, ya que el FSC representa una parte importante del GC. Para ello, debemos tener en cuenta los efectos que los fármacos usados en anestesia y diferentes manipulaciones del paciente van a tener sobre FSC y la PIC.
1. Evolución de la presión intracraneal con respecto al aumento del volumen intracraneal.
Titular Figura 2. Relación entre el flujo sanguíneo cerebral y la presión arterial media.
Figura 3. Relación entre el flujo sanguíneo cerebral y la presión arterial de dióxido de carbono.

Se presenta el caso de una gata sometida a craneotomía supratemporal para exéresis de un menigioma, en la que se realizó un mantenimiento anestésico intravenoso para mantener una mayor estabilidad hemodinámica durante la cirugía.
Maine Coon, hembra castrada de 8 años, 3,5 kg y condición corporal 5/9, diagnosticada mediante resonancia magnética de una lesión extradural que afectaba a los lóbulos parietal, temporal y occipital (posiblemente meningioma) y que le producía un cuadro de circling, que en el momento de la anestesia estaba controlado gracias al tratamiento con dexametasona 0,15 mg/ kg/24 h. Como otros antecedentes clínicos, la paciente presentaba barro biliar, iniciándose el tratamiento con ácido ursodesoxicólico.
El día previo a la intervención, se hospitalizó a la paciente para continuar el tratamiento con dexametasona, al cual se añadieron fenobarbital 3 mg/kg/8 h IV, una dosis única de manitol 1 g/kg IV, y fluidoterapia con suero fisiológico salino (SFS) 0,9 %. Se realizaron hemograma, bioquímica sanguínea (ambas sin alteraciones significativas) y tipificación de grupo sanguíneo (grupo A).
La exploración física del paciente reveló una frecuencia cardiaca (FC) basal de 186 latidos por minuto, frecuencia respiratoria (FR) basal de 32 respiraciones por minuto, unas mucosas rosadas y normotermia.
Se realizó la inducción anestésica con 1,5 mg/kg de alfaxalona IV y 5 mcg/ kg de fentanilo IV, se instilaron dos gotas de lidocaína al 2 % en la laringe, y se llevó a cabo la intubación de la tráquea con tubo endotraqueal rígido de 3,5 mm, iniciándose el mantenimiento anestésico con infusiones intravenosas continuas de alfaxalona 0,1 mg/kg/min, dexmedetomidina 2 mcg/kg/h y fentanilo 2 mcg/kg/h.
Se realizó ayuno preanestésico de 12 horas sólidos y 10 de líquidos. Aproximadamente 20 minutos antes de la premediación se administró a la paciente maropitant 1 mg/kg IV y ácido tranexámico 15 mg/kg IV. La premedicación consistió en 2 mcg/ kg de dexmedetomidina IV y 0,3 mg/kg de midazolam IV, se realizó la inducción anestésica con 1,5 mg/kg de alfaxalona IV y 5 mcg/kg de fentanilo IV, se instilaron dos gotas de lidocaína al 2 % en la laringe, y se llevó a cabo la intubación de la tráquea con tubo endotraqueal rígido de 3,5 mm, iniciándose el mantenimiento anestésico con infusiones intravenosas continuas de alfaxalona 0,1 mg/kg/min, dexmedetomidina 2 mcg/kg/h y fentanilo 2 mcg/kg/h. Durante la preparación quirúrgica, se mantuvo al paciente con una FiO2 del 100 %, se lubricaron las córneas con lágrima artificial y se cubrieron de cara al resto de la cirugía. Se estableció un acceso arterial en la arteria coccígea con una catéter de 24G. Se trasladó a la paciente a quirófano, donde se posicionó en decúbito esternal y se cambió la FiO2 al 50 %, y se inició la fluidoterapia con SFS a 3 ml/kg/h. La monitorización consistió en: electrocardiograma (ECG), saturación de oxígeno de la hemoglobina (SpO2), EtCO2, presiones arteriales invasiva y no invasiva, temperatura y espirometría. El plano anestésico se monitorizó mediante la ausencia de respuestas hemodinámicas (cambios en FC, FR y presión arterial) a la manipulación quirúrgica.
Al comienzo de la cirugía, la paciente presentó hipotensión leve (PAM 57 mmHg) que se corrigió con la administración de 0,1 mg/kg de efedrina IV. La FC al inicio de la anestesia fue de 150 lpm, y fue disminuyendo gradualmente hasta 120 lpm, manteniéndose en este valor el resto de la anestesia. Tras unos 60 minutos del inicio de la cirugía, la paciente comenzó a mostrar hipercapnia (EtCO2 47 mmHg), por lo que se decidió instaurar ventilación mecánica controlada por volumen (VCV) con los siguientes parámetros: volumen tidal (VT) 10 ml/kg, FR 10-15 rpm, relación inspiración:espiración (I:E) de 1:2, pausa inspiratoria 30 % y presión positiva al final de la espiración (PEEP) de 3 cmH2O. El resto de la anestesia transcurrió sin más complicaciones que el desarrollo de hipotermia hasta 34,5 °C, destacándose la estabilidad en los valores de FC (figura 5) y presiones arteriales (figura 6) a lo largo de la misma.
La dosis de las infusiones de alfaxalona y dexmedetomidina se redujeron progresivamente con el objetivo de no prolongar la recuperación de la paciente. La dosis de la infusión de fentanilo se fue reduciendo
El propofol y la alfaxalona producen, por el contrario, una buena regulación de la PPC y la PIC12,13,14, así como una mayor estabilidad cardiovascular que los anestésicos inhalatorios.
adecuada y la paciente fue transferido al servicio de hospitalización. La glositis fue remitiendo de forma progresiva en menos de 24 horas, sin causar obstrucción de la vía en ningún momento.
Discusión
En el caso descrito, la anestesia total intrvenosa (TIVA) con alfaxalona en combinación con dexmedetomidina y fentanilo, permitió mantener una adecuada estabilidad hemodinámica durante todo el procedimiento quirúrgico.
Los anestésicos inhalatorios producen vasodilatación cerebral dosis-dependiente que conduce a aumento de la PIC9,10. Este efecto es mayor en el caso del isoflurano que en el del sevoflurano11, por lo que este último suele ser el agente anestésico de elección en el caso de realizarse el mantenimiento anestésico inhalatorio en cirugía intracraneal3,10
El propofol y la alfaxalona producen, por el contrario, una buena regulación de la PPC y la PIC12,13,14, así como una mayor estabilidad cardiovascular que los anestésicos inhalatorios15,16. Por ello, la TIVA con propofol es de elección en pacientes con patología intracraneal, tanto en humanos3 como en perros12,36. En gatos, las infusiones continuas de propofol se han asociado al desarrollo de anemias con cuerpos de Heinz17, así como a recuperaciones muy prolongadas18, por lo que en esta paciente se optó por utilizar TIVA con alfaxalona, que ha mostrado una estabilidad cardiovascular muy similar a la de propofol19,20, y con una recuperación que si bien es más lenta que con el mantenimiento inhalatorio15,16,19, es de calidad aceptable en experiencia de los autores.
Para el mantenimiento anestésico se añadieron CRIs (Continuous Rate Infusion) de dexmedetomidina y fentanilo. El uso de agonistas α-2 adrenérgicos como la dexmedetomidina podría parecer controvertido en estos pacientes, ya que producen hipertensión transitoria por
El uso de agonistas α-2 adrenérgicos como la dexmedetomidina podría parecer controvertido en estos pacientes, ya que producen hipertensión transitoria por vasoconstricción periférica6; sin embargo, también aportan beneficios tales como reducción de la PIC por inhibición de la vasodilatación cerebral, analgesia y prevención de hemorragias cerebrales21,22,23
en un 25 % cada 30 minutos desde su inicio. El tiempo total de anestesia fue de 215 minutos y el tiempo desde el fin de la cirugía hasta la extubación de 30 minutos.
Se estimó una pérdida total de sangre de aproximadamente 17,8 ml (<10 % del volumen circulante total), se midió el hematocrito del paciente tras la cirugía y a las 12 h de esta y se hallaron valores de 26 % y 35 % respectivamente (valor preoperatorio de 44,8 %).
Tras la cirugía, se observó glositis grave. Se administró dexametasona a 0,3 mg/kg IV y se aplicó frío local hasta conseguir la extubación segura de la paciente. Se sospechó de una posible lesión mecánica por presión de los dientes durante la cirugía (figura 6). La recuperación anestésica fue
vasoconstricción periférica6, lo que puede dar como resultado aumento de la PPC y por ello de la PIC8; sin embargo, estos fármacos también aportan beneficios tales como reducción de la PIC por inhibición de la vasodilatación cerebral, relajación muscular, reducción de la CAM de anestésicos inhalatorios, analgesia y prevención de hemorragias cerebrales21,22,23 Los opioides no tienen un efecto directo sobre la PIC6 y permiten prevenir la nocicepción durante la cirugía intracraneal; sin embargo, dado que producen depresión respiratoria y que los pacientes con riesgo de aumento de PIC son más sensibles a los efectos centrales de estos fármacos, es recomendable minimizar su uso9,24. En este caso, se decidió evitar el uso de opioides

La manipulación directa del tejido cerebral puede producir aumentos bruscos de la PIC y ocasionar convulsiones perioperatorias y edema cerebral34. En esta paciente, se inició tratamiento con fenobarbital la noche previa a la anestesia y se administró 1 g/kg de manitol IV.
de acción más prolongada como la metadona, y optar por otros de eliminación más rápida como el fentanilo, empleando su dosis mínima efectiva25 y reduciendo la misma un 25 % cada 30 minutos desde su inicio para evitar un posible efecto acumulativo que retrasara la recuperación y/o produjera depresión respiratoria durante la misma25. El uso de otros opioides de acción corta, como alfentanilo o remifentanilo, habría estado más indicado para favorecer una recuperación más rápida25, pero no se disponía de ellos.
Durante la intubación o extubación pueden producirse situaciones que aumenten la PIC, como la tos o el vómito1,8. En esta paciente se administró maropitant antes de la premedicación anestésica con el fin de reducir el riesgo de vómito perioperatorio26. Por otro lado, con el fin de evitar

Bibliografía:
la aparición de reflejo tusígeno durante la intubación de la tráquea, se desensibilizó la laringe con lidocaína al 2 %27 y se administraron 5 mcg/kg de fentanilo IV como parte de la inducción anestésica28
Dada la zona quirúrgica, durante la cirugía intracraneal en perros y gatos no es posible realizar la monitorización del plano anestésico por observación de la posición del globo ocular y la ausencia de reflejo palpebral y tono mandibular29 En medicina humana, el plano anestésico se monitoriza con el monitor de índice biespectral (BIS) que, a pesar de haber sido estudiado en pequeños animales, no se aconseja como único método para la evaluación del plano anestésico en estas especies por la disparidad de resultados30,31. Por ello, en esta paciente se optó por la monitorización indirecta de plano anestésico mediante: cambios en FR, FC y presión arterial29
Debido al riesgo de hemorragia por la alta vascularización del tejido cerebral1,8,32, se tipificó el grupo sanguíneo de la paciente antes de la cirugía y se aseguró que se disponía de concentrado de glóbulos rojos (CGR); también se administró una dosis previa de 15 mg/kg de ácido tranexámico para minimizar el riesgo de sangrado perioperatorio33. En este caso, el
1. Grimm, K. A., Lamont, L. A., Tranquilli, W. J., Greene, S. A., & Robertson, S. A. (Eds.). (2015). Veterinary anesthesia and analgesia (Fifth edition of Lumb and Jones). Wiley Blackwell.
2. Seki, S., Teshima, K., Ito, D., Kitagawa, M., & Yamaya, Y. (2019). Impact of intracranial hypertension on the short-term prognosis in dogs undergoing brain tumor surgery. Journal of Veterinary Medical Science, 81(8), 1205-1210.
3. Marchionne, G., Alcoverro, E., Spinillo, S., & Louro, L. F. (2023). Anaesthetic management in a cat undergoing emergency craniotomy for meningioma excision. Journal of Feline Medicine and Surgery Open Reports, 9(2).
4. Ortiz-Prado, E., León, A. B., & Unigarro, L. (2018). Oxigenación y Flujo Sanguíneo Cerebral, Revisión Comprensiva de la Literatura.
5. Green SA (2010) Anesthesia for patients with neurologic disease. Top Companion Anim Med 25, 83–86.
6. Harvey RC, Green SA, Thomas WB (2007) Neurological disease. In: Lumb & Jones” Veterinary Anesthesia and Analgesia (4th edn). Tranquilli WJ, Thurmon JC, Grimm KA (eds). Blackwell Publishing, Ames, USA. pp. 903– 913
7. Jo, K. W., Jung, H.-J., Yoo, D. S., & Park, H.-K. (2021). Changes in Blood Pressure and Heart Rate during Decompressive Craniectomy. Journal of Korean Neurosurgical Society, 64(6), 957-965.
8. Schizodimos, T., Soulountsi, V., Iasonidou, C., & Kapravelos, N. (2020). An overview of management of intracranial hypertension in the intensive care unit. Journal of Anesthesia, 34(5), 741-757.
9. Sakabe T, Matsumoto M (2010) Effects of anesthetic agents and other drugs on cerebral blood flow, metabolism, and intracranial pressure. In: Cottrell and Young’s Neuroanesthesia (5th edn). Cottrell JE, Young WL (eds). Mosby Elsevier, Philadelphia, USA. 78–94.
10.Marquez-Grados, F., Vettorato, E., & Corletto, F. (2020). Sevoflurane with opioid or dexmedetomidine infusions in dogs undergoing intracranial surgery: A retrospective observational study. Journal of Veterinary Science, 21(1).
11. Matta BF, Heath KJ, Tipping K, Summors AC. Direct cerebral vasodilatory effects of sevoflurane and isoflurane. Anesthesiology. 1999 Sep;91(3):677-80.
12.Caines D, Sinclair M, Valverde A, Dyson D, Gaitero L, Wood D. Comparison of isoflurane and propofol for maintenance of anesthesia in dogs with intracranial disease undergoing magnetic resonance imaging. Vet Anaesth Analg. 2014 Sep;41(5):468-79.
sangrado intraquirúrgico no fue significativo y no se requirió transfusión de CGR.
Al igual que en este caso, la lengua puede sufrir lesiones si queda fuera de la cavidad oral y favorece su compresión debido a la manipulación y posicionamiento de la cabeza1. Se debe asegurar que la lengua queda dentro de la cavidad oral durante la cirugía y, en caso de detectarse glositis, se debe aplicar frío local, tratamiento antiinflamatorio, y observar la evolución de esta y la posible aparición de dificultad respiratoria. Aunque la glositis observada no tuvo consecuencias importantes en este caso, pero podría haber resultado en una obstrucción parcial o completa de la vía aérea de la paciente. La manipulación directa del tejido cerebral puede producir aumentos bruscos de la PIC y dar como resultado el desarrollo de convulsiones perioperatorias y edema cerebral34. En esta paciente, se inició tratamiento con fenobarbital la noche previa a la anestesia y se administró 1 g/kg de manitol IV. El manitol es un potente diurético osmótico que reduce la PIC al producir el paso de fluido del compartimento extracelular al intravascular3. Una alternativa al manitol es el suero hipertónico salino (SHS) al 7,5 %, que produce efectos similares y además aumenta el GC y la presión arterial35, por lo que su uso más habitual en medicina humana es con este fin36. Dado que el SHS puede producir hipernatremia35, otra potencial complicación en cirugía intracraneal33, en esta paciente se prefirió el uso de manitol. En esta paciente se decidió emplear SFS al 0,9 % como fluido de mantenimiento. El SFS presenta una mejor pre-
La glositis observada en la paciente es una potencial complicación para tener en cuenta durante la cirugía intracraneal, especialmente en pacientes de pequeño tamaño.
13.Raisis AL, Leece EA, Platt SR, Adams VJ, Corletto F, Brearley J. Evaluation of an anaesthetic technique used in dogs undergoing craniectomy for tumour resection. Vet Anaesth Analg. 2007 May;34(3):171-80.
14.Warne LN, Beths T, Fogal S, Bauquier SH. The use of alfaxalone and remifentanil total intravenous anesthesia in a dog undergoing a craniectomy for tumor resection. Can Vet J 2014 Nov;55(11):1083-8.
15.Bustamante R, Aguado D, Cediel R, Gómez de Segura IA, Canfrán S. Clinical comparison of the effects of isoflurane or propofol anaesthesia on mean arterial blood pressure and ventilation in dogs undergoing orthopaedic surgery recei - ving epidural anaesthesia. Vet J. 2018. 233:49-54.
16.Dehuisser V, Bosmans T, Devreese M, Gehring R, Croubles S, Duchateu L, Polis I. Alfaxalone total intravenous anaesthesia in dogs: pharmaco - kinetics, cardiovascular data and recovery charac - teristics. Vet Anaesth Analg. 2019. 46(5):605-612. roceedings IVECCS. 2019: 25-28.
17.Andress JL, Day TK and Day DG. The effects of consecutive day propofol anesthesia on feline red blood cells. Vet Surgery 1995; 24: 277–282. 30.
18.Pascoe PJ, Ilkiw JE and Frischmeyer KJ. The effect of the duration of propofol administration on recovery from anesthesia in cats. Vet Anaesth Analg 2006; 33: 2–7.
19.Suarez MA, Dzikiti BT, Stegmann FG, Hartman M. Comparison of alfaxalone and propofol administered as total intravenous anaesthesia for ovariohysterectomy in dogs. Vet. Anaesth. Analg. 2012. 39: 236-244.
20. Schwarz A, Kalchofner K, Palm J, Picek S, Hartnack S, Bettschart-Wolfensberger R. Minimum infusion rate of alfaxalone for total intravenous anaesthesia after sedation with acepromazine or medetomidine in cats undergoing ovariohysterectomy. Vet Anaesth Analg. 2014 Sep;41(5):480-90.
21.Soliman RN, Hassan AR, Rashwan AM, et al. Prospective, randomized study to assess the role of dexmedetomidine in patients with supratentorial tumors undergoing craniotomy under general anaesthesia. Middle East J Anesthesiol 2011; 21: 325–334.
22.Lin N, Vutskits L, Bebawy JF, et al. Perspectives on dexmedetomidine use for neurosurgical patients. J Neurosurg Anesthesiol 2019; 31: 366–377. 26
23.Wang L, Shen J, Ge L, et al. Dexmedetomidine for craniotomy under general anesthesia: a systematic review and meta-analysis of randomized clinical trials. J Clin Anesth 2019; 54: 114–125.
24.Grimm, K. A., Lamont, L. A., & Tranquilli, W. J. (Eds.). (2013). Manual de anestesia y analgesia en pequeñas especies (J. R. Palacios Martínez, Trad.). Editorial El Manual Moderno.
25.Bradbrook CA, Clark L. State of the art analgesia- recent developments in
• PPC: presión de perfusión cerebral
• PIC: presión intracraneal
• PAM: presión arterial media
• RVS: resistencia vascular sistémica
• RVC: resistencia vascular cerebral
• GC: gasto cardiaco
• PaCO2: presión arterial de dióxido de carbono
• PaO2: presión arterial de oxígeno
• EtCO2: fracción espirada de dióxido de carbono
• SpO2: saturación de oxígeno de la hemoglobina
• FC: frecuencia cardiaca
• FR: frecuencia respiratoria
• TIVA: anestesia total intravenosa
vención del desarrollo de edema cerebral que los cristaloides de mantenimiento como el Ringer Lactato13,14 pero, como desventaja, su uso se asocia al desarrollo de acidosis y desequilibrios electrolíticos como hipokalemia e hipernateria12, por lo que, en caso de utilizarse, se deben realizar gasometrías y mediciones seriadas de electrolitos. En este caso, no pudo realizarse ninguna gasometría por problemas logísticos, pero sí que tras la cirugía y a las 12 horas de esta se midieron electrolitos, que estaban en rango.
Los resultados observados en este caso sugieren que la alfaxalona puede ser una buena alternativa al propofol para el mantenimiento anestésico intravenoso en cirugía intracraneal en gatos, si bien se requieren futuros estudios al respecto. La glositis observada en la paciente es una potencial complicación para tener en cuenta durante la cirugía intracraneal, especialmente en pacientes de pequeño tamaño.
pharmacological approaches to acute pain management in dogs and cats. Part 1. Vet J. 2018 Aug;238:76-82.
26.Martin-Flores M, Sakai DM, Learn MM, Mastrocco A, Campoy L, Boesch JM, Gleed RD. Effects of maropitant in cats receiving dexmedetomidine and morphine. J Am Vet Med Assoc. 2016 Jun 1;248(11):1257-61.
27. Grubb T., Sager J., Gaynor J.S., et al. 2020. 2020 AAHA Anesthesia and Monitoring Guidelines for Dogs and Cats. J Am Anim Hosp Assoc. 56(2):59-82.
28.Martín Bellido V, Martínez I Ferré B, McDonald H, Vettorato E. Effect of intravenous fentanyl on cough reflex and quality of endotracheal intubation in cats. Vet Anaesth Analg. 2023 May;50(3):230-237.
29.Dugdale AHA, Beaumont G, Bradbrook C, Gurney M. Monitoring animals during general anaesthesia. En: Veterinary Anaesthesia, Principles to Practice. 2020. 2.ª ed. Wiley Blackwell, USA.
30.Bleijenberg EH, van Oostrom H, Akkerdaas LC, Doornenbal A, Hellebrekers LJ. Bispectral index and the clinically evaluated anaesthetic depth in dogs. Vet Anaesth Analg. 2011 Nov;38(6):536-43.
31.Lamont LA, Greene SA, Grimm KA, Tranquilli WJ. Relationship of bispectral index to minimum alveolar concentration multiples of sevoflurane in cats. Am J Vet Res. 2004 Jan;65(1):93-8.
32.Forward, A. K., Volk, H. A., & De Decker, S. (2018). Postoperative survival and early complications after intracranial surgery in dogs. Veterinary Surgery, 47(4).
33.Kelley M, Sinnott-Stutzman V, Whelan M. Retrospective analysis of the use of tranexamic acid in critically ill dogs and cats (2018–2019): 266 dogs and 28 cats. Vet Emerg Crit Care (San Antonio). 2022 Nov;32(6):791-799.
34.Parker, R. L., Du, J., Shinn, R. L., Drury, A. G., Hsu, F., Roberston, J. L., Cecere, T. E., Arendse, A. U., & Rossmeisl, J. H. (2022). Incidence, risk factors, and outcomes for early postoperative seizures in dogs with rostrotentorial brain tumors after intracranial surgery. Journal of Veterinary Internal Medicine, 36(2), 694-701.
35. Ballocco, I., Evangelisti, M. A., Deiana, R., Cubeddu, F., Pinna Parpaglia, M. L., Serra, G., Carta, G., & Manunta, M. L. (2019). A pilot study evaluating the effect of mannitol and hypertonic saline solution in the treatment of increased intracranial pressure in 2 cats and 1 dog naturally affected by traumatic brain injury. Journal of Veterinary Emergency and Critical Care, 29(5), 578-584.
36.Kamel H, Navi BB, Nakagawa K, et al. Hypertonic saline frente a mannitol for the treatment of elevated intracranial pressure: a meta-analysis of randomized clinical trials. Crit Care Med 2011; 39: 554–559.
Casi todas las especialidades veterinarias estarán presentes en esta edición, que se celebrará en la sede del Palacio Municipal de Congresos de Madrid entre los días 24 y 26 de octubre.
AVEPA organiza un año más su Congreso Nacional donde 5.000 profesionales de todo el mundo se reunirán para conocer las novedades del sector.
Y de nuevo el congreso regresa a Madrid, concretamente a la sede del Palacio Municipal de Congresos de Madrid, adyacente a la zona de IFEMA.
Bien comunicado por carretera, taxi, autobuses y metro (estación de metro de la línea 8, Feria de Madrid), el Palacio Municipal de Madrid proporcionará sin duda una importante accesibilidad a las actividades del congreso.
El congreso nacional de AVEPA es la actividad más importante de la asociación durante el año y ofrece una excelente oportunidad para intercambiar conocimientos, y discutir los avances más recientes en la medicina veterinaria de animales de compañía. El ejercicio de la profesión veterinaria supone de forma ineludible la formación técnica continuada, y este congreso es el marco ideal para tal ejercicio.
Desde un programa de oncología presentado por la WSAVA, hasta una sala de gestión de centros veterinarios, pasando por seminarios de medicina interna, dermatología, etc. Casi todas las especialidades veterinarias estarán presentes en el congreso, presentadas por los más prestigiosos ponentes nacionales e internacionales.
La organización ofrecerá traducción simultánea de inglés español a los congresistas que la precisen: no olvides traer tu teléfono móvil al congreso y tus auriculares, dado que esta traducción se ofrece mediante el uso de tu propio teléfono móvil.
Programa científico para ATV
El programa científico para auxiliares técnicos veterinarios del AVEPA-SEVC es uno de los eventos de encuentro para los profesionales técnicos de la veterinaria más importantes en España. Profesionales del sector profundizan en los temas de más interés del momento para las ATV.
AVEPA, con el ánimo de hacer más accesible esta formación continuada, desde hace ya 5 años, ofrece a sus socios este congreso con su coste de inscripción incluido en la cuota anual de la asociación, facilitando de esta forma la participación de todos ellos.
AVEPA, con el ánimo de hacer más accesible esta formación continuada, desde hace ya 5 años, ofrece a sus socios este congreso con su coste de inscripción incluido en la cuota anual de la asociación, facilitando de esta forma la participación de todos ellos.
Programa científico para veterinarios
Durante 3 días se ofrecerán más de 120 horas de formación repartidas en 8 salas de conferencias. Más de 80 ponentes internacionales compartirán sus conocimientos, experiencias y casos.
Los temas para este año abarcan aspectos como anestesia, nutrición, odontología, gestión, traumatología y reproducción.
Loa ATV de socios de AVEPA tienen un precio especial de inscripción.
Talleres
“La mejor manera de aprender es practicando”. La oferta de talleres prácticos del AVEPA-SEVC se ha renovado completamente este año ofreciendo 10 talleres para grupos reducidos. Temas como odontología, ecografía, primeros auxilios, exóticos, radiografía o comportamiento serán tratados por ponentes internacionales.


Para la comodidad de los asistentes todos los talleres se celebrarán en el Palacio Municipal de Congresos de Madrid, sede del programa científico y exposición comercial del AVEPA-SEVC.
Los ponentes y personal de apoyo realizarán las explicaciones en castellano e inglés.
Aquí tienes la lista de los talleres prácticos ofrecidos:
• Ecografía abdominal avanzada en el perro, los órganos y vasos más difíciles de examinar.
• Ecografía musculoesquelética para el traumatólogo: práctica en perros y revisión de casos clínicos.
• Primeros auxilios en aves silvestres para veterinarios generalistas.
• Cómo planificar y realizar correctamente una TPLO.
• Radiología dental, extracciones y mucho más. Diagnóstico y tratamiento quirúrgico de las patologías dentales más frecuentes en gatos.
• Sesión interactiva de interpretación radiográfica de casos cardiopulmonares en pequeños animales.
• Mas allá del “mal comportamiento”: descifrando la frustración en perros.
• Sesión interactiva de interpretación de radiográfica y ecográfica de patologías abdominales.
• Taller de interpretación de ecografía hepatobiliar y gastrointestinal basado en casos.
• End-of-life. Estrategias para una despedida compasiva y respetuosa (VetBonds).
“¡Casos 1.000!”
Cada año el comité científico de AVEPA recibe más de 200 comunicaciones científicas (relacionadas con la investigación clínica - incluidas tesis doctorales y estudios laboratoriales -, estudios prospectivos o retrospectivos, etc.) y casos clínicos originales que aporten algo nuevo o diferente a los veterinarios clínicos de pequeños animales o exóticos. Durante el congreso todos los autores presentan sus resúmenes en formato póster. Todos los asistentes pueden ver los pósteres expues-
tos durante los 3 días del congreso o asistir a la presentación, donde los autores están disponibles para contestar preguntas. El comité científico ofrecerá ytres premios a la mejor comunicación, mejor caso clínico y un premio incentivo a veterinarios jóvenes.
El acceso a la zona comercial, pósteres, Sala de Actualidad Veterinaria y servicios es gratuita para veterinarios clínicos, que pueden solicitar su pase en la entrada del Palacio.
Más de 100 empresas internacionales presentarán sus productos y servicios más novedosos y vanguardistas. El veterinario clínico podrá encontrar todo lo necesario para su práctica. En su búsqueda por la excelencia científica, las empresas también ofrecerán presentaciones en la Sala de Actualidad Veterinaria. Esta sala está abierta a todos los asistentes al congreso sin necesidad de estar inscrito al Programa Científico.
El acceso a la zona comercial, pósteres, Sala de Actualidad Veterinaria y servicios es gratuita para veterinarios clínicos, que pueden solicitar su pase en la entrada del Palacio.
La inscripción al Programa Científico para Veterinarios está incluida en la cuota anual de los más de 5.600 socios de AVEPA.
Para más información, encontrarás en la página web del congreso todo lo relativo a programa científico, talleres, empresas participantes, formulario de inscripción, etc.
Esta patología multifactorial combina predisposición genética y factores ambientales. El diagnóstico temprano, basado en la identificación de signos clínicos y pruebas de imagen adecuadas, es crucial para su tratamiento.
Amparo Cabaleiro González Gda. Vet.1,2; Felipe De Vicente Collado Ldo Vet, PhD, FHEA, CertVBM, Dip. ECVS1
1Hospital de referencia Veterios
2AUNA Especialidades Veterinarias
Imágenes cedidas por los autores
Resumen
La displasia de cadera es una de las patologías ortopédicas más frecuentemente diagnosticadas en perros.1-3 Ocurre durante el crecimiento: empieza con laxitud de la articulación coxofemoral y causa inflamación articular y el desarrollo de incongruencia articular y osteoartritis secundaria. Esto provoca, como consecuencia, signos clínicos de diferente grado.1-3
La manifestación de esta patología se debe a una combinación de factores genéticos (herencia poligenética) y ambientales. A pesar de ser una condición altamente estudiada e investigada, el diagnóstico y tratamiento de la displasia de cadera siguen siento tema de debate.1-5 En este artículo se recopila la información disponible sobre la patogénesis, signos clínicos y el diagnóstico de la displasia de cadera.
Se ha descrito la displasia de cadera como una enfermedad derivada de un grado variable de laxitud de la articulación de la cadera, lo que da lugar a grados variables de un acetábulo poco profundo y aplanamiento de la cabeza femoral, que finalmente conducen a osteoartritis1. Aunque esta definición sigue siendo válida, se ha observado una variación significativa entre razas e individuos en cuanto a la tolerancia a la laxitud articular y la incidencia de osteoartritis posterior.2,4 Los perros con predisposición a la displasia de cadera nacen con caderas normales que, posteriormente, muestran una mayor laxitud articular y se vuelven displásicas. Esa laxitud inicial se puede detectar a las pocas semanas de vida. La razón exacta del desarrollo de esta laxitud inicial sigue sin estar clara, aunque se cree que pueden estar involucradas alteraciones en el líquido articular, en la osificación endocondral y alteraciones en el desarrollo acetabular. Se ha estudiado que perros con mayores volúmenes de líquido sinovial y un ligamento engrosado de la cabeza femoral están relacionados con un aumento significativo de la laxitud articular y la incidencia de displasia de cadera. Sin embargo, la regulación del líquido articular se ve alterada cuando se producen procesos inflamatorios, lo que hace imposible distinguir entre que el aumento del líquido sinovial sea el factor primario o que ocurra a consecuencia de la inflamación/degeneración articular.2,4
Independientemente de la causa, la luxación y subluxación de la cadera dan como






Prueba de Barlow (1A, 1B, 1C). Aplicación de fuerza en dirección proximal en el axis del fémur, causando una subluxación de la cabeza del fémur. Prueba de Ortolani (1D, 1E, 1F). Se abduce el fémur manteniendo la aplicación de la fuerza en dirección proximal hasta que la cabeza del fémur se reduce dentro del acetábulo.
resultado una incongruencia articular y una distribución inadecuada de las fuerzas dentro de la articulación, lo que provoca desgaste anormal del cartílago, microfracturas y el desarrollo de osteoartritis.2,4
Etiología y patogénesis
La displasia de cadera se manifiesta en animales genéticamente predispuestos que están expuestos a factores ambientales que potencian la expresión genética.2,4 En un paciente predispuesto, factores externos pueden determinar la expresión y grado de la displasia.2,4 Los principales factores propuestos son los siguientes.
Factores hormonales
Se ha observado que la administración de altas dosis de estrógeno exógeno a cachorros jóvenes y perras gestantes puede provocar un aumento de la laxi-
En un estudio se identificó un aumento significativo del desarrollo de displasia de cadera en perros castrados antes de los 5,5 meses de edad.7
tud de cadera en cachorros.6 Asimismo, en un estudio se identificó un aumento significativo del desarrollo de displasia de cadera en perros castrados antes de los 5,5 meses.7
Musculatura pélvica
Existe una correlación entre menor masa muscular pélvica y displasia de cadera.7 Un estudio identificó que los cachorros que caminaban por escaleras desde el nacimiento hasta los 3 meses de edad tenían una mayor incidencia de desarrollar la enfermedad. Sin embargo, se observó que realizar ejercicio temprano sin correa era un factor protector. Los autores propusieron que el ejercicio sin correa a una edad temprana pudo dar como resul-
tado un mayor desarrollo de musculatura y soporte en la cadera.8 Aun así, el papel del ejercicio como la nutrición en la expresión de la displasia de cadera continúa siendo motivo de controversia.2
Nutrición
El aumento rápido de peso, especialmente en los primeros 6 meses, es un potencial factor de riesgo para el desarrollo de displasia de cadera.4,9 Limitar el consumo de alimento un 75 % a partir de las 8 semanas de edad en perros predispuestos a displasia de cadera puede reducir un 67 % la prevalencia de displasia de cadera a los 2 años y disminuir la prevalencia y la gravedad de osteoartritis a los 5 años.10,11




Figura 2. Posicionamiento de un paciente para obtener una radiografía ventrodorsal de pelvis (2A, 2B). La radiografía es correcta cuando las alas del ilion tienen la misma apariencia y los agujeros obturadores son idénticos en forma y tamaño (2C).
Raza y tamaño
La displasia es más común en razas grandes y de rápido crecimiento, como Labradores, Golden Retrievers, Pastores Alemanes, Terranovas, Rottweilers, San Bernardos, Samoyedo y Mastines. También puede presentarse en razas más pequeñas como Bulldogs, Carlinos y algunas razas terrier.2,4,12
Signos clínicos
Los signos clínicos de la displasia de cadera son muy variables. La manifestación más típica de la displasia de cadera es el desarrollo de claudicaciones, cuya intensidad es muy variable y no tiene por qué estar correlacionada con la gravedad de cambios radiográficos. Así, mientras algunos animales no presentan casi sintomatología y tienen leves molestias en el examen ortopédico, otros animales presentan claudicaciones más graves y dolor intenso a la manipulación de las caderas. Los signos se dividen en dos categorías: forma juvenil y forma adulta o crónica. En perros jóvenes, los signos clínicos se deben principalmente al dolor producido por la laxitud de la cadera. La laxitud de la cadera produce una subluxación de la cabeza del fémur y apoyo no anatómico de esta en el acetábulo. En esta fase inicialmente no existen signos radiográficos de osteoartrosis, pero la laxitud produce una distribución de cargas incorrectas entre la cabeza femoral y





Figura 3. (A) Paciente con displasia de cadera unilateral. Se aprecia remodelación grave de la cabeza femoral y del acetábulo izquierdos, con osteofitosis en el cuello femoral y esclerosis en el acetábulo. (B) Paciente con displasia de cadera bilateral. Presenta osteofitosis en cuello femoral y en el acetábulo, así como remodelación marcada y esclerosis. (C) Paciente con displasia de cadera izquierda, presentando subluxación de la cadera sin osteoartrosis y con presencia de línea de Morgan en el cuello femoral (D) Paciente con displasia de cadera derecha, presentando ostofitosis del cuello femoral y osteofitosis circunferencial de la cabeza femoral.
el acetábulo, produciéndose una degeneración del cartílago articular y aparición progresiva de osteoartrosis. Asimismo, la laxitud produce un estiramiento de la cápsula articular con dolor asociado a la misma. Por ello, la sintomatología relacionada con esta fase de la displasia de cadera ocurre por la distensión de la cápsula articular, la remodelación/degeneración articular, la pérdida de movilidad articular y la incomodidad/dolor
dez, especialmente después de descansar o realizar actividad física intensa y pueden tener reticencia a caminar, correr o saltar.2,13
Examen físico
Se debe realizar un examen físico general, complementado con un examen ortopédico y neurológico para localizar el dolor y descartar otras patologías.2,13
El aumento rápido de peso, especialmente en los primeros 6 meses, es un potencial factor de riesgo para el desarrollo de displasia de cadera.4,9
asociado a la osteoartritis secundaria. Los signos clínicos suelen ser evidentes entre los 4 y 12 meses de edad y el inicio suele ser gradual y progresivo, aunque en ocasiones se puede observar un inicio agudo. Se puede observar una claudicación unilateral o bilateral de las extremidades posteriores, dificultad para levantase, reticencia al caminar, correr, saltar o subir escaleras o intolerancia al ejercicio. Estos signos clínicos pueden ser de aparición aguda o crónica: los animales están más afectados clínicamente cuando son de aparición aguda, ya que se cree que este dolor agudo puede estar asociado a un desgarro de la cápsula articular y estructuras de soporte, junto con microfracturas acetabulares.2,13
Conforme los perros envejecen, la tensión de la cápsula y la inflamación provocada por la laxitud articular provocan fibrosis periarticular. En esta fase de la enfermedad se puede ver una reducción o incluso ausencia de los signos clínicos.2,13, que posteriormente pueden reaparecer en la forma adulta o crónica de la enfermedad. En perros adultos, los signos suelen estar relacionados con la osteoartritis, presentando cojera, dificultad al levantarse y rigi-

En el examen ortopédico, a la marcha se puede observar una claudicación de una extremidad posterior en displasias unilaterales o cuando una cadera está significativamente más afectada que la contralateral. Como la mayoría de las displasias de cadera son bilaterales, es más frecuente observar una claudicación bilateral de las extremidades posteriores, con un balance de la columna y la cadera, andar rígido con zancadas cortas y desplazamiento del peso a los miembros torácicos extendiendo rodillas y tarsos. En frecuente observar un andar a saltos, especialmente al correr, y dificultad para subir escaleras o saltar. En pacientes jóvenes con laxitud de caderas, en ocasiones se aprecia una marcha con las extremidades posteriores más abducidas de lo normal, en un intento de corregir esa subluxación de la cadera. En la exploración de las caderas se puede apreciar dolor a la manipulación de la cadera (frecuentemente en extensión de estas) y signos de laxitud articular. Los pacientes con osteoartritis avanzada pueden presentar crepitación, disminución del rango de movimiento y atrofia muscular.2,13
Prueba de Balrow/Ortolani
En la posición lateral, una mano se coloca en el aspecto distal de la rodilla y la otra se coloca en la parte dorsal de la pelvis y la columna para proporcionar estabilización, aplicando una fuerza en dirección proximal siguiendo el axis del fémur, que provoca la subluxación dorsal de la cabeza femoral (prueba de Barlow) (figuras 1A, 1B y 1C).2,13
Tras provocar una subluxación dorsal de la cabeza femoral mediante la prueba de Barlow, se procede a abducir la extremidad manteniendo la fuerza hacia proximal del eje del fémur. En ese momento se puede escuchar y/o palpar un chasquido o golpe metálico cuando se produce una reducción abrupta de la cadera (signo de Ortolani positivo, que indica laxitud de la articulación coxofemoral) (figuras 1D, 1E y 1F).2,13
Prueba de Bardens
El método de Bardens consiste en aplicar una fuerza mediolateral al fémur proximal con una mano mientras se cuantifica el movimiento lateral del trocánter mayor con la otra. Cualquier movimiento del trocánter mayor en más de 1,25 cm sugiere laxitud de la articulación.1,12
En perros adultos, raramente se palpa un signo de Ortolani o una prueba de Bardens positiva debido a la fibrosis periarticular o remodelación del acetábulo. Los resultados del examen físico en perros mayores suelen ser consistentes con dolor crónico.2,13
Pruebas de diagnóstico por imagen
La laxitud de cadera se puede identificar en el examen clínico mediante la prueba de Barlow/Ortolani y la prueba de Bardens. Estas pruebas deben realizarse tanto en el paciente despierto como sedado o anestesiado.2,13

del porcentaje de
Las pruebas de diagnóstico por imagen son los principales métodos de diagnóstico empleados en la displasia de cadera, en particular el estudio radiográfico. Otras pruebas de imagen como la ecografía, la tomografía computarizada (TC) y la resonancia magnética (RM), han recibido atención en la literatura; sin embargo, ninguno ha demostrado tener una mejor utilidad en el diagnóstico o pronóstico de esta patología.2,13,14
Radiografías
Los posicionamientos radiológicos más utilizados incluyen la radiografía con extensión de la cadera, las radiografías con



estrés por distracción y la vista del borde acetabular dorsal (DAR).2,14 La radiografía con extensión sigue siendo el método más común para evaluar la laxitud articular y detectar signos de osteoartritis, aunque métodos adicionales como la radiografía de distracción mejoran la sensibilidad en la detección de laxitud.2,14
Para la radiografía ventrodorsal en extensión, se coloca al paciente en decúbito dorsal, extendiendo las extremidades posteriores hasta que los fémures están paralelos a la mesa de radiografía, y rotando internamente los fémures (figura 2A, 2B). Una radiografía correctamente posicionada debe incluir una pelvis simétrica, con alas del Ilion de morfología similar y agujeros obturados simétricos, fémures paralelos y completamente extendidos, y rótulas que estén centradas dentro de la tróclea femoral2,14 (figura 2C). En estas radiografías se evalúa la existencia de osteoartrosis, remodelación y laxitud articular.
La evidencia radiográfica de osteoartritis de la articulación coxofemoral incluye formación de osteofitos periarticulares femorales, esclerosis subcondral del acetábulo craneodorsal, osteofitosis a lo largo del margen acetabular y remodelación articular. Otros cambios, como la línea de Morgan y el osteofito de la cabeza femoral circunferencial, se ha observado que indican cambios radiológicos tempranos para el diagnóstico de osteoartritis (figura 3). La línea de Morgan no se debe confundir con la línea del cachorro, que es una opacidad más sutil del cuello femoral en perros jóvenes.2,14
namente las rodillas. El endurecimiento de la cápsula articular puede hacer que las caderas displásicas con laxitud (sin osteoartrosis) parezcan normales y puede ser un factor que contribuya a una alta tasa de falsos negativos.2
En los casos que se sospeche de displasia de cadera y las radiografías en extensión de cadera sean normales, se recomienda realizar radiografías de distracción-estrés, como es el método del Programa de mejora de la cadera de la Universidad de Pensilvania (PennHip), la Medición de subluxación dorsolateral (DLS) y el Índice de subluxación de Flückiger.2,14,15 Estas pruebas son ideales para casos en los que se sospecha de laxitud articular, pero no se detecta en radiografías convencionales. Asimismo, se usan estas pruebas en pacientes jóvenes con caderas radiográficamente normales para tratar de predecir la probabilidad de que desarrollen displasia de cadera en un futuro. El método más utilizado es el método PennHip.
El método de radiografía PennHip se realiza con el paciente sedado o anestesiado, obteniendo tres proyecciones radiográficas: una radiografía con extensión de cadera (figura 5A), una con compresión en fase de apoyo neutra (figura 5B) y una con distracción en fase de apoyo neutra (figura 5C). Para la radiografía de distracción, se coloca un dispositivo de punto de apoyo acrílico entre los fémures proximales y una fuerza de aducción provoca la subluxación de la cadera. A partir de la radiografía de distracción, se calcula un índice de distracción (DI) y un grado de
Una radiografía correctamente posicionada debe incluir una pelvis simétrica, con alas del Ilion de morfología similar y agujeros obturados simétricos, fémures paralelos y completamente extendidos, y rótulas que estén centradas dentro de la tróclea femoral 2,14
El grado de subluxación puede evaluarse subjetivamente o cuantificarse objetivamente utilizando el método como el ángulo de Norberg (figura 4A) y la superposición femoral (% de cobertura por el borde acetabular dorsal) (figura 4B).1,13 Un ángulo de Norberg más alto (>105º) indica una buena cobertura de la cabeza femoral por el acetábulo, mientras que los ángulos más pequeños (<105º) son consistentes con grados crecientes de subluxación.2,14 En la medición de la superposición femoral se considera normal cuando el borde acetabular dorsal cubre al menos el 50 % de la cabeza femoral. Cuando este recubrimiento es menor del 50 % indica laxitud articular.2 Hay que tener en consideración que las radiografías en extensión pueden enmascarar la subluxación articular al contraer la cápsula articular a medida que se extienden las extremidades y obligar a las cabezas femorales a asentarse más profundamente con el acetábulo al rotar inter-
subluxación de la cabeza femoral. Para calcular este índice de distracción, inicialmente se superponen las radiografías en compresión y en distracción y se mide la distancia entre el centro del acetábulo en la radiografía en compresión y el centro de la cabeza del fémur en la radiografía de distracción. Una vez obtenida esta distancia, se divide la misma entre el radio de la cabeza femoral, obteniendo así el índice de distracción. Una puntuación DI de 0 equivale a ausencia de subluxación, mientras que una puntuación DI de 1 equivale a una articulación luxada.2,15 Así, pacientes con un índice de distracción de menos de 0,3 tienen una probabilidad muy baja de desarrollar displasia de cadera al ser adultos, Por último, la proyección radiológica para evaluar la vista dorsal del reborde acetabular (DAR) se emplea para documentar el grado de daño articular en el borde acetabular.2,14 (figura 6)

Tomografía computarizada
La tomografía computarizada (TC) permite una evaluación tridimensional precisa y una medición más exacta de los índices articulares mientras el animal está colocado en una posición de carga de peso, lo que puede ser un mejor indicador del grado de laxitud funcional.14 Es muy poco común realizar esta prueba diagnóstica en perros con displasia de cadera.
Artroscopia
Aunque es poco frecuente, la artroscopia se puede usar como una herramienta de diagnóstico para mejorar la evaluación
Bibliografía:



de la superficie del cartílago articular antes de la cirugía y ayudar a decidir la mejor opción terapéutica.2,13
Conclusión
La displasia de cadera en perros es una patología multifactorial que combina predisposición genética y factores ambientales. El diagnóstico temprano, basado en la identificación de signos clínicos y pruebas de imagen adecuadas, es crucial para el tratamiento de esta patología y establecer un tratamiento adecuado, mejorando la calidad de vida del animal.
1. Henricson B, Norberg I, Olsson SE. On the etiology and pathogenesis of hip dysplasia: a comparative review. J Small Anim Pract 1966, 7: 673-688.
2. Smith G. K., Leighton E. A, Karbe G. T., McDonald-Lynch M. B. Chapter 58: Pathogenesis, Diagnosis, and Control of Canine Hip Dysplasia. En: Veterinary Surgery Small Animal (Vol. 1). Tobias KM, Johnston SA. (eds).St. Louis, Missouri. Elsevier.2012
3. N A van der Velden N.A., Hip dysplasia in dogs. Veterinari Quarterly; 2014 DEC, 01:14
4. King M.D., Etiopathogenesis of Canine Hip Dysplasia, Prevalence, and Genetics. Vet Clin North Am Small Anim Pract. 2017 Jul;47(4):753767.
5. Harper T.A., Butler J.R.,Hip Dysplasia: Where Are We Now and How Do We Treat? Vet Clin North Am Small Anim Pract. 2017 Jul;47(4):xi-xii.
6. Pierce K.R., Bridges C.H., The role of estrogens in the pathogenesis of canine hip dysplasia: metabolism of exogenous estrogens. J Small Anim Pract. 1967 Jul. 8:383, 1967.
7. Spain C, Scarlett J, Houpt K. Long-term risks and benefits of early-age gonadectomy in dogs. J Am Vet Med Assoc 2004;224:380–7.
8. Krontveit RI, Nødtvedt A, Sævik BK, et al. Housing- and exercise-related risk factors associated with the development of hip dysplasia as determined by radiographic evaluation in a prospective cohort of Newfoundlands, Labrador retrievers, Leonbergers, and Irish wolfhounds in Norway. Am J Vet Res 2012; 73:838–46.
9. Fries CL, Remedios AM. The pathogenesis and diagnosis of canine hip dysplasia: a review. Can Vet J 1995;36(8):494–502.
10.Kealy RD, Olsson SE, Monti KL, et al. Effects of limited food consumption on the incidence of hip dysplasia in growing dogs. J Am Vet Med Assoc 1992;201: 857–63.
11.Kealy RD, Lawler DF, Ballam JM, et al. Five-year longitudinal study on limited food consumption and development of osteoarthritis in coxofemoral joints of dogs. J Am Vet Med Assoc 1997;210:222–5.
12.Smith GK et. Al., Evaluation of risk factors for degenerative joint disease associated with hip dysplasia in German Shepherd Dogs, Golden Retrievers, Labrador Retrievers, and Rottweilers. J Am Vet Med Assoc. 2001 Dec 15;219(12):1719-24.
13.Syrcle J., Hip Dysplasia: Clinical Signs and Physical Examination Findings. Vet Clin North Am Small Anim Pract. 2017 Jul;47(4):769-775.
14.Butler JR, Gambino J., Canine Hip Dysplasia Diagnostic Imaging. Vet Clin North Am Small Anim Pract. 2017 Jul;47(4):777-793.
15.Haney PS, et. Al., Effectiveness of PennHIP and Orthopedic Foundation for Animals measurements of hip joint quality for breeding selection to reduce hip dysplasia in a population of purpose-bred detection dogs. J Am Vet Med Assoc. 2020 Aug 1;257(3):299-304.
El principal objetivo de la cirugía es reducir en lo posible la subluxación y estabilizar la articulación. Las técnicas posibles son la estabilización dorsal, menos utilizada, o la estabilización ventral, que puede ir combinada con odontectomía.
Sergio Ródenas González†1, Juan Jesús Sánchez Nuez2
1Ldo.Vet, Dipl ECVN, MRCVS, CPAR, EBVS
2Ldo. Vet. Clínica Veterinaria La Rambla de Siete Palmas. Miembro de NEUROPET y del GTA Neurología y Neurocirugía
Imágenes cedidas por los autores.
El tratamiento quirúrgico de la subluxación atlantoaxial (SAA) en la mayoría de los casos es el de elección. Hay diversos estudios y técnicas descritas. 19-23
El principal objetivo es reducir en lo posible la subluxación y estabilizar la articulación.
Las técnicas para el tratamiento quirúrgico de la SAA incluyen la estabilización dorsal (menos utilizada) o la estabilización ventral, que puede ir combinada con odontectomía en función del caso. La técnica dependerá normalmente de cada caso específico, así como de la preferencia del cirujano.
Técnicas de estabilización dorsal
La estabilización dorsal de la SAA ha sido descrita en diferentes artículos. Generalmente, no es la técnica de elección para la mayoría de los autores por diferentes motivos: abordaje dorsal más agresivo; está asociada a mayor morbilidad por mayor riesgo de seromas o dolor posoperatorio, no ofrece visualización de la alineación de la articulación ventralmente; no se consigue una fusión ósea; mayor riesgo de fallo en los implantes. 19-22


Sin embargo, puede estar especialmente indicada en perros de razas toy jóvenes (< 6-8 meses), en los que la inmadurez del esqueleto desaconseja colocar implantes, o en animales de menos de 2 kg debido al reducido tamaño del hueso para poner implantes ventrales. 9, 10
Se han descrito varias técnicas para conseguir la fijación del arco dorsal
La estabilización dorsal puede estar especialmente indicada en perros de razas toy jóvenes o en animales de menos de 2 kg.
del atlas y la apófisis espinosa del axis, por ejemplo, la utilización de cerclajes (figuras 1A y 2); de sutura sintética no reabsorbible; usando el ligamento nucal; mediante agujas de Kirschner sujetas con polimetilmetacrilato (PMMA) (figura 1B); aplicando retractores metálicos atlantoaxiales; o con ayuda de una banda de tensión atlantoaxial Kishigami (figuras 1C y 3). 9, 10, 24-28
Recientemente, se han aplicado técnicas de fijación dorsal con tornillos y PMMA como alternativas a la estabilización ventral. Dichas técnicas han mostrado muy buenos resultados utilizando diferentes corredores para la inserción de implantes en el axis y el atlas (figura 1D). 29,30
Las mayores complicaciones se producen por fallos en los implantes, fracturas del atlas y por el daño medular iatrogénico al pasar el implante a través del canal espinal del atlas (p. ej.: una sutura no reabsorbible o el cerclaje). Para evitar este inconveniente se utiliza la banda de tensión de Kishigami que no atraviesa el atlas (figuras 1C y 3) o técnicas de fijación dorsal con agujas de Kirschner sin pasar el atlas. 27,28
Técnicas de estabilización ventral
La estabilización ventral o artrodesis de la articulación es la técnica más utilizada en el tratamiento de la inestabilidad o SAA, principalmente debido a mejores resultados en los estudios, a un abordaje más fácil y a que se favorece la anquilosis y fusión con la artrodesis de la articulación.
La estabilización ventral de la SAA se ha descrito mediante el uso de tornillos o clavos transarticulares; aplicando tornillos, agujas o clavos con o sin PMMA; y mediante el uso de placas, generalmente bloqueadas, con tornillos. En algunos casos, estas técnicas se pueden asociar a una odontectomía (fracturas o no unión del diente) o a una descompresión por hemilaminectomía. 19-22, 31-40

operado al que se colocó una banda de tensión de Kishigami. Imagen cortesía de Alex Martínez.
Figura 4. Representación de posicionamiento de implantes atlantoaxiales (AA) óptimos y los márgenes de seguridad asociados. Numeración de los implantes óptimos basada en la localización anatómica. 0-1 ¼ pedículo C1; 2-3 ¼ transarticular C1-C2; 4-5 ¼ superficie articular craneal C2; 6-7 ¼ pedículo C2; 8-9 ¼ cuerpo vertebral caudal C2 (parasagital); 10 ¼ arco ventral C1; 11 ¼ cuerpo vertebral craneal C2; 12 ¼ cuerpo vertebral caudal C2 (sagital); 0, 2, 4, 6, 8 ¼ lado derecho; 1, 3, 5, 7, 9 ¼ lado izquierdo (adaptación de Leblond et al. 2017).
Abordaje y reducción
Sea cual sea el tipo de implante o fijación ventral aplicado, en primer lugar, se procede al abordaje a la articulación y a la reducción de la luxación.
El animal se coloca en decúbito dorsal con la cabeza y el cuello extendidos. Se realiza una incisión ventral en la línea

media desde aproximadamente C1 a C4. El músculo esternohioideo se divide a lo largo de su rafe medio fibroso mediante disección roma que continúa a lo largo de la línea media hasta la tráquea. El músculo esternotiroideo se incide a 2 cm de su unión al cartílago tiroides y se repara, si es posible, tras la cirugía. Se identifican la vaina carotídea, el nervio laríngeo recurrente y el esófago. La tráquea, el esófago, la vaina carotídea, el tronco vagosimpático y el nervio laríngeo recurrente se retraen hacia el lado izquierdo del perro para exponer los músculos largos del cuello. Se inciden estos músculos y se colocan retractores Gelpi para visualizar las vértebras C1 a C3. Se procede a la desperiostización muscular para exponer las caras ventrales de C1 hasta C3. Una vez expuestas, se procede a retirar el cartílago articular de las superficies articulares de C1 y C2 (habitualmente se realiza con una cureta de House, bisturí, motor neumático o con gubias para favorecer la artrodesis). 19-21
A continuación, se procede a la reducción de la luxación mediante diferentes métodos:19-21, 32, 38
• con un retractor de Hohmann aplicado a nivel de C2;
• con una cureta de House utilizándola como palanca contra la cara craneal de la superficie articular caudal del atlas;
• mediante un retractor Gelpi colocado en la fisura intercondilar del hueso occipital y en C2-C3;
• colocando un tornillo en el cuerpo de C2, como anclaje que luego formará parte de la reconstrucción con tornillos y PMMA;
• con pinzas de reducción (el autor utiliza generalmente este método).


Figura 7. Posicionamiento de implantes con clavos roscados transarticulares en C1-C2 uniendo las alas del atlas y las apófisis transversas de C2 y aplicación de PMMA en otro paciente. Imágenes intraoperatorias (A y B). Radiografias posoperatorias que muestran los implantes colocados (C y D).
Se ha descrito también un abordaje modificado con el objetivo de evitar la manipulación de estructuras como la tráquea, el esófago, el tronco vagosimpático y los vasos tiroideos. Se realiza a través de los músculos esternocefálico derecho y esternotiroideo. Este abordaje ofrece una


buena exposición quirúrgica; requiere una disección menor; proporciona protección a las estructuras vitales durante la colocación de los dispositivos de fijación; y puede preservar mejor la arteria tiroidea.41
Técnicas con colocación de tornillos o clavos transarticulares
La colocación de tornillos o clavos fue una de las primeras técnicas en utilizarse y es de las más simples. Consiste en realizar una artrodesis con dos tornillos o clavos transarticulares dirigidos aproximadamente en un ángulo de 30° desde la línea media (figura 4). Esta técnica no es la más adecuada si solo se aplican los clavos, ya que se ha descrito la migración de implantes o la falta de fusión de la articulación, por lo que es preferible una construcción con más implantes. 19-31
Técnicas con construcción de implantes para los cuerpos de C1 y C2 y aplicación de tornillos o clavos transarticulares y PMMA
Se han descrito diversos estudios y diferentes técnicas de posicionamiento de implantes (tornillos y clavos) con PMMA que analizan los resultados del uso de diferentes corredores para la colocación de los implantes. Concretamente, hay un trabajo de 2017 realizado en perros, en el que se analizaron mediante TC los diferentes corredores para el posicionamiento de implantes más seguros. Las diferentes trayectos se muestran en la figura 4 42
El tamaño de los clavos o tornillos es variable y depende del tamaño del animal. Generalmente, el autor determina las medidas con ayuda de la TC (figura 5A).
Figura 5. Diferentes tipos de posicionamiento de implantes y corredores. Técnica de tornillos transarticulares (A) y representación de la colocación de tornillos transarticulares entre el atlas y el axis reforzada con clavos de Steinman en el cuerpo y PMMA (área sombreada) (B).




El riesgo de migración de implantes se puede reducir mediante tornillos o clavos de rosca positiva con implantes en forma de lag o con PMMA.


Figura 6. Secuencia de imágenes correspondientes al abordaje, reducción y posicionamiento de implantes con clavos roscados, PMMA, y refuerzo con implantes también en C3 en un paciente con luxación atlantoaxial. Abordaje ventral en el que se observa la tráquea, el tronco vagosimpático, la vaina carotídea y el músculo esternohiodeo seccionado (A). Imagen de los músculos largos del cuello desde C1 a C3 tras retraer los tejidos con retractores Gelpi (B). Disección roma de los músculos largos y reducción de la luxación con pinzas de reducción de fragmentos que queda fijada mediante la inserción de un clavo roscado transarticular (C). Posicionamiento de implantes transarticulares en el atlas, en C2 y en C3, en las apófisis transversas, dirigidos hacia fuera o lateralmente para evitar el canal vertebral (D). Aplicación del PMMA sobre los implantes (E).
El autor generalmente utiliza una variación de la técnica descrita por Sanders et al. (2004) 32 en la que se ponen tornillos transarticulares entre el atlas y el axis que se refuerzan mediante clavos de Steinmann, un cerclaje y PMMA (figura 5B).
Técnica quirúrgica
La técnica consiste en el posicionamiento de implantes (tornillos o clavos con rosca positiva) del siguiente modo: dos en el atlas, dos transarticulares y dos en el cuerpo del axis (esta disposición puede variar en función del animal, de la malformación de la superficie articular craneal del axis o del tamaño del axis).
Una vez reducida la luxación, se procede a poner en primer lugar los implantes transarticulares (clavos roscados o tornillos) desde la línea media vertebral con un ángulo aproximado de 35-40°. En el caso de aplicar tornillos, habitualmente se taladra antes con una broca y la reducción transarticular se puede hacer con agujas de Kirschner. A continuación, se colocan otros dos implantes (clavos o tornillos) en la parte medial de las alas del atlas, caudales al agujero transverso, en dirección caudolateral con un ángulo aproximado de 30-40° para evitar que el implante alcance el canal vertebral. El último par de implantes (tornillos o clavos) se coloca en la base de las apófisis transversas de C2 (en algunos casos, según la anatomía de esta vértebra se pueden poner en la base de las apófisis transver-
Entrevista a Carlos Bustillo, veterinario clínico. Desparasitación externa anual
El cambio climático y los movimientos de las mascotas hacen que nuestros pacientes puedan entrar en contacto con estos peligrosos vectores durante todo el año, lo que obliga a una prevención anual. Para Carlos Bustillo, veterinario clínico, no tiene sentido bajar la guardia durante determinados meses. Solo con una correcta desparasitación anual se puede obviar esta problemática.

Dr. Carlos Bustillo
Veterinario clínico e investigador, experto en medicina interna, dermatología y oncología en Bustillo Servicios Veterinarios
¿Cuál es tu opinión sobre la importancia de desparasitar a los perros frente a pulgas y garrapatas?
La desparasitación externa es un área fundamental de trabajo dentro de la clínica. Un buen plan de trabajo previene las enfermedades, y eso es tremendamente importante, ya que algunas de las enfermedades que transmiten estos parásitos pueden llegar a ser muy graves. Nuestros clientes nos reclaman un plan de prevención efectivo en sus perros, ya que no desean verlos enfermos, o pasando por patologías que han podido evitarse. Además, nosotros, los veterinarios, somos una pieza clave en el enfoque de la salud como One Health, en el que somos protagonistas en primera persona, cuidando la interacción animal-humanos-medio ambiente. No debemos olvidar que algunas de estas enfermedades son zoonóticas y cuando la interacción entre familias y mascotas es tan estrecha, resulta clave mantener en un control estricto los parásitos externos como vectores.
“Nuestros clientes nos reclaman un plan de prevención efectivo en sus perros, ya que no desean verlos enfermos, o pasando por patologías que han podido evitarse”.
¿Cómo están influyendo los factores climáticos y estacionales en la prevalencia
y el riesgo de infestación por parásitos externos en perros?
Debemos abandonar algunos mitos que arrastramos en nuestra comunicación con las familias de mascotas, entre ellos que los parásitos externos son estacionales. No solamente no es cierto, sino que además genera unas expectativas en los tutores en cuanto a prevención totalmente incorrectas. El cambio climático y los movimientos de las mascotas hacen que nuestros pacientes puedan entrar en contacto con estos peligrosos vectores durante todo el año, lo que obliga a una prevención anual. No tiene sentido bajar la guardia durante determinados meses, ya que la estacionalidad está desapareciendo. Cada vez más, vemos patologías relacionadas con los parásitos externos en épocas que antes ni sospechábamos, y que obligan a que la prevención sea anual. Antes no pensábamos en determinadas enfermedades según nuestra área geográfica y ahora debemos tener una visión mucho más amplia, ya que apoyándonos en los estudios epidemiológicos podemos apreciar un aumento de las seroprevalencias en todas las áreas del país.
¿Cuáles son los beneficios de asegurar la desparasitación externa de forma constante durante los 12 meses del año teniendo en cuenta estos cambios en los factores climáticos?
En la clínica como profesionales expertos que somos, debemos garantizar la adecuada protección de los perros todo el
año, solo de esa manera podemos garantizar a sus tutores que van a estar sanos y libres de enfermedad con una adecuada protección, y sobre todo que puedan disfrutar de una vida al aire libre segura, tanto en sus paseos como en sus desplazamientos a distintas áreas del país o entre países. El beneficio es claro: mantener a nuestros pacientes libres de enfermedades trasmitidas por pulgas y garrapatas. La estacionalidad está desapareciendo, es un hecho incontestable y, con los datos epidemiológicos de los que disponemos, solo con una correcta desparasitación externa anual permite proteger frente a estos parásitos. Además, las pulgas no son solo un parásito sin más, en muchos casos de perros alérgicos acrecientan los problemas de picor e infecciones de piel y esto es algo que vemos en la clínica en muchas de nuestras consultas durante todo el año.
¿Supongo que en tu larga trayectoria habrás tenido experiencia con casos de

enfermedades transmitidas por vectores en perros? ¿Qué te ha aportado tu experiencia que estés poniendo en práctica en la actualidad?
Desgraciadamente he diagnosticado estas enfermedades en muchos perros, muchas veces por una inadecuada protección. Son cuadros clínicos en algunos casos muy serios, crónicos y que requieren de tratamientos intensivos con afectación de los pacientes de modo grave. Muchos de ellos requieren de controles durante mucho tiempo.
Cuando realizamos las campañas de detección de enfermedades transmitidas por garrapatas encontramos perros urbanos seropositivos a Anaplasma, Ehrlichia y otros patógenos en animales asintomáticos, pero que pueden poner en riesgo su vida en algún momento.
Para evitarlo, en nuestro centro hemos diseñado un plan específico de prevención de parásitos externos con una prevención

DINÁMICA ESTACIONAL DE PULGAS
C. felis es la especie de pulga más frecuente y abundante, y está asociada a varias enfermedades, incluidas parasitosis internas y dermatitis alérgica por picadura de pulgas (DAPP).
C. felis
C. canis
P. irritans



durante todo el año, con el que las familias de mascotas se sienten muy satisfechas por la tranquilidad de saber que su perro está perfectamente protegido de modo efectivo y seguro. Hemos abandonado todos los mitos de la estacionalidad, la prevención solo en perros de áreas rurales o que salen más activamente, para entrar en una dimensión más moderna acorde con lo que nuestros propios clientes demandan: una protección integral en sus perros.
“Hemos abandonado todos los mitos de la estacionalidad, la prevención solo en perros de áreas rurales o que salen más activamente, para entrar en una dimensión más moderna acorde con lo que nuestros propios clientes demandan: una protección integral en sus perros”.
¿Cuáles serían las medidas de prevención más efectivas para evitar la transmisión de enfermedades vectoriales en perros y proteger tanto a los animales como a sus familias?
Cada centro debería disponer de un plan de prevención de parásitos externos, bien comunicado a todo el personal del centro, apoyándose en las herramientas necesarias para convertir a su cliente en el centro de la
toma de decisiones, junto con su veterinario. La medida más efectiva sin duda es la prevención anual. Hoy en día disponemos de recursos de tratamiento que nos permiten garantizar esa prevención anual de modo efectivo y seguro. A partir de esa prevención se pueden ir añadiendo más modalidades de prevención para otras enfermedades, como aquellas transmitidas por mosquitos y flebotomos para acudir a un control integral.
“La medida más efectiva sin duda es la prevención anual. Hoy en día disponemos de recursos de tratamiento que nos permiten garantizar esa prevención anual de modo efectivo y seguro”.
¿Qué papel crees que juega la clínica veterinaria como garante de la salud de los animales y de sus familias en la prevención de enfermedades transmitidas por parásitos externos?
La clínica veterinaria debe ser el lugar en donde las familias de mascotas encuentren toda la información y los recursos necesarios para poder garantizar la prevención de las enfermedades vectoriales. Cuando acuden a otros canales –tiendas, online, farmacias-, es porque no han encontrado en nuestros centros el apoyo y la información necesaria.

D. reticulatus
I. hexagonus
I. ricinus
R. sanguineus
NA: muestras negativas.
Los pacientes deben tener un plan de prevención de enfermedades parasitarias e infecciosas bien organizado dentro de su historial clínico. Tenemos que creer en nuestro poder como clínicos ante nuestros clientes, el lazo que se forma entre el veterinario y el tutor es muy fuerte y debemos de ir de la mano para garantizar la salud de los perros que son nuestros pacientes.
Cuando hacemos nuestras consultas de vacunas, es la oportunidad en un clima posi-

“Tenemos que creer en nuestro poder como clínicos ante nuestros clientes, el lazo que se forma entre el veterinario y el tutor es muy fuerte y debemos de ir de la mano para garantizar la salud de los perros que son nuestros pacientes”.

tivo de relación con el tutor para repasar cómo se encuentra al día en su programa preventivo, informando sobre los riesgos, y las medidas a adoptar para asegurar que reciben una correcta y sobre todo profesional información.
¿Cómo consideras que la desparasitación externa constante durante todo el año puede contribuir a la rentabilidad de la clínica veterinaria?
La despasitación externa constante es parte clave de nuestros ingresos. Por eso debemos trabajar con todas las herramientas que tenemos para mejorar esta parte fundamental de nuestro trabajo. Ello revertirá en un aumento importante de nuestros ingresos. Si dedicamos el tiempo suficiente en cada consulta a nuestros pacientes, podemos incrementar las ventas de modo proporcional.
Debemos recuperar nuestra ilusión e interés por la medicina preventiva en nuestras clínicas proporcionando consultas de calidad, en la que nuestros clientes sientan que hacemos todos los esfuerzos posibles por prevenir las enfermedades en su animal. Solo así conseguiremos que vuelva la medicina preventiva a nuestros centros: con atención de calidad y herramientas eficientes y seguras que se merecen nuestros pacientes y sus familias.

“Debemos recuperar nuestra ilusión e interés por la medicina preventiva en nuestras clínicas proporcionando consultas de calidad, en la que nuestros clientes sientan que hacemos todos los esfuerzos posibles por prevenir las enfermedades en su animal. Solo así conseguiremos que vuelva la medicina preventiva a nuestros centros: con atención de calidad y herramientas eficientes y seguras que se merecen nuestros pacientes y sus familias”.





Aplicación de tornillos. En el atlas se aprecia el posicionamiento de implantes dirigidos craneolateralmente; los tornillos transarticulares y los tornillos colocados en la base de las apófisis transversas del axis están dirigidos de igual modo hacia fuera del canal vertebral (A). Radiografía lateral para mostrar los implantes con PMMA (B). Tornillos reforzados con una banda de tensión, clavos y cerclajes (otra variación) (C).








sas de C3 o en ambas). Estos implantes van dirigidos lateralmente a 30-40° de la línea media, para evitar el canal vertebral y no lesionar la médula espinal.
Una vez colocados los implantes, el autor pone el PMMA. Se puede reforzar esta estructura con clavos de Steinmann alrededor de los implantes con cerclajes y del PMMA (figuras 6, 7 y 8).
Placas bloqueadas
La colocación de placas ventrales es menos frecuente y hay menos estudios descritos que en el caso del uso de tornillos o clavos y PMMA, probablemente debido a la falta de disponibilidad de tamaños de placas para este tipo de patología; 37,39,43 no obstante, ya se están haciendo placas a medida a partir de los resultados observados en la TC y de las características anatómicas del animal, lo cual soluciona el problema. El uso de placas bloqueadas en mariposa con 4 o 5 orificios, que tratamos en el apartado siguiente, se ha descrito en varios casos con buenos resultados (concretamente, el autor realizó dos estudios, con 3 y 10 perros, en los que obtuvo resultados positivos). 37,39
Técnica con placas bloqueadas en mariposa
El abordaje ventral es el mismo que el descrito anteriormente y se procede de igual modo para reducir la luxación y retirar el cartílago articular.
La fijación se realiza con una placa bloqueada en mariposa (generalmente de 1,5-2 mm) de 4 o 5 orificios para realizar la artrodesis de la articulación. La placa puede requerir o no un precontorneado. El procedimiento es el siguiente: se colocan en la parte craneal de la placa en mariposa dos tornillos corticales de bloqueo autorroscantes que se fijan a la base de las alas del atlas y otros dos tornillos en el cuerpo del axis en un ángulo de aproximadamente 10° con respecto a la perpendicular del cuerpo. Estas placas son poliaxiales, de manera que permiten replicar el ángulo de unos 10°. De esta manera, en función de la posición de la placa se pueden angular los tornillos para evitar siempre el canal vertebral (figura 9). La reducción se puede reforzar en ocasiones con agujas de Kirschner transarticulares, además de la placa.
Técnica con placa bloqueada de titanio moldeable con modelos 3D El uso de modelos impresos en plástico 3D es de gran ayuda para colocar implantes (clavos o tornillos con PMMA o placas) y realizar las guías antes de la cirugía. 44,45 Los modelos de placas bloqueadas a medida impresas en 3D permiten planificar la cirugía a partir de un modelo, en el que se puede analizar antes de la cirugía la medida de los tornillos, así como realizar las diferentes guías necesarias. El estudio se planifica en el análisis TC y se prueba en el modelo de plástico. Las placas de titanio son placas que se pueden contornear o no y tienen diferentes orificios (de 4 a 6). Habitualmente, se utilizan entre 2 y 4 tornillos bloqueados en el atlas y de 2 a 4 en el axis, de forma divergente para evitar el canal vertebral (figuras 10 y 11).
Consideraciones sobre el tratamiento quirúrgico
La tabla 1 muestra los principales abordajes o técnicas descritas en diferentes estudios para el tratamiento de inestabilidad o subluxación atlantoaxial. 8-10


Figura 11. Radiografías posoperatorias correspondientes a una reducción de luxación mediante una placa bloqueada de 6 orificios. Imagen cortesía de Joseba Del Valle.
Las principales complicaciones que se pueden presentar en estos casos son similares a las descritas en las complicaciones del slot ventral (posible deterioro neurológico, fallo o migración de los implantes, dolor recurrente, fractura iatrogénica, infección, hemorragias u otras).
Este artículo es un extracto de la obra Neurocirugíaen el perro y el gato
Disponible en https://ediciones edra.com/ Tel.: 976 461 480
Bibliografia

1. Hansen SC, Bacek LM, Kuo KW, Taylor AR. Traumatic atlantoaxial subluxation in dogs: 8 cases (2009-2016). J Vet Emerg Crit Care (San Antonio), 2019 May;29(3):301308.
2. Stalin C, Gutierrez-Quintana R, Faller K, et al. A review of canine atlantoaxial joint subluxation. Vet Comp Orthop Traumatol., 2015;28(1):1-8.
3. Sánchez-Masian D, Luján-Feliu-Pascual A, Font C, Mascort J. Dorsal stabilization of atlantoaxial subluxation using non-absorbable sutures in toy breed dogs. Vet Comp Orthop Traumatol., 2014;27(1):62-67.
4. Sharp NJ, Wheeler SJ. Atlantoaxial subluxation. In: Sharp NJ, Wheeler SJ. (eds). Small Animal Spinal Disorders, Diagnosis and Surgery. 2nd ed. Elsevier Mosby, 2005; p. 161-180.
5. Wininger F. Atlantoaxial subluxation. In: Shores A, Brisson BA. (eds). Current Techniques in Canine and Feline Neurosurgery, 1st ed. John Wiley and Sons, 2017; p. 442-461.
6. Platt SR, da Costa RC. Cervical Vertebral Column and Spinal Cord. In: Johnston SA, Tobias KM. Veterinary Surgery: Small Animal. 2nd ed. Elsevier, 2018; p. 438-485.
7. Dewey CW and Fossum TW. Surgery of the Cervical Spine. In: Fossum TW (ed). Small Animal Surgery, 5th ed. Philadelphia, PA. Elsevier, 2019; p. 1365-1404.
8. Shires PJ. Atlantoaxial conditions and Wobbler syndrome. In: Slatter DH (ed). Textbook of Veterinary Surgery, 3rd ed. Philadelphia, PA: Saunders, 2003; p. 1173-1193.
9. Denny HR, Gibbs C, Waterman A. Atlanto-axial subluxation in the dog—a review of 30 cases and an evaluation of treatment by lag screw fixation. J. Small Anim. Pract., 1988;29:37-47.
10. Jeffery, N.D. Dorsal cross pinning of the atlantoaxial joint: New surgical technique for atlantoaxial subluxation. J. Small Anim. Pract., 1996;37:26-29.
11. LeCouteur RA, McKeown D, Johnson J, Eger CE. Stabilization of atlantoaxial subluxation in the dog, using the nuchal ligament. J. Am. Vet. Med. Assoc., 1980;177: 1011-1017.
12. Pujol E, Bouvy B, Omaña M, et al. Use of the Kishigami Atlantoaxial Tension Band in eight toy breed dogs with atlantoaxial subluxation. Vet Surg., 2010 Jan;39(1):35-42.
13. Dongwook K, Seoungjin L, Gonhyung k. Application of a Modified Dorsal Wiring Method in Toy Breed Dogs With Atlantoaxial Subluxation. In Vivo, 2023 JanFeb;37(1):247-251.
14. Tabanez J, Gutierrez-Quintana R, et al. Evaluation of a Novel Dorsal-Cemented Technique for Atlantoaxial Stabilisation in 12 Dogs. Life (Basel), 2021 Oct 2;11(10):1039.
15. Dolera M, Malfassi L, Pavesi S, et al. Computed tomography, magnetic resonance imaging and a novel surgical approach of atlanto-axial instability with incongruence in dogs. J. Vet. Med. Sci., 2017. DOI: 10.1292/ jvms.16-0077.
16. Beaver DP, Ellison GW, Lewis DD, et al. Risk factors affecting the outcome of surgery for atlantoaxial subluxation in dogs: 46 cases (1978-1998). J Am Vet Med Assoc., 2000 Apr 1;216(7):1104-1109.
17. Sanders SG, Bagley RS, Silver GM, et al. Outcomes and complications associated with ventral screws, pins, and polymethyl methacrylate for atlantoaxial instability in 12 dogs. J Am Anim Hosp Assoc., 2004 MayJun;40(3):204-210.
18. Stout Steele MW, Hodshon AW, Hopkins AL, et al. Multi-Center Retrospective Evaluation of Screw and Polymethylmethacrylate Constructs for Atlantoaxial Fixation in Dogs. Vet Surg., 2016 Oct;45(7):909-915.
19. Thomas WB, Sorjonen DC, Simpson ST. Surgical management of atlantoaxial subluxation in 23 dogs. Vet Surg., 1991; 20: 409-412.
20. Pike FS, Kumar MS, Boudrieau RJ. Reduction and fixation of cranial cervical fracture/luxations using screws and polymethylmethacrylate (PMMA) cement: a distraction technique applied to the base of the skull in thirteen dogs. Vet Surg., 2012 Feb;41(2):235-247.
21. Forterre F, Vizcaino Revés N, Stahl C, et al. An indirect reduction technique for ventral stabilization of atlantoaxial instability in miniature breed dogs. Vet Comp Orthop Traumatol., 2012;25(4):332-336.
22. Hidalgo E, Frias C, Merino JL, Rodenas S. A retrospective review of 10 cases with follow up of atlantoaxial luxation using 2.0 mm pax locking butterfly titanium plate for ventral fixation of atlantoaxial instability in dogs. Annual Symposium of the ESVN-ECVN, Helsinki (Finland), September 2017.
23. Platt SR, Chambers JN, Cross A. A modified ventral fixation for surgical management of atlantoaxial subluxation in 19 dogs. Vet Surg., 2004 JulAug;33(4):349-354.
24. Dickomeit M, Alves L, Pekarkova M, et al. Use of a 1.5 mm butterfly locking plate for stabilization of atlantoaxial pathology in three toy breed dogs. Vet Comp Orthop Traumatol., 2011;24(3):246-251.
25. Aikawa T, Shibata M, Fujita H. Modified ventral stabilization using positively threaded profile pins and polymethylmethacrylate for atlantoaxial instability in 49 dogs. Vet Surg., 2013 Aug;42(6):683-692.
26. Shores A, Tepper LC. A modified ventral approach to the atlantoaxial junction in the dog. Vet Surg 2007;36:765-770.
27. Leblond G, Gaitero L, Moens NMM, et al. Computed Tomographic Analysis of Ventral Atlantoaxial Optimal Safe Implantation Corridors in 27 Dogs. Vet Comp Orthop Traumatol., 2017 Nov;30(6):413-423.
28. Stead AC, Anderson AA, Coughlan A. Bone plating to stabilize atlantoaxial subluxation in four dogs. J Small Anim Pract., 1993;34:462-465.
29. Toni C, Oxley B, Behr S. Atlanto-axial ventral stabilisation using 3D-printed patient-specific drill guides for placement of bicortical screws in dogs. J Small Anim Pract., 2020 Oct;61(10):609-616.
30. Kamishina H, Sugawara T, Nakata K, et al. Clinical application of 3D printing technology to the surgical treatment of atlantoaxial subluxation in small breed dogs. PLoS One, 2019 May 3;14(5):e0216445. doi: 10.1371.

Las ventajas de la técnica artroscópica frente a la abierta (artrotomía) son varias, entre las cuales destaca la disminución del trauma quirúrgico, de los tiempos de anestesia y de los periodos de recuperación tras el procedimiento.
La artroscopia es una de las técnicas de mínima invasión cuyo uso más ha crecido en veterinaria durante las últimas décadas. Se trata de la técnica de elección tanto de diagnóstico como de tratamiento de diversas patologías articulares, así como un medio de apoyo en otras intervenciones de traumatología y ortopedia. Concretamente en este trabajo nos centraremos en el uso de la artroscopia en las principales patologías de hombro y codo en la especie canina.
La técnica artroscópica
El término artroscopia se refiere al acceso endoscópico a una cavidad articular. Se trata de un procedimiento quirúrgico mínimamente invasivo practicado con un endoscopio rígido, que en el caso de los pequeños animales suele presentar un diámetro de entre 1,9 y 2,7 milímetros. Las ventajas frente a las técnicas abiertas (artrotomía) son varias, entre las cuales destaca la disminución del trauma quirúrgico, de los tiempos de anestesia y de los periodos de recuperación tras el procedimiento. Además, permite una mejor visualización de las estructuras intraarticulares debido al efecto de magnificación de la imagen artroscópica. Otra ventaja significativa es la reducción del daño iatrogénico del cartílago articular en comparación con la artrotomía. Respecto a sus desventajas, son pocas y cabe nombrar la dificultad técnica y el coste económico del material y procedimiento, aunque dichas razones han ido perdiendo fuerza durante los últimos años debido al aumento progresivo del tiempo y calidad de formación de los especialistas. Desde un punto de vista general, la artroscopia en pequeños animales está indicada para la exploración de las articulaciones con propósito de diagnóstico, toma de muestras de tejido, retirada de estructuras, tratamiento de la superficie articular, desbridamiento y lavado articulares, y método de apoyo en estabilizaciones de fracturas articulares.

Artroscopia en hombro
El hombro está conformado por la fosa glenoidea de la escápula y la cabeza humeral, y es una articulación con un gran rango de movimiento. La artroscopia en hombro tiene una amplia utilidad, y se emplea principalmente en lesiones por osteocondrosis, tendinopatías bicipitales y, en inestabilidades mediales de hombro. A continuación, realizamos una breve descripción de su uso principal en hombro.
Osteocondrosis
Se trata de un defecto en el proceso normal de osificación endocondral del hueso subcondral del húmero proximal, que desemboca en la rotura del cartílago articular formándose “flaps” o colgajos de cartílago, punto en el que la enfermedad pasa a llamarse osteocondritis disecante (figura 1). Afecta principalmente a perros jóvenes de raza grande y gigante que empiezan a mostrar signos clínicos entre los 4 y los 8 meses de edad. Su diagnóstico se suele llevar a cabo mediante radiografías, que han de hacerse en ambas extremidades debido a que la presentación suele ser bilateral, aunque la tomografía computarizada ha mostrado una mayor sensibilidad que la radiografía. La artroscopia es de gran utilidad tanto en su diagnóstico como en su tratamiento, que se pueden realizar simultáneamente.


con el material quirúrgico por otro caudal.
La artroscopia permite la visualización de zonas anatómicas que no son visibles mediante artrotomía, lo cual es una de las grandes virtudes de esta técnica en el abordaje de la osteocondrosis en el perro. Durante el procedimiento quirúrgico se retiran los colgajos del cartílago dañado y se procede al curetaje del cartílago. Se provoca un sangrado del hueso subcondral con el objetivo de promover la vascularización de la zona para la reparación del defecto residual.
La artroscopia permite la visualización de zonas anatómicas que no son visibles mediante artrotomía, lo cual es una de las grandes virtudes de esta técnica en el abordaje de la osteocondrosis en el perro.
Se considera la prueba gold standard en el diagnóstico de la enfermedad y se utiliza como referencia en el estudio de otros métodos de diagnóstico como la radiografía, la tomografía computarizada, y la resonancia magnética. El tratamiento de elección es quirúrgico, y se puede realizar mediante artroscopia accediendo con el artroscopio a través de un puerto lateral y

Inestabilidad medial del hombro
La inestabilidad medial del hombro en el perro ocurre tanto en razas pequeñas como en grandes, aunque el origen de la enfermedad es distinto en ambos casos, y es uno de los motivos más comunes de cojera del miembro anterior en el perro. El examen ortopédico puede revelar cojeras insidiosas de diferente grado, con ángulos de abducción del hombro aumentados, y pruebas específicas como el test del tendón bicipital o el cajón pueden resultar positivas. Las radiografías pueden ser útiles en el diagnóstico, ya que pueden revelar signos de enfermedad articular degenerativa.
La artroscopia es realmente útil en casos en los que las radiografías o el examen físico no son concluyentes, y permiten evaluar otras lesiones articulares asociadas, como lesiones en ligamento glenohumeral medial y tendón subescapular. En este caso la resolución quirúrgica trata de estabilizar la articulación y existen varios métodos descritos, ya sea mediante cirugía abierta o asistidos por artrosco-
pia. Aquí, la artroscopia tiene un papel fundamentalmente diagnóstico, aunque recientemente existen técnicas de estabilización asistidas por artroscopia.
Tendinopatía bicipital
Afecta principalmente a perros de edad adulta y de razas medianas a grandes. Aunque se consideraba una condición relativamente común, los avances en pruebas como la radiografía, la ecografía, la resonancia y la artroscopia permiten actualmente diferenciarla de otras condiciones patológicas como la tendinopatía supraespinosa. Existen pruebas específicas para evaluar la integridad del tendón bicipital durante el examen ortopédico, como la prueba del tendón bicipital. Una respuesta nociceptiva positiva es sugestiva de enfermedad del tendón.
Entre las pruebas de imagen la ecografía ha cobrado una gran relevancia en el diagnóstico de la tendinopatía bicipital y los avances en la misma han hecho posible la detección de lesiones de manera más precoz que con la radiografía o incluso la artroscopia. La artroscopia es útil, aunque hay que tener en cuenta las limitaciones de visión en cuanto a la totalidad del tendón bicipital, ya que una parte considerable del tendón bicipital y de las estructuras estabilizadoras mediales del hombro quedan fuera del campo de visión en un abordaje artroscópico lateral. El tratamiento de la enfermedad suele ser inicialmente conservador, y cuando el tratamiento médico no es exitoso se recomiendan las alternativas quirúrgicas. Una de ellas es la tenodesis del bicipital, técnica abierta extrapolada de la medicina humana. Otra opción es la tenotomía del bicipital en la que se secciona el tendón del bíceps y es una técnica que se puede realizar mediante procedimientos artroscópicos, simultaneando el abordaje diagnóstico y terapéutico.
Osificación incompleta del glenoide caudal
Se presenta principalmente en perros jóvenes de razas medias a grandes con edades comprendidas entre los 8 y los 10 meses de edad. Se trata de un defecto fácilmente detectable con una proyección radiográfica lateral y habitualmente se presenta de forma asintomática. Cuando el fragmento caudal del defecto es móvil se presenta un cuadro clínico de cojera y atrofia de la musculatura regional. La artroscopia cobra un papel importante tanto en el diagnóstico como en el tratamiento. En cuanto al primero, permite reforzar el diagnóstico radiográfico evidenciando otras lesiones articulares asociadas. El tratamiento de elección consiste en la retirada mediante artroscopia del fragmento libre y desbridamiento del borde de glenoide, y habitualmente se soluciona satisfactoriamente la cojera.
Artroscopia en codo
Articulación que conforman la cabeza del radio, la fosa troclear del cúbito, el proceso ancóneo, el proceso coronoides lateral y medial, y la tróclea, capitulum y foramen supratroclear del húmero distal. Cuenta con tres zonas articulares: la articulación húmero-cubital, la articulación húmero-radial y la articulación radiocubital. El soporte ligamentoso del codo lo dan los ligamentos colaterales medial y lateral, el ligamento anular y el ligamento interóseo (todos extra-sinoviales).
Las principales indicaciones del uso de la artroscopia en esta articulación incluyen los procesos diagnósticos y terapéuticos en la enfermedad del desarrollo del codo, y la osificación incompleta o fisura intercondílea humeral.
Las principales indicaciones del uso de la artroscopia en el codo incluyen los procesos diagnósticos y terapéuticos en la enfermedad del desarrollo del codo, y la osificación incompleta o fisura intercondílea humeral.
Enfermedad de desarrollo del codo: enfermedad del compartimento medial
Se define como un síndrome que incluye distintas anormalidades del desarrollo de la articulación que cursan con dolor, osteoartritis y cojera. Según el International Elbow Working Group (IEWG) esta patología incluye la lesión del coronoides medial, la osteocondrosis humeral, la no unión del proceso ancóneo, y la incongruencia articular.
Perros jóvenes de razas medianas a grandes, con un porcentaje elevado de presentación bilateral, son los más comúnmente afectados, con una clara predisposición racial en la que destacan: Labrador Retriever, Pastor Alemán, Boyero de Berna, Golden Retriever, Rottweiler, entre otras. Aun así, perros de raza pequeña también pueden padecer esta enfermedad, especialmente si hablamos de patología del proceso coronoides medial con fractura del mismo. La enfermedad del compartimento medial es el síndrome de mayor importancia dentro de la anteriormente conocida como displasia del codo. La radiografía y el TAC son métodos útiles para el diagnóstico, evidenciando lesiones óseas secundarias a la enfermedad como osteofitosis o fragmentación del proceso coronoides, pero no permiten la
visualización directa del cartílago articular y otros tejidos blandos implicados. Es por esto por lo que la artroscopia está considerada la prueba gold standard en la visualización directa y estadiaje del daño articular del compartimento medial, permitiendo realizar un estadiaje detallado de la afección cartilaginoso (Escala Outerbridge) (figura 2). Del mismo modo, mediante la exploración artroscópica del codo, se puede evidenciar la osificación incompleta del cóndilo humeral o fisura intercondílea del mismo, condición patológica que se puede presentar de manera concomitante con la enfermedad del compartimento medial.
Como se ha comentado anteriormente, junto con los procedimientos diagnósticos, la artroscopia permite realizar diversos tratamientos a este nivel. Lo más habitual es la retirada de fragmento de coronoides medial, el legrado y curetaje de lesiones cartilaginosas en coronoides medial y de osteocondrosis en cóndilo humeral, y la realización de coronoidectomía subtotales cuando así se requiere. Diversos estudios han demostrado cómo la artroscopia es el método de elección para el diagnóstico y tratamiento de estas patologías, logrando recuperaciones tempranas y resultados positivos en la evolución de este tipo de pacientes.
También se debe considerar que una vez realizada la artroscopia con las diferentes técnicas mencionadas existen técnicas quirúrgicas abiertas que se llevan a cabo en el mismo tiempo quirúrgico. El objetivo de estos procedimientos es trasladar las fuerzas del compartimento medial enfermo al compartimento lateral del codo, destacando entre este tipo de técnicas la Osteotomía Cubital Proximal de Abducción y la Osteotomía Humeral Deslizante (PAUL y SHO respectivamente por sus siglas en inglés).
Bibliografía disponible en https://www.grupoasis.com/argos/ bibliografias/artroscopia262.docx

El objetivo de este artículo es la descripción de las diferentes complicaciones quirúrgicas que pueden suceder en las cirugías de urgencias más comunes en nuestra práctica diaria. Esta tercera entrega completa las dos anteriores, centradas en la cirugía de intestino delgado y en el sistema reproductor y urinario, respectivamente.
Gabriel Carbonell Rosselló1, Elvira Deffontis Gallofré2
1Ldo.Vet, Dipl.ECVS, Acred. GECIRA y GEVO.
Socio fundador, director clínico y jefe de cirugía en Veterinarios Planet (Valencia). Cirujano especialista en múltiples centros referentes de España. Diplomado en Cirugía por el European College of Veterinary Surgeons (ECVS).
Acreditado AVEPA - Traumatología Y Ortopedia GEVO y Tejidos Blandos
GECIRA. EBVS® European Specialist in Small Animal Surgery.
2Lda. Vet, GpCert SAS Cirujana del Servicio de Cirugía Hospital Veterinaria del Mar, Barcelona Imágenes cedidas por los autores
Sistema respiratorio
Las cirugías de urgencia del sistema respiratorio más comunes son las relacionadas con el trauma torácico.
Mordeduras torácicas
Las heridas por mordedura representan hasta el 10 % de los casos de traumatismos en medicina veterinaria, y el tórax es una de las zonas donde más comúnmente se dan. Es importante tener en cuenta que las lesiones cutáneas no se correlacionan con las internas y, por ello, son fundamentales una exhaustiva evaluación del paciente y un correcto manejo de las lesiones externas y, más relevante, las internas.8
Las radiografías torácicas son un gran método diagnóstico en estos casos y, si se tiene la experiencia necesaria, frecuente-
Hernias diafragmáticas
La ruptura traumática del diafragma es la causa más común de hernia de órganos abdominales a la cavidad torácica. El correcto manejo del animal antes y después de la cirugía ha demostrado ser el factor pronóstico más importante en la aparición de complicaciones (figuras 3.2 y 3.3)
Neumotórax
La ruptura diafragmática permite la entrada de gas y otras estructuras en el espacio pleural. El animal presentará secundariamente disnea o distrés respiratorio, así como problemas con el intercambio de gases y ventilación. El diagnóstico normalmente puede realizarse mediante radiografía simple y se confirma con una toracocentesis o aspiración tras la colocación de un tubo torácico. El tratamiento se basa en el drenaje de la cavidad abdominal, así como en la reparación de la causa subyacente.1
Efusión pleural
Es la presencia de líquido en el espacio pleural, que debe extraerse mediante toracocentesis con fines diagnósticos y terapéuticos. Hay que evaluar la posibilidad de colocar un tubo pleural mientras se determina el diagnóstico definitivo y, consecuentemente, adaptar el mejor tratamiento. Es posible que se requiera una toracocentesis repetida adicional si la efusión y los signos clínicos recidivan, por lo que en casos crónicos y/o recidivantes la colocación del tubo torácico se considera de elección. Sin embargo, la resolución solo se conseguirá mediante un tratamiento específico de la causa primaria.
Las lesiones cutáneas no se correlacionan con las internas y, por ello, son fundamentales una exhaustiva evaluación del paciente y un correcto manejo de las lesiones externas y, más relevante, las internas.8
mente son suficientes para el diagnóstico y para evaluar la extensión del problema. En caso de que no sean diagnósticas o se requiera una evaluación más detallada, principalmente para estudiar la extensión, el TC o la exploración toracoscópica son el siguiente paso.
Mediante toracotomía o toracoscopia exploratoria podremos desbridar, lavar e inspeccionar estructuras intratorácicas.
Las heridas por mordeduras presentan una gran susceptibilidad a la infección, en cuyo caso es preciso el uso de antibioterapia. No debemos olvidar que la morbilidad de una infección torácica, con la aparición del piotórax consecuente, puede ser muy alta e incluso dar como resultado una complicación vital.
Las principales complicaciones asociadas a las moderduras torácicas son: neumotórax, efusión pleural, sepsis, SIRS, infección de la herida, deshiscencia y complicaciones asociadas a la cirugía torácica realizada9 (figuras 3.1).
El manejo y el pronóstico dependerán de la causa primaria de dicha efusión.1
Atelectasia pulmonar
La entrada de aire o estructuras ocupantes de volumen en la cavidad abdominal dará lugar al colapso de los lóbulos pulmonares.
La ruptura del diafragma, por ejemplo, genera la entrada de gas, fluidos y/o vísceras, lo que provoca el colapso pulmonar. La atelectasia aguda puede resolverse mediante un suave reinflado manual de los pulmones con una presión de 10 a 20 cmH2O, mientras que si es crónica se debería llegar hasta los 30 cmH2O. En casos crónicos, principalmente, no debe superarse dicha presión ni buscar una recuperación rápida, puesto que podría dar lugar a un barotrauma y edema por reexpansión. La atelectasia que no responde se puede tratar con ventilación prolongada con presión positiva o presión positiva al final de la espiración.1
En caso de ruptura traumática del diafragma, el correcto manejo del animal antes y después de la cirugía ha demostrado ser el factor pronóstico más importante en la aparición de complicaciones.




Deshiscencia
El fracaso parcial o completo en la reparación quirúrgica puede dar lugar a una reherniación de las vísceras abdominales a la cavidad torácica. Los signos clínicos serán similares a los que se presentaban antes de la operación. El tratamiento requerido es la reintervención,



de
de
dura
aparentemente sin repercusión interna, y la posterior exploración quirúrgica con lesión intercostal y lesión pulmonar. La lobectomía pulmonar y colocación de drenajes torácicos y de herida fue necesaria en este caso.

cuyo riesgo de hemorragia, ruptura y necrosis de los órganos reherniados es mayor. En caso de excesiva tensión deberemos evaluar otras opciones de reconstrucción que reducen específicamente la
tensión diafragmática como, por ejemplo: realizar un flap muscular del transverso abdominal, colocación de mallas de polipropileno, fascia lata, fascia porcina o flaps pericárdicos.1
La atelectasia aguda puede resolverse mediante un suave reinflado manual de los pulmones con una presión de 10 a 20 cmH2O, mientras que si es crónica se debería llegar hasta los 30 cmH2O. En casos crónicos, principalmente, no debe superarse dicha presión ni buscar una recuperación rápida, puesto que podría dar lugar a un barotrauma y edema por reexpansión.




Figuras 3.3. Imágenes radiográficas latero-lateral y ventro-dorsal de una hernia diafragmática con atelectasia pulmonar, hernia gástrica y leve efusión pleural.


Figuras 3.2. Imágenes de diferentes escenarios de hernias diafragmáticas. Se observa una hernia diafragmática crónica con el bazo atrapado, una hernia diafragmática mediante laparoscopia y una resolución tradicional de una hernia circunferencial ventral en un gato.
Incarceración de vísceras abdominales
La ruptura del diafragma puede conllevar la hernia de vísceras abdominales en el tórax y, en ocasiones, la consecuente estrangulación de estas, lo que provoca su dilatación y congestión o la estrangulación del aporte sanguíneo. El tratamiento se basa en la reducción de las vísceras y corrección del defecto diafragmático. En caso de compromiso en la viabilidad de las vísceras será necesaria la escisión de la parte afectada. Si existe dilatación gástrica el estómago debe ser descomprimido antes; además, esta actuación facilitará en gran medida la cirugía y la evaluación de los órganos.1
Otras complicaciones asociadas con la ruptura diafragmática son aquellas propiamente relacionadas con el daño pulmonar: edema, contusión, neumonía, distrés o hemorragia.
Existe limitada literatura en veterinaria sobre protocolos de actuación y el pronóstico para el tratamiento del hemoabdomen traumático o espontáneo, por lo que no se puede extraer un tratamiento específico para cada escenario.11 El tratamiento conservador del hemoabdomen traumático en veterinaria ha sido descrito con un porcentaje de éxito muy alto >85 %.Ya sean traumáticos o espontáneos, los signos clínicos asociados están relacionados con el shock hipovolémico e incluyen debilidad o colapso, mucosas pálidas, retraso en el llenado capilar, taquipnea, disnea y taquicardia.11
La cirugía de urgencia se realiza cuando el sangrado no puede ser manejado con tratamiento médico intensivo y es necesaria la intervención quirúrgica para localizarlo y pararlo.
Generalmente, conlleva la extirpación del órgano implicado (esplenectomía) o
Las arritmias ventriculares son un hallazgo común en perros con hemoabdomen de origen esplénico y a los que se les realiza una esplenectomía, así como el daño en la pared gástrica y los tromboembolismos.1
Hemoabdomen
Para finalizar, otra cirugía de urgencia en medicina veterinaria es el hemoabdomen.
El sangrado interno en la cavidad abdominal puede tener diferentes orígenes. Generalmente, y en orden de frecuencia descendente son: bazo, hígado, riñones, adrenal.
En general, la causa del sangrado suele ser un traumatismo o ruptura orgánica espontánea, en cuyo caso suele estar asociado a neoplasia o alteraciones en la coagulación y, con ello, a un peor pronóstico.10
partes de este (lobectomía hepática). Las complicaciones de este cuadro clínico son mayoritariamente sistémicas, además de las asociadas a la cirugía realizada. Las arritmias ventriculares son un hallazgo común en perros con hemoabdomen de origen esplénico y a los que se les realiza una esplenectomía, igual que el daño en la pared gástrica y los tromboembolismos.1
Cualquier hemoabdomen debe considerarse un proceso potencialmente vital; sin embargo, con una intervención quirúrgica oportuna, un número considerable de estos perros pueden tener buenos tiempos de supervivencia a largo plazo.11
La cirugía de urgencia engloba multitud de órganos y sistemas potencialmente afectados. Por ello, requiere de un equipo y un cirujano experimentado en todas aquellas complicaciones que potencialmente puedan ocurrir durante el periodo perioperatorio. El pronóstico definitivo de nuestros pacientes depende mayoritariamente de la rápida detección de complicaciones y situaciones que acontecen en estos pacientes, muchas veces de forma simultánea. La temprana toma de decisiones y ejecución del tratamiento y estabilización correspondientes minimizará así la repercusión de los hechos acontecidos.

Bibliografía:
1. Griffon D, Hamaide A. Wiley (ed): Complications in Small Animals Surgery. 2016.
2. Ellison GW: Complications of gastrointestinal surgery in companion animals. Vet Clin North Am Small Anim Pract. 2011 Sep;41(5):915-34, vi.
3. Venara A et al.: Postoperative ileus: Pathophysiology, incidence, and prevention. J Visc Surg. 2016 Dec;153(6):439446
4. Hagman R. Pyometra in Small Animals. Vet Clin North Am Small Anim Pract. 2018 Jul;48(4):639-661.
5. Campbell BG. Omentalization of a nonresectable uterine stump abscess in a dog. J Am Vet Med Assoc. 2004 Jun 1;224(11):1799-803, 1788.
6. Biddle D, Macintire DK. Obstetrical emergencies. Clin Tech Small Anim Pract. 2000 May;15(2):88-93.
7. McLoughlin MA. Complications of lower urinary tract surgery in small animals. Vet Clin North Am Small Anim Pract. 2011 Sep;41(5):889-913, v.
8. Cabon Q, et al. Thoracic bite trauma in dogs and cats: a retrospective study of 65 cases. Vet Comp Orthop Traumatol. 2015;28(6):448-54
9. Frykfors von Hekkel AK, Pegram C, Halfacree ZJ. Thoracic dog bite wounds in dogs: A retrospective study of 123 cases (2003-2016). Vet Surg. 2020 May;49(4):694-703.
10.Brockman DJ et al. A practical approach to hemoperitoneum in the dog and cat. Vet Clin North Am Small Anim Pract. 2000 May;30(3):657-68.
11.Aronsohn MG, Dubiel B, Roberts B, Powers BE. Prognosis for acute nontraumatic hemoperitoneum in the dog: a retrospective analysis of 60 cases (2003-2006). J Am Anim Hosp Assoc. 2009 Mar-Apr;45(2):72-7.

Hoy en día, el tratamiento principal para el hemangiosarcoma (HSA) esplénico en el perro sigue siendo la cirugía. En investigación, la vanguardia científica sobre el tema es prometedora, no solo en el campo del HSA esplénico, sino en el del proceso oncogénico del resto de tumores de origen vascular.
José Manuel Vilameá Iglesias
Área de medicina interna del Hospital y Clínicas Veterinarias Abeiro. La Coruña. España.
El hemangiosarcoma (HSA) es una neoplasia maligna que se origina a partir del endotelio vascular. Afecta con mayor prevalencia a machos mayores (8-10 años). Las razas más predispuestas a padecer HSA son el Golden Retriever y el Pastor Alemán.1,2,3
Algunos estudios27,28 sugieren que es la médula ósea el lugar donde estriba el origen celular del HSA. Desde allí, las células pluripotentes en fase de prediferenciación serían capaces de migrar a sitios de gran vascularización (como el bazo), donde sufrirían una alteración de su camino diferenciativo fisiológico hacia su línea premarcada, convirtiéndose así en cancerosas. Si bien este hecho podría explicar la alta prevalencia del HSA esplénico canino, el origen fisiopatológico de esta enfermedad sigue sin estar del todo esclarecido hoy en día.29
Su localización más común es el bazo,2 aunque también es frecuente en la aurícula derecha, pericardio e hígado.3
En la mayoría de los casos, el comportamiento biológico de esta neoplasia es muy agresivo, metastatizando en estadios tempranos del proceso.1
Los signos clínicos suelen estar relacionados con la localización del tumor primario.3 En el HSA esplénico destacan: distensión abdominal,1,2,3 debilidad,1,3 palidez de mucosas,3 letargia2 y, en casos agudos, muerte súbita.2 Tanto las pruebas laboratoriales (hematología, microscopía, punción con aguja fina, etc.), como las de imagen (radiografía y ecografía), son válidas únicamente como orientación a un diagnóstico presuntivo.2,3 El diagnóstico definitivo del HSA ha de establecerse mediante biopsia y posterior análisis histopatológico.2,3
El tratamiento de elección para el HSA esplénico sigue siendo la cirugía.1,2,3,20
En el presente trabajo se expone el caso de Thor, paciente canino con un hemangiosarcoma esplénico. En él se describen las características generales, síntomas, métodos diagnósticos, tratamiento y pronóstico de su patología. El propósito del presente artículo surge de fusionar en un solo documento un artículo de revisión sobre un proceso oncológico común en caninos como es el HSA, con el caso clínico concreto de un paciente con dicho mal. De ese modo se busca la consecución de una doble finalidad. Por un lado, exponer de manera ordenada y sistemática los diferentes datos recopilados sobre el proceso, haciendo hincapié en las diferentes opciones terapéuticas que en la actualidad se utilizan para paliarlo. Por otro, intentar constatar esta labor sintética o de revisión mediante la inclusión del curso de la enfermedad en un paciente concreto, para ver así en qué medida se cumplen las predicciones tanto laborato-
riales como clínico-patológicas, o incluso pronósticas, dictadas por los cánones de la bibliografía.
Los objetivos son:
• Definir nosológicamente qué es el HSA esplénico en el perro.
• Describir los tratamientos actuales usados en la práctica clínica
• Esbozar algunas investigaciones y nuevas terapias con relación a esta patología.
• Transversalmente a lo anterior, exponer el caso de un paciente con HSA para ilustrar la teoría con el manejo práctico de la enfermedad.
grado III/IX dentro del BCS (Body Condition Score).
A nivel cefálico se observó lo siguiente: mucosas pálidas, tiempo de relleno capilar de aproximadamente 3 segundos y medio, y baja temperatura en pabellones auriculares y trufa. Dicha hipotermia era también evidente en la parte distal de las extremidades. La termometría reveló una temperatura de 37,7 °C.
La auscultación pulmonar fue normal, mientras la cardiaca reveló un soplo de grado II sobre VI con punto de máxima intensidad en el área de proyección mitral.
A la palpación abdominal era muy evi-
A nivel cefálico se observó lo siguiente: mucosas pálidas, tiempo de relleno capilar de aproximadamente 3 segundos y medio, y baja temperatura en pabellones auriculares y trufa.
Anamnesis
Acude a nuestro hospital Thor, un perro de raza Pastor Alemán, de 8 años y 39 kg de peso.
El principal motivo de consulta es, según los dueños, que “desde hace algunos días, Thor apenas come y está muy apagado”. Dicen además que “le notan la barriga hinchada”.
Pese al hallazgo de una leve taquicardia, la exploración general reveló que las constantes vitales (temperatura, ritmo cardiaco y frecuencia respiratoria) estaban dentro de la normalidad. Los signos de emaciación eran ostensibles, situándolo en un
Distensión abdominal con o sin abdomen agudo15,16,17,18
• Dilatación-vóvulo gástrico.
• Distensión vesical.
• Enteropatí a perdedora de proteínas.
• Esplenomegalia.
• Gestación.
• Hepatitis.
• Íleo.
• Insuficiencia cardiaca congestiva derecha.
• Insuficiencia hepática.
• Malnutrición proteica.
• Nefromegalia.
• Neoplasias abdominales.
• Neumoperitoneo.
• Obesidad.
• Obstrucción o torsión intestinal.
• Obstrucción uretral completa.
• Oclusión venosa.
• Piómetra.
• Shunts portosistémicos.
• Síndrome de Cushing.
• Síndrome de malabsorción.
• Torsión de lóbulo hepático.
• Uroabdomen.
dente la presencia de una masa firme y dolorosa en la parte craneal del abdomen.
La exploración del tegumento fue normal, sin que se apreciase masa cutánea alguna.
A mayores de los ya enumerados, fueron encontrados síntomas de otros cuadros que eran independientes del proceso aquí descrito. Entre ellos: indicios de catarata en ambos ojos, signos de diversas artrosis a nivel apendicular, déficit propioceptivo leve en las extremidades posteriores, y un plantigradismo evidente que Thor arrastraba desde la infancia.
Diagnostico diferencial
Ante la sospecha de un caso de HSA esplénico, se hace oportuno incluir en el
• Anosmia.
• Consumo de fármacos anorexigénicos.
• Estrés.
• Miedo.
• Procesos inflamatorios sistémicos.
• Procesos neoplásicos.
• Rechazo a los alimentos por sus características organolépticas.
• Odinofagia. - Afecciones de la cavidad oral (glositis, problemas dentales, gingivitis, masas, etc.).
- Miositis de los maseteros.
- Afección ósea mandibular, maxilar, palatina, pterigoidea, o de cualquier otra estructura ósea a nivel de la cavidad oral.
- Artritis y/o artrosis temporomandibular.
- Cuerpos extraños.
- Neuropatías bucales.
estudio nosológico una lista de diagnósticos diferenciales. En la tabla 1 se exponen los propuestos en función de la anamnesis del paciente:
• Distensión abdominal con o sin abdomen agudo15,16,17,18
• Anorexia17,18
• Apatía15,18
Debido a la gran cantidad de patologías tangentes a la apatía, se ha recurrido para su colección al ICD (International Classification of Diseases).
Técnicas diagnósticas
Si bien los resultados de las distintas técnicas comúnmente empleadas en el diagnóstico del HSA esplénico no permiten establecer un diagnóstico definitivo del mismo, sí son de gran utilidad a la hora de orientar al clínico hacia un diagnóstico presuntivo.2
Hematología
Según Nelson R. y Couto G. (se cita textualmente), “los hemagiosarcomas son el sueño del hematólogo, porque suelen cursar con una amplia variedad de anormalidades hemáticas y hemostáticas”1
Hemograma
Los parámetros más comúnmente afectados en el hemograma de un perro con HSA son los de la serie roja, los de la serie blanca, y las plaquetas. Esto se traduce en anemia, leucocitosis con neutrofilia, y trombocitopenia.1,2,3 En el HSA esplénico, la anemia parece tener una naturaleza hemolítica microangihepática.14 Viendo los resultados del hemograma efectuado (tabla 2), la anemia se hizo
• Ciertos trastornos infecciosos y parasitarios.
• Neoplasias.
• Trastornos sanguíneos y de los órganos mieloproliferativos, así como trastornos inmunológicos.
• Trastornos endocrinos, nutricionales y metabólicos.
• Trastornos mentales y del comportamiento.
• Trastornos del sistema nervioso.
• Trastornos oculares y de los anejos.
• Trastornos del oído y del proceso mastoideo
• Trastornos del sistema circulatorio.
• Trastornos respiratorios
• Trastornos digestivos
• Trastornos de la piel y tejido subcutáneo.
• Trastornos musculoesqueléticos y del tejido conectivo.
• Trastornos genitourinariaos.
• Embarazo, parto y puerperio.
• Trastornos perinatales.
• Malformaciones congénitas, deformaciones o anormalidades cromosómicas.
• Hallazgos laboratoriales no localizados, y por lo tanto no clasificados.
• Heridas, envenenamientos y otras causas de origen externo.

Tabla 3. Bioquímica prequirúrgica efectuada al paciente. Fuente: Hospital Veterinario Abeiro. La Coruña.
patente por el bajo nivel de glóbulos rojos (RBC: 3,8; v. ref: 5,5-8,8), hemoglobina (HGB: 8,1; v. ref: 12-18) y hematocrito (HCT: 26,2; v. ref: 37-55). Aunque con menos valor diagnóstico para el presente caso, el volumen corpuscular medio (MCV), la hemoglobina corpuscular media (MCH) y la concentración media de hemoglobina corpuscular (MCHC) también estaban bajos o normales, pero rozando el límite inferior.
La leucocitosis (WBC 29,5; v. ref: 6-17) resultó ser prominentemente granulocítica (G 90,4; v. ref: 60-80).
El único parámetro que, pudiendo estar alterado en el HSA, estaba en rango, fue el número de plaquetas (PLT 277; v. ref: 200-500).
Además, su tiempo de coagulación era de 6 minutos (rango de 5,7 a 6,5).
Bioquímica
En el HSA la bioquímica es inespecífica, pero puede mostrar hipoalbuminemia y leves aumentos de las enzimas hepáticas.11
Pese a no tener un valor diagnóstico tan elevado como el del hemograma, en lo referente al HSA de bazo la bioquímica es capaz de informarnos sobre lesiones en otros órganos que pueden ser consecuencia directa o indirecta del proceso esplénico.
Las “consecuencias directas” se refieren al componente físico de la esplenomegalia, si la hubiere. En el caso concreto de Thor, se induciría una compresión que el bazo agrandado ejercería sobre el resto de las vísceras abdominales.

radialmente al resto de vísceras abdominales (figura 1).
En la radiografía de tórax (figura 2) la silueta cardiaca era normal en posición, forma y tamaño (VHS de 10,5). La carina era perfectamente visible, y su distancia a las vértebras era de 1/3, mientras que la distancia al ápex cardiaco era de 2/3. En su recorrido intratorácico, la tráquea era normal.
La cava craneal, la caudal y la aorta no mostraban anomalías. Por último, el parénquima pulmonar y los ganglios linfáticos
Si bien los resultados de las distintas técnicas comúnmente empleadas en el diagnóstico del HSA esplénico no permiten establecer un diagnóstico definitivo del mismo, sí son de gran utilidad a la hora de orientar al clínico hacia un diagnóstico presuntivo.2
A nivel hepático, enzimas como la fosfatasa alcalina (ALP) informa, entre otras cosas, de la integridad de la circulación hepatobiliar.9,10 Un aumento en dicha enzima se da en caso de colestasis posthepática, como ocurre por ejemplo en neoplasias10
La AST se eleva ante la necrosis del hepatocito y, en menor grado, ante daños en su membrana.9,10 Una causa evidente de necrosis hepática es la presión ejercida por vísceras adyacentes.
En el músculo esquelético, la creatincinasa (CK) se eleva ante daños en el miocito.9,10 Ante una distensión abdominal tan grande como la de nuestro paciente, el daño de los músculos de la pared del abdomen es evidente.
La LDH incrementa su valor en perros como consecuencia de la ascitis. Los derrames de origen maligno ocasionan aumentos en esta enzima de hasta 1.600 u/L.10
En nuestro paciente, la bioquímica arrojó los resultados recogidos en la tabla 3. Además de los aumentos en la ALP, AST, CK y LDH, encontramos también elevada la urea (aunque discretamente). Considerando el valor de esta última en conjunto con el de la creatinina y el fósforo, podemos descartar enfermedad renal.12
La hipoalbuminemia estaría justificada por la ascitis9,10
Radiología
La radiografía de abdomen reveló la presencia de una masa radiopaca de 26 cm de diámetro, aparentemente única y homogénea, que ocupaba la práctica totalidad de la cavidad, desplazando
mediastínicos tenían una anatomía radiológica normal, no evidenciándose signo alguno de metástasis a ese nivel.
Las neoplasias malignas, a menudo metastatizan a los ganglios linfáticos regionales y a las estructuras torácicas1,2,3,6,20
En el caso de cualquier neoplasia abdominal, se hace necesario examinar radiográficamente el tórax en busca de masas mediastínicas, cardiacas, ganglios linfáticos torácicos agrandados, metástasis pulmonar superficial o efusión pleural. Concretamente, los ganglios linfáticos esternales son lugares comunes de
metástasis procedentes de una neoplasia abdominal craneal o de una lesión peritoneal.1,2,3,5
Ecografía
En la ecografía abdominal (figura 3), se observaron cambios evidentes de la arquitectura normal del bazo. Eran visibles zonas hipoecoicas alternadas con zonas hiperecoicas, lo que daba a la víscera una ecogenicidad mixta. La ecotextura era heterogénea, estando sus bordes muy mal definidos.
Además, fue destacable la presencia de abundante líquido ascítico.
El hemangiosarcoma es la neoplasia diagnosticada con mayor frecuencia en el bazo canino.5 No obstante, conviene puntualizar que los estudios ecográficos, además de no ser aptos para establecer un diagnóstico definitivo, ni siquiera permiten distinguir entre la naturaleza maligna o benigna de la masa.7,8
Los parámetros más comúnmente afectados en el hemograma de un perro con HSA son los de la serie roja, los de la serie blanca, y las plaquetas. Esto se traduce en anemia, leucocitosis con neutrofilia, y trombocitopenia.1,2,3


Análisis del líquido ascítico
La extracción se realizó mediante la técnica de punción ecoguiada con aguja fina (AAF). El resultado de la laparocentesis fue la obtención de un líquido serosanguinolento nítido.
Tras su análisis mediante microscopía y refractometría, se determinaron los siguientes parámetros:
• Proteínas totales: 3,2 g/dl
• Densidad relativa: 1.021 g/dl
• Células nucleadas/µL: 7900
• Ausencia de bacterias.
Según Willard M. y Tvedten H., dichos valores lo encuadran en la categoría de trasudado modificado.9 Este tipo de trasudados son compatibles con una neoplasia abdominal.9,10
El paso siguiente fue centrifugarlo, extenderlo y teñirlo con Diff Quick para una observación citológica más minuciosa. El examen del sedimento del líquido cen-
La leucocitosis que había mostrado el aparato de hemograma, una vez visto el frotis al microscopio, resultó ser prominentemente polimorfonuclear granulocítica, por lo que se confirmó una neutrofilia con desviación a la izquierda, regenerativa y sin signos tóxicos.

trifugado aumenta la posibilidad de hallar células malignas9
Microscopía
Se realizaron exámenes microscópicos a dos niveles: hematológico (frotis sanguíneo) y lesional (citología del tumor).
Microscopía hematológica
Según Couto, las anormalidades citohematológicas del perro con HSA están bien caracterizadas.1
Morfológicamente, podemos encontrar: eritrocitos nucleados1,13, esquistocitos1,3,13 y equinocitos13
En la ecografía abdominal, se observaron cambios evidentes de la arquitectura normal del bazo. Eran visibles zonas hipoecoicas alternadas con zonas hiperecoicas, lo que daba a la víscera una ecogenicidad mixta.
De la serie blanca son posibles la neutrofilia con desviación a la izquierda1,3 y la monocitosis1
La leucocitosis que había mostrado el aparato de hemograma, una vez visto el frotis al microscopio, resultó ser prominentemente polimorfonuclear granulocítica, por lo que se confirmó una neutrofilia con desviación a la izquierda, regenerativa y sin signos tóxicos.
De estar el HSA diseminado, es posible la aparición de un estado o reacción llamada leucoeritroblástica (figura 4), un proceso paraneoplásico en el que hay una
extrema demanda de eritrocitos y leucocitos en sangre periférica que se caracteriza por un predominio muy marcado de eritrocitos nucleados y neutrófilos inmaduros en la misma13
Microscopía del tumor
Las neoplasias vasculares, como el HSA, son difíciles de diagnosticar por citología obtenida del líquido ascítico mediante PAF. Diferenciar el HSA de otras lesiones vasculares benignas (por ejemplo, hematomas) es complicado, debido a la contaminación sanguínea de la muestra. Solo excepcionalmente se observan células conjuntivas con características de malignidad.14 La cosa cambia cuando se realiza una impronta o una AAF del tumor ya extirpado. En ese caso, es posible encontrar células neoplásicas, que serán similares a las de otros sarcomas, y pueden mostrar morfología fusiforme o poliédrica y uno o más nucleolos voluminosos con un patrón cromatínico de bordado o encaje. El citoplasma es gris-azulado y, en general, vacuolado1 (figura 5).
Es fundamental tener en cuenta que, si bien la abdominocentesis mediante PAF ecoguiada no entraña grandes riesgos en general, si lo hace si se practica directamente sobre las lesiones tumorales sospechosas, debido a la alta probabilidad de provocar una hemorragia, con la subsecuente dispersión de las células neoplásicas en el peritoneo3,19
En nuestro caso, la citología se realizó después de la extirpación quirúrgica del tumor, previamente a su envío al laboratorio de anatomía patológica.
Bibliografía disponible en https://www.grupoasis.com/argos/ bibliografias/HSA262.docx



Los espermatozoides de origen epididimario presentan una mayor criorresistencia que los eyaculados. Este tipo de muestras pueden utilizarse tanto para congelación como para vitrificación, una técnica alternativa de reciente aparición que está tomando cada vez más fuerza.
Joaquín Cerdeira Lozano, Andrea Priego González, Ana Muñoz Maceda, Cristina Castaño, MaríaJesús Sánchez Calabuig* y Julián Santiago Moreno.
Universidad Complutense de Madrid
Consejo Superior de Investigaciones Científicas
Imágenes cedidas por los autores
La congelación de semen canino es un procedimiento realizado cada vez con mayor frecuencia en centros veterinarios que consiste en la conservación de muestras seminales en nitrógeno líquido a -196 °C utilizando diluyentes que contienen sustancias crioprotectoras que evitan el daño celular de los espermatozoides con el fin de preservar su viabilidad. Se trata de una técnica rápida y segura que permite el almacenamiento y transporte de muestras, ya que facilita su intercambio sin necesidad de desplazar al macho reproductor, y, por lo tanto, evita tanto el estrés del viaje como las restricciones sanitarias que implica el movimiento de animales.
espermatozoides poseen una superficie muy reducida, una estructura muy compartimentalizada y una concentración elevada de crioprotectores naturales como polímeros, azúcares y nucleótidos. Además, debido a la alta velocidad de congelación a la que se realiza la vitrificación, no se produce la formación de cristales intracelulares que puedan producir daño celular. Las muestras espermáticas para la realización de cualquiera de estas dos técnicas de criopreservación pueden ser obtenidas por eyaculación o, alternativamente, recuperadas del epidídimo tras una orquiectomía o post mortem. Hay que tener en cuenta que el origen de las muestras (eyaculado o epididimario) puede afectar a la resistencia de los espermatozoides a la congelación. En el perro, al igual que en otras especies domésticas y silvestres estudiadas, los espermatozoides de origen epididimario presentan una mayor criorresistencia que los eyaculados. Las técnicas descritas a continuación no solo tienen una aplicación directa en el perro, ya que también han sido exitosamente aplicadas para la conservación de material esper-
La vitrificación no requiere del uso de crioprotectores intracelulares debido a que los espermatozoides poseen una superficie muy reducida, una estructura muy compartimentalizada y una concentración elevada de crioprotectores naturales como polímeros, azúcares y nucleótidos.
Por otro lado, la vitrificación de semen es una técnica de reciente aparición que está tomando cada vez más fuerza como método de criopreservación alternativo a la congelación, ya que presenta resultados prometedores y varias ventajas respecto a la congelación tradicional. Entre ellas se encuentra que no requiere el uso de crioprotectores intracelulares debido a que los
mático de especies de cánidos silvestres protegidos como el lobo ibérico.
Obtención de espermatozoides del epidídimo
Los espermatozoides de todos los mamíferos experimentan una serie de transformaciones durante su paso por el


Representación de la cuadrícula de una cámara de Neubauer, con los cuadrantes que se deben cuantificar marcados en rojo.
epidídimo que conducen a su maduración, de manera que al llegar a la cola epididimaria ha migrado la gota citoplasmática y han adquirido motilidad progresiva. Todo ello permite que los espermatozoides recuperados a este nivel tengan capacidad de fecundación y, por lo tanto, sean aptos para su utilización en técnicas de reproducción asistida.
La recuperación de este tipo de muestra seminal de gónadas ex vivo es muy interesante tanto para animales sometidos a una orquiectomía como para animales fallecidos de elevado valor genético. Para
La recuperación de muestra seminal epididimaria de gónadas ex vivo es muy interesante tanto para animales sometidos a una orquiectomía como para animales fallecidos de elevado valor genético.

su obtención se han descrito varias técnicas, pero la más eficaz es el flushing retrógrado. Para la realización de esta técnica el primer paso consiste en separar el epidídimo del testículo y disecar tanto el plexo pampiniforme como la arteria del conducto deferente para evitar la contaminación sanguínea de las muestras. A continuación, se aísla el conducto deferente para introducir por él una aguja o palomilla de 25G previamente limada para que el extremo no sea punzante. En este momento se realiza un corte a nivel de la cola del epidídimo y se introducen 0,5 ml de medio de congelación para hacer un lavado de la muestra seminal desde el conducto deferente hacia la incisión, recuperando el contenido en una placa de Petri o en un tubo estéril (figura 1).
Evaluación espermática
Una evaluación completa de la calidad espermática debe incluir la determinación del volumen total de muestra obtenida, su concentración espermática, la motilidad total y progresiva, el porcentaje de morfoanomalías y la valoración de la integridad del acrosoma.
La evaluación de la concentración se realiza utilizando una cámara Neubauer. Para ello, realizaremos una dilución 1:200 (v/v) de la muestra espermática con una solución de cloruro sódico al 3 %, se cuenta el número de espermatozoides en cinco de los cuadrantes centrales de la cámara (extremos y centro, cada uno de los cuales contiene 16 cuadrados pequeños), utilizando el objetivo de 40x, y el resultado se multiplica por 10 millones (107), lo que nos dará los millones de espermatozoides por mililitro que hay en la muestra. Multiplicando este valor por el volumen de muestra obtenido, obtendremos la cantidad total de espermatozoides (figura 2). N.º espermatozoides en 5 cuadrados = N.º × 106 espermatozoides/ml
La viabilidad de los espermatozoides y el estado del acrosoma se pueden analizar simultáneamente utilizando una combinación de fluorocromos de propidio y aglutinina (Arachis hypogaea) conjugada

con isothiocianato de fluoresceína. Se debe realizar el contaje de 100 espermatozoides para obtener un porcentaje sobre el total.
Para la evaluación de las morfoanomalías lo más adecuado es realizar una extensión de la muestra seminal sobre un portaobjeto limpio, para posteriormente teñirlo con Diff-Quik o Hemacolor (para ello, se dejará 2 min. en la solución de fijación y 2 min. en cada una de las dos soluciones de tinción; figura 3) y observarlo al microscopio. Se deben cuantificar, contando 100 espermatozoides, aquellos con anomalías de la cola, de la cabeza o de la pieza intermedia. De esta forma se obtendrá un porcentaje para cada una de las anomalías y un porcentaje de espermatozoides de morfología normal. Esta determinación es muy importante, ya que por debajo de un 80 % de espermatozoides normales se considera que la fertilidad está comprometida.
Una evaluación completa de la calidad espermática debe incluir la determinación del volumen total de muestra obtenida, su concentración espermática, la motilidad total y progresiva, el porcentaje de morfoanomalías y la valoración de la integridad del acrosoma.
Habitualmente, el semen canino presenta un volumen que oscila entre 1 y 30 ml por eyaculado, y contiene entre 300 millones y 2.000 millones de espermatozoides, de los cuales más del 70 % son móviles de manera progresiva y morfológicamente normales. Es importante tener en cuenta que estos valores pueden variar dependiendo de factores como la edad del perro, su salud general, y la técnica utilizada para la obtención y evaluación del semen.
una incubadora al 5 % de CO2 en aire a máxima humedad. En cualquier caso, el material espermático obtenido se diluye hasta alcanzar una concentración final de 25 × 106 espermatozoides/ml. Para obtener la cantidad de diluyente que debemos añadir a nuestra muestra, se utiliza la siguiente fórmula:
Volumen inicial × Concentración inicial = Volumen final × Concentración final El volumen inicial y la concentración inicial son los valores que hemos obte-
Valores como el volumen de semen por eyaculado, el número de espermatozoides, así como su movilidad y normalidad morfológica, pueden variar dependiendo de factores como la edad del perro, su salud general, y la técnica utilizada para la obtención y evaluación del semen.
Vitrificación de espermatozoides epididimarios
Para la vitrificación de espermatozoides de origen se debe añadir lentamente el medio de vitrificación de nuestra elección. Se puede recurrir a un medio comercial utilizado para preservar semen en humanos (ej. Irvine medio de refrigeración – test yolk buffer) al que se le añade 250 mM de sacarosa. Alternativamente, se puede utilizar el medio HTF (human tubal fluid) con 1 % de BSA y 250 mM de sacarosa previamente equilibrados en


nido durante el procedimiento anterior de evaluación del semen. Una vez obtenido el volumen final, debemos restarle el volumen inicial. De esta manera, sabremos el volumen exacto en ml que debemos añadir para obtener la concentración deseada. Posteriormente, la muestra de semen diluido se debe pipetear con la ayuda de una micropipeta gota a gota (30 µl cada una) desde una altura aproximada de 11 cm, directamente sobre nitrógeno líquido para formar los pellets. Después, estos pellets se deben recuperar y almacenar en viales criogénicos de 2 ml, que se introducirán en un tanque de nitrógeno para su conservación (figura 4). Para calentar los pellets, estos deben colocarse de cinco en cinco en tubos falcon de 15 ml con 5 ml de medio Irvine previamente equilibrado en una incubadora al 5 % de CO2 en aire a máxima humedad a 37 °C. Las muestras se deben mantener en la incubadora a 37 °C durante 10 minutos, para luego centrifugar los tubos a 300XG durante 5 minutos. Por último, se elimina el sobrenadante y se resuspende el pellet en 50 ml en el medio Irvine o bien HTF +1 % BSA. Las muestras se deben evaluar después del calentamiento como se ha descrito anteriormente.
Congelación convencional de espermatozoides epididimarios
El procedimiento de congelación convencional se puede llevar a cabo en uno o dos pasos dependiendo del tipo de diluyente que se utilice.
El primer paso consiste en sumergir el tubo con la muestra espermática obtenida en un vaso con agua a temperatura ambiente, para que baje progresivamente de temperatura:
• En primer lugar, se añade el medio Irvine de refrigeración hasta alcanzar una concentración de 100 × 106 espermatozoides/ml y mantenerlo a 5 °C durante 1 h.
• En una segunda fase, se añade el diluyente Irvine de congelación (que ya contiene el crioprotector glicerol) previamente enfriado en volumen igual al de la muestra con el primer paso (dilución 1:1) y se mantiene durante 1 h más a 5 °C (periodo de equilibrado con el crioprotector).
De esta manera, el volumen de estas muestras antes de la congelación convencional alcanzará una concentración final de 50 × 106 espermatozoides/ml. La muestra se cargará manualmente en pajuelas de 0,5 ml previamente rotuladas con los datos del macho donante. Estas pajuelas y el material que utilicemos para la manipulación del semen tienen que haberse enfriado previamente para mantener unas condiciones constantes de refrigeración.
El procedimiento de congelación convencional se puede llevar a cabo en uno o dos pasos dependiendo del tipo de diluyente que se utilice.
Las pajuelas se congelan en vapores de nitrógeno líquido. Se puede utilizar una caja de porexpan (por ej. de 30x3x30 cm) con 1,7 litros de nitrógeno líquido. Las pajuelas se mantienen a 24 cm de la superficie del nitrógeno 1 minuto y luego se bajan hasta 10 cm del nitrógeno otro minuto. Finalmente, las pajuelas se sumergen directamente en nitrógeno para que alcancen los -196 °C, y puedan ser trasladadas a un tanque de nitrógeno para su almacenamiento.
Las pajuelas deben descongelarse mediante inmersión en agua a 37 °C durante 60 segundos. Tras sumergirlas, deben secarse muy bien para evitar el contacto con el agua y el contenido se vierte en tubos Eppendorf secos de 1,5 ml, para su posterior incubación a 37 °C durante 5 minutos. En ese momento se deberán realizar las evaluaciones postdescongelación.
Bibliografía:
Caturla-Sánchez E, Sánchez-Calabuig MJ, Pérez-Gutiérrez JF, et al. Vitrification of dog spermatozoa: Effects of two cryoprotectants (sucrose or trehalose) and two warming procedures. Cryobiology 2018;80:126–129. Cerdeira J, Castaño C, Pérez JF, Marcos-Beltrán JL, Guerra R, López-Fernández M, et al. Vitrification of Iberian wolf (Canis lupus signatus) sperm: A possible alternative to conventional cryopreservation. Anim Reprod Sci. 2021;235(April):1–9. Cerdeira Lozano, J., Castaño, C., Sánchez-Calabuig, M. J., & Santiago-Moreno, J. (2023). Epididymal Spermatozoa Show Higher Cryoresistance to Vitrification Process Than Ejaculated Spermatozoa in Dogs. Biopreservation and biobanking, 21(5), 527–532. Galarza, D. A., Landi, G., Mejía, E., Samaniego, J. X., Méndez, S., Soria, M. E., Taboada, J., Sánchez-Calabuig, M. J., Castaño, C., & Santiago-Moreno, J. (2021). Cryopreservation of dog epididymal spermatozoa by conventional freezing or ultra-rapid freezing with nonpermeable cryoprotectant. Cryobiology, 103, 15–21.
Hewitt DA, Leahy R, Sheldon IM, et al. Cryopreservation of epididymal dog sperm. Anim Reprod Sci 2001;67(1–2):101–111.
Hori, T., Atago, T., Kobayashi, M., & Kawakami, E. (2015). Influence of different methods of collection from the canine epididymides on post-thaw caudal epididymal sperm quality. The Journal of Veterinary Medical Science, 77, 625–630. Martínez-Fresneda, L., Castaño, C., Bóveda, P., Tesfaye, D., Schellander, K., Santiago-Moreno, J., & García-Vázquez, F. A. (2019). Epididymal and ejaculated sperm differ on their response to the cryopreservation and capacitation processes in mouflon (Ovis musimon). Scientific reports, 9(1), 15659.
Peña FJ, Núñez-Martínez I, Morán JM. Semen technologies in dog breeding: An update. Reprod Domest Anim 2006;41(Suppl. 2):21–29.
Varesi, S., Vernocchi, V., Faustini, M., & Luvoni, G. C. (2013b). Quality of canine spermatozoa retrieved by percutaneous epididymal sperm aspiration. Journal of Small Animal Practice, 54, 87–91.
A través de la capacidad para inhibir la proliferación de condrocitos, reducir la inflamación y mejorar la calidad del líquido sinovial, el PPS ayuda a detener la progresión de la enfermedad y a mejorar la calidad de vida de los perros afectados.
Introducción
La osteoartritis (OA) es una condición crónica y progresiva que afecta a una gran parte de la población canina, caracterizada por la degeneración del cartílago articular. Este proceso provoca dolor e inflamación, limitando la movilidad del animal y deteriorando su calidad de vida. La medicina veterinaria ha avanzado significativamente en el manejo de la OA,
niéndolos en la fase inicial del ciclo celular y disminuyendo la población sin causar muerte celular. Además, el PPS promueve un fenotipo condrogénico, evidenciado por el aumento de marcadores específicos de cartílago como Col2A1 y GAG. Este efecto ayuda a frenar la progresión de la OA al mantener la homeostasis celular en el cartílago mediante la inhibición a corto plazo de genes del ciclo celular1
El PPS influye en los condrocitos articulares, células clave en la OA1,6. Reduce la viabilidad y proliferación de los condrocitos, manteniéndolos en la fase inicial del ciclo celular y disminuyendo la población sin causar muerte celular.
desarrollando estrategias que buscan aliviar los síntomas y frenar su progresión a través de un enfoque multimodal. Entre estos tratamientos, el pentosán polisulfato sódico (PPS) se ha destacado como una opción promisoria, ofreciendo beneficios tanto en la protección del cartílago como en la reducción de la inflamación.
El PPS es un glucosaminoglicano semisintético, estructuralmente similar a la heparina, que presenta propiedades anticoagulantes, fibrinolíticas y trombolíticas5. Su uso está autorizado en varios países para el tratamiento de la OA canina, donde ha mostrado efectos positivos en estudios clínicos.
Mecanismos de acción y efectos en condrocitos
El PPS influye en los condrocitos articulares, células clave en la OA1,6. Reduce la viabilidad y proliferación de los condrocitos, mante-
Estudios sobre el impacto del PPS en los condrocitos enfocados en el potencial de mejora la calidad del líquido sinovial, de la inhibición la degeneración del cartílago y promoción la diferenciación condrogénica, evidencian una mejora en la síntesis de proteoglicanos y colágeno tipo II5
Inhibición de vías proinflamatorias
El PPS también beneficia a los perros con OA a través de la inhibición de vías proinflamatorias. La literatura revela que el PPS inhibe la sintasa inducible de óxido nítrico (iNOS), las cinasas c-Jun y el factor-1alpha inducible por hipoxia (HIF-1α) en condrocitos caninos, reduciendo la degradación del cartílago. La inhibición de estos mediadores tiene el potencial de prevenir y tratar la OA al interrumpir la progresión de los procesos inflamatorios que conducen a la destrucción del cartílago. Además,
los condrocitos normales resisten la expresión de iNOS, lo que actúa como un mecanismo protector frente a la producción excesiva de óxido nítrico2
Investigaciones previas han demostrado que el PPS previene la fosforilación de la vía de las proteínas cinasas activadas por mitógenos (MAP-Kinasa) y la translocación nuclear del factor nuclear kappa B (NF-κB) en condrocitos caninos, reduciendo la síntesis de metaloproteinasa de matriz (MMP-3), una enzima catabólica que contribuye a la degradación del cartílago. Estos hallazgos refuerzan la eficacia clínica del PPS en el tratamiento de la OA al detener la degradación del cartílago4
Seguridad y efectos adversos
La seguridad del PPS también ha sido evaluada mediante la revisión de informes de reacciones adversas en el Reino Unido. Los resultados concluyen que el PPS tiene un perfil de seguridad favorable. Aunque se
observaron efectos secundarios leves, como vómitos, letargo y anorexia, estos fueron generalmente transitorios y no se relacionaron directamente con el tratamiento. No se encontraron evidencias de hemorragias espontáneas atribuibles al PPS, a pesar de su relación con los heparinoides, lo que sugiere que el PPS es una opción segura para el manejo de la OA canina3
Conclusión
En resumen, el PPS presenta un potencial terapéutico significativo para el tratamiento multimodal de la OA en perros. Sus características permiten clasificarlo dentro de una nueva categoría de medicamentos: los fármacos modificadores de la OA. A través de la capacidad para inhibir la proliferación de condrocitos, reducir la inflamación y mejorar la calidad del líquido sinovial, el PPS ayuda a detener la progresión de la enfermedad y a mejorar la calidad de vida de los perros afectados.
Referencias:
1. Akaraphutiporn E, et al. Effects of pentosan polysulfate on cell proliferation, cell cycle progression and cyclin- dependent kinases expression in canine articular chondrocytes. J Vet Med Sci. 2020;82(8):1209–1218.
2. Bwalya EC, et al. Pentosan polysulfate inhibits IL-1β-induced iNOS, c-Jun and HIF-1α upregulation in canine articular chondrocytes. PLoS ONEN. 2017;12(5).
3. Hannon RL, et al. Safety of Cartrophen Vet in the dog: review of adverse reaction reports in the UK. J Small Anim Pract. 2003;44:202–208.
4. Sunaga T, et al. Inhibitory Effects of Pentosan Polysulfate Sodium on MAP-Kinase Pathway and NF-κB Nuclear Translocation in Canine Chondrocytes In Vitro. Jap Soc Vet Sci. 2012;74(6):707–711.
5. Tobias KM, Johnston SA. Vet Surg Small Anim. 2017;1078-1111.
6. Wang Y, et al. Pentosan polysulfate sodium promotes redifferentiation to the original phenotype in micromass-cultured canine articular chondrocytes and exerts molecular weight- dependent effects. J of Vet Med Sci. 2023;85(6):680–690.

Tras la evaluación clínica y obtener un resultado positivo en un test rápido, la cuantificación serológica en un laboratorio de referencia es fundamental para interpretar correctamente el resultado del test y determinar si un perro está enfermo y necesita tratamiento o si solo requiere ser monitorizado.
DANIEL MARÍ1, JAUME RODON2
1DVM, MSc. Professional Services Veterinarian
2DVM; Professional Services Veterinarian Manager
La leishmaniosis canina (CanL) es una enfermedad producida por el protozoo Leishmania infantum, transmitida por flebótomos del género Phlebotomus spp. en Europa y en que el perro es el reservorio principal. Aunque la prevalencia de la infección es alta en zonas endémicas, se acompaña por una frecuencia baja de presentación clínica1 y, por tanto, es un buen ejemplo de enfermedad en la que la infección no equivale a enfermedad clínica (figura 1). Hay que tener presente que el riesgo de infección va en continuo aumento, debido a que la actividad y densidad del vector se alarga incluso más de ocho meses en un mismo año como consecuencia del aumento de las temperaturas fruto del cambio climático, por el movimiento y viajes de las mascotas, y por la presencia de especies reservorio de la infección, tales como liebres o zorros.2
Los factores de riesgo para contraer la infección y/o padecer la enfermedad son múltiples. Un estilo de vida más exterior, edades inferiores a 2 o superiores a 7 años y ser de talla más grande aumentan la probabilidad de padecer leishmaniosis. Todas las razas son susceptibles de enfermar, pero hay algunas más predispuestas, como el bóxer, el pastor alemán, o el cocker, u otras más resistentes, como el podenco ibicenco.3
Una detección precoz es fundamental para el control de la infección entre la
población canina sobre todo para evitar su propagación. No menos importante, es una enfermedad zoonótica que cada vez es más presente entre los seres humanos.
Epidemiología
La leishmaniosis canina se considera endémica en toda la península Ibérica, aunque con variaciones en función de la zona geográfica, de la población seleccionada y de la técnica usada. En general se encuentran prevalencias más elevadas cuando se usan técnicas moleculares, como la reacción en cadena de la polimerasa (PCR), que con tests serológicos, donde hay escasa correlación entre estos métodos.4
La cuenca mediterránea es la zona con mayor seroprevalencia, con valores superiores al 10 % de perros testados e incluso de más del 20 % en las islas Baleares, que se considera una zona hiperendémica.5
Activación macrófagos
Eliminación parásitos

Óxido nitroso sintetasa
Th2 B P
Óxido nítrico
Diseminación parásito
Figura 2. Esquema de la interacción del parásito con el sistema inmunitario del huésped, principal determinante de la progresión o no de la infección.
La cuenca mediterránea es la zona con mayor seroprevalencia, con valores superiores al 10 % de perros testados e incluso de más del 20 % en las islas Baleares, que se considera una zona hiperendémica.5
Por el contrario, la zona centro peninsular y, en menor medida, la zona norte, tienen porcentajes de seroprevalencia mucho más bajas, rondando entre el 5 – 10 %, a excepción de la provincia de Ourense, donde los registros son mucho más altos (> 17 %).5
Por último, zonas con muy baja prevalencia o con reportes esporádicos son los Pirineos (en animales de caza, por ejemplo) o en las islas Canarias, donde no se puede descartar que los casos fueran importados.6
Enfermedad clínica
Seropositivo
PCR+
Figura 1. Presentación esquemática de la distribución de la leishmaniosis canina en una área endémica, según un estudio transversal. 1) La cúspide de la pirámide consiste en un subconjunto relativamente pequeño de perros que muestran signos clínicos de la enfermedad. 2) Los perros seropositivos sin signos de la enfermedad (asintomáticos) representan el segundo subconjunto. 3) El tercer subconjunto incluye perros asintomáticos PCR+ pero seronegativos infectados. 4) Un cuarto subconjunto incluye perros seronegativos que no albergan parásitos.
leishmaniasis - new concepts and insights on an expanding zoonosis: part one. Trends in Parasitology.
Signos clínicos y anormalidades clínicopatológicas
La amplia gama de manifestaciones clínicas encontradas en la infección por Leishmania puede variar desde una ausencia total de signos clínicos hasta una enfermedad clínica mortal grave, dependiendo de la especie infectante y de la respuesta inmunitaria del hospedador. Los signos clínicos se deben principalmente a la interacción del parásito con el sistema inmunitario del huésped. De forma simplificada, una respuesta celular efectiva mediada por linfocitos Th1 favorece el control y/o eliminación del parásito mientras que una respuesta humoral mediada por linfocitos Th2 promueve su diseminación por el organismo y, por consiguiente, una enfermedad progresiva (figura 2).7
Los hallazgos más frecuentes en pacientes enfermos son lesiones en la piel, con presentaciones en forma de dermatitis exfoliativa, ulcerativa o pustular, onicogrifosis y alopecia. Un hallazgo común es la linfadenopatía (no necesariamente generalizada), aunque el incremento de tamaño de los ganglios linfáticos no está relacionado con la carga parasitaria en el tejido ni el estadio de la enfermedad. La pérdida de peso también es un signo clínico habitual. Menos frecuentes, pero igual de importantes para asociarlos a un cuadro de leis-
hmaniosis, son los signos clínicos a nivel ocular, desde blefaritis a uveítis, esplenomegalia, epistaxis, mielosupresión, artropatías, entre otras.8,9 Las anormalidades clínicopatológicas más frecuentes en pacientes enfermos son anemia leve-moderada no regenerativa e hiperproteinemia acompañado por una ratio albúmina/globulinas disminuido. La alteración renal más constante es la proteinuria, con una prevalencia del 50 % en pacientes con leishmaniosis e independiente del título de anticuerpos. La azotemia, aunque también puede estar presente, es mucho menos habitual.10,11
Una de las ventajas que posee la RT-PCR es la versatilidad de las muestras en donde se puede realizar, desde hisopos conjuntivales y sangre, hasta extensiones citológicas o biopsias.
Métodos diagnósticos
Delante de un cuadro clínico sospechoso o bien el hallazgo de anormalidades clínicopatológicas compatibles con leishmaniosis, el veterinario clínico tiene a su disposición una batería de pruebas para confirmar la infección. Estos tests pueden ser métodos de laboratorio directos (parasitológicos y moleculares principalmente) o bien indirectos (generalmente serológicos). Los métodos parasitológicos incluyen el cultivo y el examen microscópico. El pri-
mero no se usa en la clínica de rutina y casi únicamente está para fines de estudios de investigación o epidemiológicos. El examen microscópico o citología es una prueba relativamente sencilla y de bajo coste, aunque su sensibilidad no es especialmente alta. Los tipos de muestra donde es más habitual encontrar amastigotes son médula ósea y ganglios linfáticos. También es posible encontrar parásitos en lesiones nodulares en zonas atípicas como la base de la lengua, la nariz o el escroto.12
Otra posibilidad es demostrar la presencia de estructuras parasitarias en muestras histológicas. Sin embargo, esta modalidad es aún menos sensible en general que la citología, ya que es más difícil demostrar su presencia y además es más laborioso y consume tiempo. En lesiones compatibles con leishmaniosis en ocasiones se requiere de inmunohistoquímica para aumentar su sensibilidad en estos tipos de muestra.12
El diagnóstico molecular por reacción en cadena de la polimerasa a tiempo real (RT-PCR) representa una mejora en la sensibilidad para el diagnóstico etiológico de la infección. Una de las ventajas que posee la RT-PCR es la versatilidad de las muestras en donde se puede realizar, desde hisopos conjuntivales y sangre, hasta extensiones citológicas o biopsias. Las mayores cargas parasitarias se encuentran en muestras de médula ósea, seguido de ganglio linfático. No obstante, incluso en estos tipos de muestra y en estadios de enfermedad graves de leishmaniosis es posible encontrar cargas bajas.13
La IFI se considera el método gold standard para la detección de anticuerpos frente a Leishmania. No obstante, la ELISA de antígenos inmunodominantes recombinantes también proporciona una excelente sensibilidad y especificidad.
El objetivo de las pruebas serológicas es demostrar la exposición a Leishmania spp. mediante la detección de anticuerpos. Los métodos más usados son los tests cualitativos, como los tests rápidos, o los cuantitativos, entre los cuales la inmunofluorescencia indirecta (IFI) y la ELISA son las técnicas más presentes.
La IFI se considera el método gold standard para la detección de anticuerpos frente a Leishmania. No obstante, la ELISA de antígenos inmunodominantes recombinantes también proporciona una excelente sensibilidad y especificidad. Esta última tiene la ventaja de ser automatizada y no depender del observador.12
La interpretación de un resultado serológico positivo muchas veces es un reto para el veterinario clínico. La seroconversión puede tardar hasta 3 meses desde la infección en condiciones experimentales y hasta 5 en condiciones naturales. Durante la temporada activa del vector muchos pacientes pueden seroconvertir, que, si poseen una respuesta celular óptima, los títulos suelen ser bajos o incluso llegar a desaparecer a lo largo del tiempo.14
Por el contrario, una diseminación del parásito incontrolada desencadena una respuesta humoral excesiva, resultando en un título de anticuerpos alto o muy alto y acompañarse de anormalidades clínicopatológicas compatibles con la enfermedad.12 Por todo esto, la cuantificación serológica en un laboratorio de referencia, después de obtener un resultado positivo en un test rápido en clínica, junto con la evaluación clí-
nica, es fundamental para interpretar correctamente el resultado del test y determinar si un perro está enfermo y necesita tratamiento o si solo requiere ser monitorizado.
Leishmaniosis y coinfecciones
La leishmaniosis canina puede ser la puerta de entrada para coinfecciones en zonas endémicas y favorecer la progresión clínica en gran medida por un desequilibrio del sistema inmunitario debido a la interacción con estos otros patógenos.15 Los perros con leishmaniosis clínica presentan una mayor tasa de coinfecciones con otros patógenos transmitidos por vectores en comparación con los controles sanos.16
En concreto, el riesgo de mayor positividad para Ehrlichia canis/ewingii es superior si se compara con perros control sanos, a pesar de una prevención de ectoparásitos y de un estilo de vida similares.17
Por tanto, Ehrlichia canis podría potenciar la progresión de la leishmaniosis canina y se recomienda la evaluación de un panel más amplio de enfermedades transmitidas por vectores cuando no se evidencian anormalidades clínicopatológicas específicas para este tipo de infecciones en zonas endémicas. Esto es clave para evitar diagnósticos erróneos y tratamientos ineficaces.18,19 En resumen, la leishmaniosis canina supone un reto diagnóstico para el clínico ante su amplio espectro de presentaciones.
El veterinario tiene multitud de opciones para su diagnóstico, pero su comprensión en su interpretación es la clave para una correcta estadificación. Ante presentaciones atípicas y/o graves de enfermedad clínica, se debería siempre tener presente la posibilidad de coinfecciones en el diagnóstico diferencial e incluir su correspondiente testaje en el protocolo diagnóstico.
Referencias:


El manejo global de estos pacientes debe incluir principalmente: la administración de enzimas pancreáticas exógenas, manejo nutricional y suplementación con cobalamina.

Field Scientific Communication Specialist
La insuficiencia pancreática exocrina (IPE) se produce como consecuencia de la incapacidad de las células acinares pancreáticas para producir la cantidad adecuada de enzimas, lo que da lugar al síndrome de maladigestión y malabsorción y a sus correspondientes signos clínicos, como la pérdida de peso y la diarrea (esta última mucho más frecuente en perros que en gatos). Esto conduce a un deterioro progresivo y grave del estado de salud del paciente.
La atrofia acinar pancreática es la causa más frecuente de IPE en el perro, sobre todo en determinadas razas como el Pastor Alemán y el Chow Chow. En el caso de los gatos, se cree que la pancreatitis crónica es la causa más frecuente de IPE, aunque también puede ser debida a otras causas. En el caso del gato, y a diferencia del perro, no existe una predisposición significativa en cuanto a la raza.
Diagnóstico de la IPE
El diagnóstico de la IPE se confirma mediante la medida de la TLI (trypsin like immunoreactivity) que detecta una disminución en la capacidad secretora pancreática. Esta determinación es específica de especie, por lo que se hace necesario el empleo de la técnica específica para la especie canina (cTLI) o para la especie felina (fTLI). Si queremos identificar la causa subyacente, es necesaria la realización de biopsia pancreática.
Tratamiento de la IPE
El manejo global de estos pacientes debe incluir principalmente: la administración de enzimas pancreáticas exógenas, manejo nutricional y suplementación con cobalamina.
Enzimas pancreáticas exógenas
Las enzimas pancreáticas se pueden administrar en forma de polvo o granulado, cápsulas o comprimidos. Existe la posibilidad de administrar páncreas crudo, pero debido al potencial riesgo microbiológico, generalmente esta práctica no es recomendada.
Manejo nutricional
No existe una estrategia universal estándar para todos los casos de IPE, por lo que una evaluación nutricional individualizada para ajustarse a las circunstancias de cada paciente es clave. Los gatos y perros pueden responder al tratamiento con enzimas pancreáticas exógenas con una gran variedad de dietas. Tradicionalmente, y sobre todo en el caso del perro, se ha descrito el uso de dietas bajas en grasa. Esta estrategia, además de carecer de evidencia, puede no ser la ideal para los pacientes
No existe una estrategia universal estándar para todos los casos de IPE por lo que una evaluación nutricional individualizada para ajustarse a las circunstancias de cada paciente es clave.
Signos clínicos de la IPE
Los signos clínicos más frecuentes en el perro incluyen aumento en la frecuencia y volumen de las heces, esteatorrea, pobre condición corporal, polifagia y coprofagia. En el caso de los gatos la pérdida de peso es el signo clínico más frecuente y la diarrea, aunque se presenta de una forma habitual, no es tan frecuente como en la IPE canina. Otros signos que pueden aparecer en el gato son mal aspecto del pelaje, polifagia, anorexia y vómitos.
Cuando la causa de la IPE es una pancreatitis crónica, suele haber una destrucción tanto del páncreas exocrino como endocrino, por lo que en estos casos cabe la posibilidad de concomitancia con diabetes mellitus y, en consecuencia, con sus signos clínicos asociados.
con índices de condición corporal bajos (ICC<4) que, como ya se ha mencionado, es un signo clínico bastante frecuente, ya que estas dietas suelen tener densidades energéticas moderadas.
Una buena opción de inicio en el manejo nutricional de la EPI sería la recomendación de un alimento altamente digestible (dieta intestinal o dieta a base de proteína hidrolizada), sin restricción de grasas y la suplementación enzimática.
Se ha sugerido incluso el uso de dietas con un contenido elevado en grasas por dos razones: su elevado contenido energético y una hipotética protección de las grasas a la destrucción de las enzimas exógenas por parte del ácido del estómago. Incluso se han descrito casos de perros con EPI e intolerancia alimentaria con buena respuesta a dietas en base a proteína hidrolizada y altas en grasa. En los gatos no está indicada una restricción de grasas en procesos digestivos en general y, por lo tanto, tampoco en procesos pancreáticos. Por todo lo anteriormente descrito, una buena opción de inicio en el manejo nutricional de la EPI sería la recomendación de un alimento altamente digestible (dieta intestinal o dieta a base de proteína hidrolizada), sin restricción de grasas y la suplementación enzimática. Una vez el paciente esté estabilizado con un buen ICC, podría intentarse el cambio a un alimento de mantenimiento y evaluar la respuesta. En el caso de aquellos perros en los que, aun así, persista la esteatorrea, puede considerarse el cambio a un alimento bajo en grasas y evaluar la respuesta.
Suplementación con cobalamina
Tanto en perros como en gatos es importante la monitorización de los niveles de cobalamina sérica y ante la presencia de hipocobalaminemia (factor pronóstico negativo en perro asociado a una menor supervivencia) se hace necesaria la suplementación con cobalamina.

Incluso en gatos esta suplementación puede resultar beneficiosa aun estando los niveles de cobalamina sérica dentro de la normalidad (especialmente en el extremo inferior del rango de referencia), ya que posiblemente presenten una deficiencia de cobalamina celular. La vía tradicional de administración de cobalamina es parenteral, aunque en perros, recientes estudios indican efectividad con suplementación diaria vía oral. Estudios en gatos revelan también eficacia de esta suplementación oral en enfermedad gastrointestinal, pero no hay estudios que evidencien eficacia en el caso concreto de la IPE. Por esta razón, se sigue recomendando la administración parenteral de cobalamina en todos los gatos con IPE.
Ante la presencia de hipocobalaminemia (factor pronóstico negativo en perro asociado a una menor supervivencia) se hace necesaria la suplementación.
En el manejo nutricional de la insuficiencia pancreática exocrina, tanto en gatos como en perros, no existe una estrategia nutricional universal que sea válida para todos los pacientes y una evaluación nutricional y un posterior seguimiento serán, por tanto, claves para encontrar la respuesta nutricional más adaptada dependiendo del paciente. Aun así, una buena opción de inicio sería un alimento altamente digestible y sin restricción de grasas ni energía.
Bibliografía:
Revista Focus 33.1. Insuficiencia pancreática exocrina en el gato. Panagiotis G. Xenoulis. 2023 Revista Focus 29.3. Insuficiencia pancreática exocrina en el perro. María Dolores Tabar Rodríguez. 2020 Manual Práctico de Nutrición Clínica en el perro y el gato. C.Villaverde Haro. M.Hervera Abad. 2ª edición Ruaux CG. Cobalamin in companion animals: diagnostic marker, deficiency states and therapeutic implications. Vet. J. 2013;196:145-152
Westermarck E, Wiberg M. Exocrine pancreatic insufficiency in the dog: historical background, diagnosis and treatment. Top Companion Anim Med 2012;27:96-103.
Este gato fue diagnosticado de IPE y EII; a pesar de tener un apetito normal presentaba una baja puntuación de la condición corporal (2/9) y un mal estado del pelaje. ©Panagiotis G. Xenoulis

AniCura Iberia reafirma su apuesta y amplía su red de centros en Madrid y Bizkaia
El Congreso Mundial de Dermatología Veterinaria confirma la evidencia de la FLE en la reducción del uso de antimicrobianos

AniCura expande su red de hospitales veterinarios de vanguardia en España por medio de la reciente adquisición de AniCura Madrid Este Hospital Veterinario y la incorporación de Visualvet en el equipo de oftalmología de AniCura Indautxu Hospital Veterinario (Bilbao). “Con 82 hospitales, clínicas y centros veterinarios en Iberia y más de 1.900 empleados, reafirmamos nuestra apuesta en medicina veterinaria con una amplia gama de servicios de alta especialización. Madrid y Bizkaia son dos regiones clave para AniCura. Ambos centros cumplen con los más altos estándares de calidad para asegurar el mejor cuidado a nuestros pacientes. Damos la bienvenida a los veterinarios que ahora son parte de AniCura”, explica Myriam Gonçalves, directora de Operaciones de AniCura Iberia.
Zoetis amplía las funciones de Vetscan Imagyst con análisis del sedimento urinario basado en IA

Zoetis España ha lanzado una ampliación de su plataforma de multiaplicación de diagnóstico, Vetscan Imagyst, para incluir el análisis de sedimento urinario con Inteligencia artificial en perros y gatos. Esta nueva aplicación permite realizar análisis precisos del sedimento de la orina fresca en la clínica, lo que permitirá a los veterinarios tomar decisiones rápidamente. Gracias a la inteligencia artificial de aprendizaje profundo, el análisis de sedimento urinario por IA de Vetscan Imagyst, ofrece a los veterinarios resultados coherentes y precisos, en cuestión de minutos, para la planificación de tratamientos óptimos y personalizados que benefician tanto a las mascotas como a sus tutores.

Calier continúa mejorando su presencia digital a través del relanzamiento de su web www.calier.com, una plataforma que ahora se renueva con más secciones a través de las cuáles se pueden conocer mejor sus líneas de negocio (animales de compañía, avicultura, ganadería y apicultura) y las soluciones de referencia que ofrece en cada una de ellas. Los usuarios también pueden conocer más de cerca las instalaciones que Calier tiene en España e internacionalmente y que muestran su compromiso industrial. Otra novedad es la sección de autovacunas, un campo emergente en el sector donde Calier destaca por su conocimiento y experiencia en el desarrollo y fabricación de este tipo de soluciones que ofrecen la protección necesaria allí donde no llegan las vacunas comerciales.
VetFamily y qdq se unen para facilitar la transformación digital del sector veterinario

En un esfuerzo conjunto para modernizar el sector veterinario, VetFamily y qdq han firmado un acuerdo de colaboración que permitirá a más de 600 clínicas y hospitales veterinarios en España acceder al Kit Digital. Esta iniciativa busca mejorar la eficiencia operativa de los centros y facilitar la vida de los profesionales de salud y de los propietarios de las mascotas. Gracias a esta colaboración, qdq tendrá la oportunidad de acompañar a estos negocios en su proceso de digitalización. El Kit Digital incluye servicios como la gestión de citas online, que facilita a los clientes la programación de visitas a cualquier hora del día.
Cientos de dermatólogos veterinarios participaron en el simposio “Harnessing Fluorescent Light Energy (FLE) to Promote Antimicrobial Stewardship and Wound Healing in Veterinary Dermatology”, organizado por Vetoquinol en Boston (EE. UU.) en el marco del décimo Congreso Mundial de Dermatología Veterinaria. Referentes como Luisa Cornegliani, Amelia White y Anthony Yu compartieron investigaciones y conocimientos clínicos sobre la aplicación de la FLE en la práctica clínica y su relación con la reducción del uso de antimicrobianos. Durante el simposio se presentaron unas directrices, desarrolladas usando el método Delphi, que recomiendan prácticas para implementar y optimizar la terapia FLE basadas en el consenso de expertos, la experiencia clínica y la evidencia práctica de 150 veterinarios.


La Plataforma One Health y MSD lanzan una innovadora y pionera iniciativa para acercar “Una Salud” a la universidad

Boehringer Ingelheim ha anunciado la adquisición de Saiba Animal Health AG, una empresa centrada en el desarrollo de nuevos medicamentos terapéuticos para abordar enfermedades crónicas en animales de compañía. Con esta operación, Boehringer Ingelheim fortalece su porfolio de investigación y desarrollo (I+D) en salud animal, específicamente en la categoría de soluciones terapéuticas para mascotas. Y es que, a medida que aumenta la esperanza de vida de los animales de compañía, también lo hace la necesidad de un tratamiento eficaz de enfermedades debilitantes. La innovadora plataforma tecnológica de Saiba Animal Health utiliza un enfoque de vacuna terapéutica pionero, que está diseñado para crear una respuesta inmunitaria dirigida a enfermedades crónicas como la alergia, la inflamación y el dolor.
Dechra Academy y NOMV lanzan una serie de cursos integrales de bienestar mental

La Plataforma One Health y MSD en España, con el apoyo de la Conferencia de Rectores y Rectoras de las Universidades Españolas (CRUE), han puesto en marcha la iniciativa “Una Universidad, una Salud”. Este proyecto pionero tiene como objetivo ofrecer una acción de concienciación y divulgación del enfoque One Health para incrementar el conocimiento sobre el concepto, sembrar la semilla del enfoque multidisciplinar tanto en el profesorado como en el alumnado y reconocer las acciones de los alumnos que incorporen esta perspectiva trabajando en equipo sobre salud. La iniciativa culminará con el Premio Nacional One Health que consistirá, siempre que sea posible de conformidad con los perfiles ganadores, en una estancia formativa en el laboratorio biofarmacéutico MSD en España. “Trabajamos por el desarrollo profesional de las personas por lo que creemos que no solo sembrará la semilla del enfoque One Health en los profesionales del futuro, sino que será un paso importante en el desarrollo profesional de los premiados y les brindará nuevas perspectivas y oportunidades para su carrera”, explica Cristina Nadal, directora ejecutiva de Policy MSD en España.

Ceva Salud Animal patrocinó la jornada de formación presencial “Ecocardiografía: un reto para tu negocio”, organizada por el Colegio de Veterinarios de Huesca. La sesión reunió a numerosos clínicos de la región con el objetivo de analizar cuestiones esenciales para su práctica diaria y ayudar a cuidar el corazón de los animales de compañía. La formación, dirigida por la doctora Nuria Sánchez, referente en medicina y cirugía animal y miembro del equipo del centro de referencia Improvet, destacó por su clara aplicación práctica. Los asistentes pudieron explorar las diversas oportunidades que la ecocardiografía ofrece para el negocio veterinario, centrándose especialmente en la ecocardiografía felina y canina.
Pets & Vets lanza su portal de salud para mascotas de España

Pets & Vets anuncia el lanzamiento del portal de salud para mascotas www.petsnvets.es, que marca un hito en la atención veterinaria digital en España. Esta innovadora plataforma no solo ofrece a los tutores de mascotas acceso a una amplia red de veterinarios y servicios especializados, sino que también está completamente adaptada para ser utilizada por personas invidentes, reafirmando el compromiso de la empresa con la accesibilidad y la inclusión. Con una interfaz intuitiva y fácil de usar, los usuarios pueden buscar veterinarios, reservar citas online, acceder a consejos sobre bienestar animal y descuentos exclusivos. La plataforma garantiza que los tutores tengan todo lo necesario al alcance de la mano, inclusive historial clínico, pasaporte y documentación digitalizada, entre otros.
Dechra Academy y Not One More Vet (NOMV) han unido sus fuerzas para presentar una innovadora Serie de Cursos de Bienestar Mental adaptada específicamente a los profesionales veterinarios. Esta colaboración supone un paso importante para abordar el problema crítico de la salud mental en la comunidad veterinaria. Los dos primeros módulos de esta serie, dirigidos por la doctora Taylor Miller (DVM, MS, consejera profesional asociada), están disponibles en Dechra Academy, la plataforma digital de aprendizaje a la carta de Dechra. Los temas incluyen “Sabores de la fatiga” y “Trampas de personalidad”. Los veterinarios dispuestos a embarcarse en un viaje de autodescubrimiento y crecimiento ya pueden acceder a Dechra Academy (https:// academy.dechra.com/learn).

Vets, la nueva serie de vídeos con Churpi y Fosca

Churpi lanza su nueva serie de vídeos Vets, que sigue la vida divertida y singular de un veterinario muy especial y su perra Fosca. Esta sitcom, ambientada en un lujoso apartamento, ofrece una visión humorística y entrañable de la relación única entre un veterinario adinerado y emblemático y su Schnauzer negra, ambos fanáticos incondicionales de los productos Churpi. Los espectadores se verán inmersos en situaciones cómicas y momentos cotidianos que les harán reír, desde diálogos hilarantes hasta escenas divertidas dentro de la casa. Cada capítulo está diseñado para capturar la esencia de la graciosa relación entre el veterinario y su perra. Con una producción inicial de cinco capítulos en Instagram (@churpi_official), se presenta como una iniciativa significativa para el sector.

2024, el lugar de encuentro de los


La ciudad de Madrid se prepara para recibir una nueva edición del Congreso Nacional de AVEPASEVC 2024, que se celebrará del 24 al 26 de octubre en el Palacio Municipal de Congresos, junto a la zona de Ifema. Este evento reunirá a cerca de 5.000 veterinarios de todo el mundo para conocerlas últimas novedades y avances en medicina veterinaria de animales de compañía. Durante los tres días del congreso, los asistentes podrán disfrutar de más de120 horas de formación, donde más de 80 ponentes internacionales compartirán sus conocimientos y experiencias. El Comité Científico ha aceptado más de120 pósteres científicos. Los asistentes podrán participar en la “Presentación de pósteres”. Se otorgarán premios a la mejor comunicación, mejor caso clínico y un premio incentivo para jóvenes veterinarios. El congreso también ofrecerá 10 talleres prácticos renovados, diseñados para profundizar en técnicas específicas como ecografía, odontología, primeros auxilios en especies exóticas, radiología y comportamiento animal, con sesiones interactivas impartidas por expertos internacionales. Más de 100 empresas internacionales presentarán sus productos y servicios más innovadores en una gran exposición comercial, abierta a todos los asistentes, que podrán solicitar su pase en la entrada del palacio.


Felpreva, el antiparasitario de Vetoquinol desarrollado exclusivamente para gatos, ha recibido la certificación “Easy to Give” que otorga la Sociedad Internacional de Medicina Felina (ISFM). Los medicamentos que reciben este sello han demostrado que son innovadores, seguros y especialmente fáciles de administrar a los gatos, y es que Felpreva es el antiparasitario de amplio espectro y larga duración desarrollado específicamente por Vetoquinol para ellos. Tigolaner, un principio activo exclusivo de Felpreva, brinda hasta 13 semanas de protección frente a pulgas y garrapatas, además de ser también tratamiento contra los ácaros, mientras que el prazicuantel y la emodepsida actúan frente a los parásitos internos más relevantes: nematodos gastrointestinales, vermes pulmonares y cestodos.
La plataforma de diagnóstico por imagen Veheri ofrece un servicio único de telerradiología

Veheri es una plataforma en diagnóstico por imagen con acceso gratuito a una comunidad global con casos fascinantes. Además, Veheri ofrece un servicio de telerradiología único: el traductor médico integrado transforma los informes ingleses de los expertos más destacados en inglés en informes en castellano sin perder la totalidad de la información del informe. Existe la opción de descargar un informe simplificado para el propietario. Sin costes adicionales. Los interesados pueden registrarse en www.veheri.com y obtener su primer informe gratuito. Más información a través del correo electrónico info@veheri.com
Distrivet Member, el programa de valor añadido de Distrivet

Distrivet sigue apostando por su programa de valor añadido Distrivet Member. Para todos sus clientes Member, Distrivet ofrece condiciones ventajosas en servicios que ayudan al veterinario en su día a día, centrándose en cubrir sus necesidades y las de su negocio. La iniciativa de la compañía incluye formaciones, asesoramiento integral, servicios de marketing, herramientas de gestión, gestión de residuos y muchas ventajas más. Los interesados en el programa de valor añadido Distrivet Member pueden ponerse en contacto con su delegado comercial de la compañía.
patrocina el Atlas de información al propietario: aparato digestivo

Ecuphar patrocina el Atlas de información al propietario: aparato digestivo, que describe conceptos generales de anatomía y fisiología. Además, repasa la aproximación diagnóstica y terapéutica de las enfermedades frecuentes del tubo digestivo, el sistema hepatobiliar y el páncreas. La obra está concebida para brindar un apoyo visual que ayudará al veterinario a recopilar una anamnesis precisa y explicar las enfermedades de forma sencilla, pero completa, a fin de mejorar la comprensión y el cumplimiento de los tratamientos por parte de los propietarios. Los interesados en un ejemplar del atlas pueden contactar con su delegado de Ecuphar.
Stangest celebra 30 años cuidando la salud de perros y gatos
Stangest, compañía del grupo Cantabria Labs, celebró el 6 de septiembre con sus trabajadores los 30 años que suma en 2024 en el mercado veterinario. El evento empezó con la felicitación virtual de Juan Matji, presidente de Cantabria Labs, antes de que Ramon Moncunill, general manager, repasase historia e hitos del grupo desde sus inicios vendiendo aparatos de diagnóstico para la clínica veterinaria hasta hoy, con más de 70 productos y consolidado en mercado de salud animal. Cristina Moncunill, business development manager, expuso los retos futuros, con nuevos canales, la expansión a más países y la previsión de colaboraciones I+D y ensayos clínicos. Finalmente, la plantilla disfrutó de un taller de belleza conducido por Mencía Hermosa, medical project specialist

Acana patrocina la campaña “El
Autobús
más peludo” organizada por la Fundación

Muestra de su compromiso con la protección y el bienestar animal, Acana ha colaborado en la iniciativa de la Fundación Salvando Peludos “El Autobús más peludo”. El proyecto contó con la visita de caras conocidas como Clara Lago, Nicolás Coronado (embajador de la marca) y Nathalie Seseña, entre otros, quienes dieron visibilidad a la causa y ayudaron a concienciar sobre las ventajas de la adopción. Durante una semana, el autobús con el eslogan “¿Buscas al amor de tu vida? Ellos buscan la familia de su vida” recorrió Madrid e hizo paradas en municipios como Alcalá de Henares, Galapagar, Alcorcón o Navalcarnero. La financiación de parte de la acción por Acana se suma a otras ayudas realizadas recientemente.
Nuevos materiales de Mitex para apoyar a los veterinarios
Alivira España ha lanzado una serie de nuevos materiales diseñados para ayudar a los veterinarios en su rutina de tratamientos otológicos con Mitex. Estos recursos incluyen un folleto actualizado que refuerza la conocida efectividad y seguridad de Mitex a través de sus 5 gotas, 5 acciones y 5 indicaciones. Además, ofrece un póster educativo que sirve como recordatorio de los pasos de la citología ótica. A menudo, la citología es todo lo que se necesita para iniciar el tratamiento adecuado de la otitis externa. La acción incluye un video educacional que los veterinarios pueden mostrar a los dueños de las mascotas para apoyar la prescripción veterinaria, orientando sobre la aplicación correcta y sencilla de Mitex.



LETI Pharma participó en la vigesimonovena edición del Congreso Europeo de la FECAVA, celebrado en Atenas (Grecia) del 12 al 14 de septiembre. Rubén Foj, MSL en leishmaniosis, presentó un póster científico con los resultados de un reciente estudio de campo que evaluó la presencia de alteraciones clinicopatológicas en 209 perros seropositivos de Leishmania aparentemente sanos. Mostraron anomalías en las analíticas de una parte significativa de estos animales (29 casos,14 % del total), manifestando la necesidad de incluir pruebas laboratoriales de rutina en la evaluación del estado de salud de esta población. Cabe destacar la detección de inmunocomplejos circulantes en el 100 % de perros con hallazgos laboratoriales. El depósito de estos en los tejidos está relacionado con un agravamiento de los signos clínicos de la enfermedad (Parody et al., 2019), por lo que se postula como herramienta clave en el diagnóstico precoz de la leishmaniosis clínica.
LeishVet, grupo de expertos en leishmaniosis internacional, celebró un congreso en el que LETI Pharma conoció las novedades en la prevención de esta zoonosis endémica en la cuenca Mediterránea, como parte de su compromiso durante más de 40 años de proporcionar a la comunidad veterinaria los últimos avances en su control.
AniCura apuesta por un nuevo grupo de trabajo especializado en medicina felina
AniCura apuesta por un nuevo grupo de trabajo especializado en medicina felina para ofrecer las mejores opciones terapéuticas. La creación de este grupo de trabajo, formado por los hospitales de Cataluña, Andorra, Baleares y Zaragoza, permite que los responsables del área científica creen una red de colaboración y se lleve a cabo una formación horizontal entre distintos centros, aportando enriquecimiento técnico y compartiendo experiencias clínicas de todo tipo. “La actividad referenciadora, fundamental en nuestros centros, se ve muy beneficiada de este tipo de acciones, ya que se intenta unificar protocolos y aumentar el conocimiento sobre los equipamientos de los hospitales de este nuevo grupo”, destaca Arnau Bernet Royo, medical veterinary partner de AniCura España zona Noreste.
Nota de Redacción
El Departamento de Redacción de Argos informa a los lectores de que las “Noticias” publicadas en esta revista deben tener como máximo 125 palabras y contar con un único elemento gráfico (fotografía o logotipo) para ilustrarlas.


B. Braun VetCare presenta en octubre este nuevo monitor multiparamétrico, diseñado para ampliar su línea de equipamiento con una opción avanzada y accesible a todas las clínicas, permitiendo a los veterinarios un control más efectivo sobre la salud de los pacientes. Equipado con tecnología avanzada y funcionalidades esenciales para la práctica clínica diaria, este monitor representa el ayudante indispensable en la atención anestésica y complementa la amplia gama de equipos de anestesia de B. Braun VetCare.
■ Para más información: B. Braun VetCare www.bbraun-vetcare.es/solicitud
Lodisure es amlodipino en comprimidos indicado para el tratamiento de la hipertensión felina. Dechra ofrece así una nueva opción para el tratamiento y prevención de una enfermedad cuya prevalencia es del 13 % en gatos mayores de 9 años, y está íntimamente ligada a ERC e hipertiroidismo. Se presenta en forma de comprimidos divisibles que contienen 1 mg de amlodipino. Su posología, según las recomendaciones de las guidelines de ACVIM, es 0,1-0,25 mg/kg al día. De esta forma es posible ajustar de manera más exacta el tratamiento de los pacientes según su peso.

■ Para más información: Para más información: Dechra Veterinary Products – www.dechra.es
Alvet Escartí y Petia llegan a un acuerdo para la distribución de la vacuna Neoleish contra la leishmaniosis
Petia Vet Health, perteneciente al grupo biotecnológico Zendal, y Alvet Escartí han llegado a un acuerdo para distribuir Neoleish. Esta vacuna se distingue por ser la primera en utilizar ADN plasmídico superenrollado pPAL-LACK, que codifica la proteína LACK de Leishmania infantum


Neoleish destaca por su seguridad excepcional, ya que no provoca ninguna reacción adversa. Esto aporta tranquilidad tanto a los veterinarios como a los tutores de mascotas. Su sencilla administración, a través de una simple pulverización nasal, simplifica el proceso de vacunación eliminando la necesidad de aplicar inyecciones subcutáneas y sus posibles complicaciones. Este acuerdo entre Alvet Escartí y Petia supone un avance en la prevención de esta enfermedad zoonótica que afecta a 385.000 perros al año en España. La disponibilidad de Neoleish mejorará la calidad de vida de los animales, fortaleciendo la salud y el bienestar en el ámbito veterinario.

■ Para más información: Petia Vet Health/Alvet Escartí
Acana renueva la imagen
Acana actualiza los envases de sus recetas para gatos, ahora con una distinción más clara de las recetas con y sin cereales y fotografías que muestran la alta calidad de sus ingredientes. La renovación viene acompañada de pequeños cambios en la formulación, como la inclusión de molleja en la gama Highest Protein (sin cereales), alimento nutritivo rico en proteínas y minerales como hierro, zinc y fósforo. Además, el cambio de aceite de abadejo por aceite de pescado en la gama Premium Cat aporta ácidos grasos omega-3 y vitaminas A y D.

■ Para más información: Acana info@masale.com
Nota de Redacción
El Departamento de Redacción de Argos informa a los lectores de que las “Novedades comerciales” publicadas en esta revista han sido estrictamente elaboradas con la información remitida por las propias empresas en lo referente a las características técnicas y particularidades de los distintos productos y/o promociones.

Formación online
Iniciación a la Ecocardiografía. Claves de Interpretación Clínica
■ Inicio: octubre de 2024
■ Lugar: online
Actualización en el Manejo Anestésico, Analgésico y durante la Sedación en la Clínica Cotidiana de Pequeños
Animales
■ Inicio: 8 de octubre de 2024
■ Lugar: online
Iniciación a la Odontología en Animales de Compañía
■ Inicio: 15 de octubre de 2024
■ Lugar: online
Avanzando en la Valoración de los Órganos Abdominales
■ Inicio: 5 de noviembre de 2024
■ Lugar: online

Para más información: Grupo Asís
Tel.: 667 759 802 www.edicionesedra.com
XI Congreso de Veterinarios de Castilla y León
■ Fecha: del 8 al 10 de noviembre de 2024
■ Lugar: Segovia
Para más información: www.congreso.sivecal.es
III Jornada del Grupo de Oncología de AVEPA-Gevonc
■ Fecha: 16 y 17 de noviembre de 2024
■ Lugar: Sevilla
Para más información: www.avepa.org
Taller teórico-práctico de Manipulación, Contrastación y Refrigeración de Semen Canino
■ Fecha: 23 y 24 de noviembre de 2024
■ Lugar: Murcia
Para más información: https://avepa.org/taller-gerpac24
XIX Congreso Andaluz de Veterinarios Especialistas en Animales de Compañía
■ Fecha: 29 y 30 de noviembre de 2024
■ Lugar: Cádiz
Para más información: www.congresoveterinario.es/2024
XXIV Congreso Internacional de Medicina y Cirugía Equina
■ Fecha: 22 y 23 de noviembre de 2024
■ Lugar: Sevilla
Para más información: www. congresoequino.com/2024

XIV Congreso Anual de la Asociación de Veterinarios Especialistas en Équidos (AVEE)
■ Fecha: del 19 al 21 de febrero de 2025
■ Lugar: Jerez de la Frontera (Cádiz)
Para más información: www.avee.es
III Congreso Internacional de Sanidad y Bienestar Animal
■ Fecha: del 14 al y 16 de noviembre de 2024
■ Lugar: San Lorenzo del Escorial (Madrid)
Para más información: https://congreso.colvet. es/cgr/v5
Veterinary Meeting Expo (VMX) 2025
■ Fecha: del 25 al 29 de enero de 2025
■ Lugar: Orlando (EE. UU.)
Para más información: https://navc.com/vmx
London Vet Show 2024
■ Fecha: 14 y 15 de noviembre de 2024
■ Lugar: Londres (Reino Unido)
Para más información: https://london.vetshow.com

clínico
Análisis clínicos
Laboratori CatBio, S.L. 934 516 643
Laboratorios de análisis Dr. Echevarne 935 040 126 Análisis clínicos y anatomía patológica
Laborti Veterinària, S.L 934 851 786 / 938 444 999 -
LETI Pharma 933 945 350 Alergia, microbiología, histología y leishmaniosis veterinaria Uranolab 934 482 521
VORAN NETZ, S.L. 935 820 203
Cádiz Laboratorio Maña-Watson 956 110 026
Córdoba Laboratorio Veterinario Garfia 957 276 351
Granada Anapath 958 292 345
Laboratorios GASSET (GRUPO DAV SALUD) 958 042 121
León INDILAB 900 701 128
Lugo AMSvet (AMSlab Group) 982 808 074
Madrid
Alergovet 914 134 472
IDEXX Laboratorio de Referencia 916 376 317
Laboratorio de análisis veterinarios Dr. Barba 902 190 942
LAV 913 838 493
CIAB, Laboratorio de Referencia Veterinaria 913 613 314
Diavet S.L. 914 966 013
Laboratorio veterinario LABOKLIN, S.L. 644 030 557
Uranolab 934 482 521
Málaga Histolab Veterinaria 952 664 819
Pontevedra Lema y Bandín 986 437 400
Laboratorio del Dr. Valenzuela 986 858 313
Valencia Laboratorio ACVLAB 963 532 377
Sagunto 99 963 485 931
Analítica Veterinaria 946 744 251
Análisis clínicos
Análisis clínicos
Análisis clínicos
Biología molecular
Histología
Diagnóstico Laboratorial Integral
Diagnóstico laboratorial
Toxicología veterinaria
Alergias veterinarias
Análisis/Diagnóstico clínico
Biología molecular
Análisis clínicos
Análisis clínicos
Alergia e infección vet.
Diagnóstico clínico
Análisis clínicos
Histología
Hematología
Análisis clínicos
Análisis clínicos
Inmunología
Histología
EDITOR Julio Allué1
Contacte con nosotros a través de argos@grupoasis.com si desea publicar un artículo, y remita sus notas de prensa a notasdeprensa@grupoasis.com
REDACCIÓN Sheila Riera1, Natalia Sagarra1 M. Ángel Ordovás, Israel Salvador
RESPONSABLE DE DISEÑO Ana Belén Mombiela
JEFA DE DISEÑO Teresa Gimeno
DISEÑO Y MAQUETACIÓN Erica García, Marian Izaguerri, Marisa Lanuza
Escriba a publicidad@grupoasis.com si desea anunciarse, y a suscripciones@grupoasis.com para altas, bajas o modificaciones en sus datos de contacto
RESPONSABLE DE PUBLICIDAD Ana Caballero1
PUBLICIDAD Pilar Angás1, Jorge Pérez1, Laura Montón1, María Puig2, Marta Suárez de Peón3
SOPORTE DE PUBLICIDAD Raquel Miguel, Rocío Sarrate
Vizcaya
Microvet laboratorio 944 913 912
Tenerife Laboratorios Taoro 922 353 158
Endocrinología
Exóticos
ADMINISTRACIÓN Beatriz Sanz, Carmen Ezquerro, Miriam de la Torre
Zaragoza Laboratorios Albéitar 976 306 495
Hematología
Aravet Laboratorios 976 598 653
Análisis clínicos Exopol 976 694 525 Microbiología
SUSCRIPCIONES suscripciones@grupoasis.com
1Licenciado/a en Veterinaria, 2Graduada en Farmacia, 3Doctora en Veterinaria
EMPRESA EDITORA Grupo Asís Biomedia, S.L.
PREIMPRESIÓN E IMPRESIÓN Grupo Edelvives
EMPRESA MANIPULADORA Grupo Edelvives
DEPÓSITO LEGAL: Z-2106/98 - ISSN: 1699-7875


y Rehabilitación Veterinaria
Hospital Veterinari Cardedeu, S.L. 938 462 051 Urgencias, Cirugía y Medicina Interna
Hospital Veterinari del Mar 930 217 812 Cirugía, urgencias, exóticos, oftalmologia, etc.
Hospital Veterinari Desvern 934 990 648 Ortopedia y Traumatología
IMPROVET 600 921 927 Diagnóstico, Cirugía, Formación
Serv., Urgenc. i Ref. Veterinàries Diagonal, S.L. 934 594 500 Urgencias y Cuidados Intensivos
Burgos Hospital Veterinario Valderrama 947 277 843 Traumat., Neurocirugía y Med. Interna
ASSISVET Veterinària 964 229 838 Exóticos y Medicina Felina
Centro Médico Veterinario Benicarló 964 472 610 Dermatología
Castellón
Nexo Hospital veterinario CMV Castelló 964 723 697 Neurología-Neurocirugía, Trauma-Ortopedia, Imagen (TAC, endoscopia, eco), UCI, Derma
Clínica Veterinaria St. Vicent CB 964 672 907 Urgencias, Dermatología
Hospital Veterinario Sagrada Familia 964 254 888 Urgencias, UCI, Cirugía, Cardiorrespiratorio
Servicios Veterinarios Albeytar 964 691 025 Medicina Cardio-Respiratoria
Córdoba Mascoderm 957 300 977 Dermatología canina y felina
Gran Canaria Clínica Ocular Veterinaria 928 696 510 Oftalmología
ADERVET, Atención Dermatológica Veterinaria 914 984 112 Dermatología
Centro Médico Veterinario Delicias 915 275 828 Urg., Traum., Neur., Oftal., Card., Exót. y Cir. 300
Centro Veterinario Auditorio 915 631 167 Endoscopia y Cirugía Endoscópica 12
Centro Veterinario los Sauces 914 454 305 Exóticos 50-60
Centro Veterinario Prado de Boadilla 916 322 351 Neurología y Neurocirugía
Centro Quirúrgico Veterinario Tobío 913 881 990 Cirugía y Traumatología
Clínica Veterinaria Alberto Alcocer 913 452 515 Urgencias, Hospitalización y Exóticos 150-200
Clínica Veterinaria Ciudad Ángeles, S.L. 913 175 562 Urgencias
Clínica Veterinaria El Bosque 916 167 485 Exóticos 40-50
Clínica Veterinaria Ignacio Trobo 629 111 305 Odontología, Cirugía maxilofacial y general
Clínica Veterinaria Las Rozas 916 370 277 Homeopatía
Clínica Veterinaria Río Duero, S.L. 916 472 336 Traumatología-Odontología 15-20
Clinica Veterinaria Unzeta S.L. 917 588 393 Medicina Felina, Quirófano y Hospitalización 250-75-30
Clínica Veterinaria Velázquez 915 627 769 Dig., Laparosc., Odontol., Oncol.
Gattos 915 040 651 Medicina Felina, Comportamiento Felino 20 Habana Boston Centro Veterinario 911 406 072 Rehabilitación de pequeños animales 15
Hospital Veterinario Fuente el Saz 916 200 098 Urgencias 24 h 200-300
HURVET 914 173 977 Urgencias y Hospitalización 100
Tris Sampayo (ENDOVES) 619 236 325 Endos. diag. e intervencionista y cirug. de mín. invasión 50-75
Javier Collados. Sinergia Veterinaria. 911 339 038 Odontología y Cirugía Oral PA, Exóticos 60
Vetcare hospital veterinario 24h 916 200 098 Urgencias, hospit., cirugía, Endosc., traumat. y rehab. 200-500
VETERCOL, S.L. 918 915 439 Endoscopia flexible y rígida 8-10
Vetsia 914 984 112 Rehab., Diagnóstico Imagen y NeurologíaMálaga
Murcia
Animal Bluecare Hospital 952 665 050 Oncol., Card., Exóticos, Oftal., Endoscopia, Med. InternaMundo Animal 952 050 682 Exóticos: aves, reptiles y peq. mamíferos 30
Myramar Animal Hospital & Exotic VetMed 952 588 543 Traumatología y Ortopedia/Exóticos 20-30
Animalicos Hospital de Día Murcia 968 967 966 Traumatología, Neurología, Oncología y Fisioterapia 70-100
Clínica Veterinaria Bonafé 968 847 478 Endoscopia y cirugía de mínima invasion 40-60
Hospital de Urgencias Veterinarias Región de Murcia 968 899 280 Urgencias y Cuidados Intensivos 120-130
Hospital La Flota 968 246 122 Endoscopia flexible y rígida, Urg. y Cui. int. 100
Navarra Centro Veterinario San Fermín 948 230 802 Traumatología, Ecocardiografía y Neurología 40
Sevilla Centro Veterinario Bormujos 955 725 684 Exóticos 100-120
H.V. Guadiamar-servicios veterinarios de referencia 955 704 804 Neurol.-neurocir., RM-TAC, Cir. lapar. y Anest. 100 Sta. Cruz de Tenerife Hospital Veterinario Taco 922 612 476 Hepatología clínica y Cirugía hepática 15-25
Tarragona Clínica Veterinaria Lagun 977 795 835 Traumat., Dermat. y Exóticos, Urgencias 30-50
Centro Veterinario Silla 961 213 147 Cirugía maxilofacial, Odont. y Cardio.
Clínica Veterinaria Ayora 963 303 979 Endoscopia flexible y rígida
Clínica Veterinaria El Puig 961 472
Valencia
Publicación controlada por Grupo Asís Biomedia está asociado a (miembro de y ) y a (miembro de y )



COMITÉ
DIRECTOR TÉCNICO: Enrique Ynaraja.
ANESTESIA: Antonio González (HV Rof Codina), Ignacio Sández (HV Vetsia)
CARDIOLOGÍA: Joaquín Bernal (Cardiovet), Laín García (HV Molins) Susana Serrano (HV Vetsia)
CIRUGÍA: Joaquín Sopena (UCH-CEU, Valencia), José Rodríguez (FV de Zaragoza)
COMPORTAMIENTO: Xavier Manteca (FV de Barcelona)
DERMATOLOGÍA: Maite Verde (Servicio de Dermatología, FV Zaragoza)
ENDOSCOPIA Y CIRUGÍA DE MÍNIMA INVASIÓN: Jesús Usón (CCMI) Federico Soria (CCMI), Tris Sampayo (Endoscopia Veterinaria)
EXÓTICOS: Albert Martínez-Silvestre (Centro CRARC), Jordi Grifols (Hospital Zoologic de Badalona), Andreu Riera (HV Molins), Beatriz Álvarez Carrión (CV Camaleo)
GESTIÓN Y MARKETING: Miguel Ángel Valera (Centauro Veterinarios), Jorge P. Pascual Ribote (CEVE).
HEPATOLOGÍA CLÍNICA Y CIRUGÍA HEPÁTICA: Alfredo Pérez (CV Taco)
MEDICINA FELINA: Mª Luisa Palmero (CV Gattos. GEMFE)
MEDICINA INTERNA: José Ramón García (CV San Francisco de Asís), Alberto Montoya (Facultad de Veterinaria ULPGC)
MICROBIOLOGÍA Y ENFERMEDADES INFECCIOSAS: Mariano Morales (FV Zaragoza)
NEUROLOGÍA: Xavier Raurell (HV Molins)
ODONTOLOGÍA: Soledad Montes (Cardiovet), Javier Collados (Servicio Móvil de Odontología)
OFTALMOLOGÍA: Inmaculada Morales Fariña (Responsable del Servicio de Oftalmología del Hospital Docente ULPGC)
ONCOLOGÍA: Miguel Laporta (HV Molins)
PARASITOLOGÍA: Juan Antonio Castillo (FV de Zaragoza)
REPRODUCCIÓN Y OBSTETRICIA: Pedro García (FV Lugo)
TOXICOLOGÍA Y FARMACOLOGÍA: Arturo Anadón (FV de Madrid)
TRAUMATOLOGÍA Y NEUROCIRUGÍA: Tomás Fernández (Centro Médico Veterinario) Ramón Sever (Policlínica Veterinaria Rover), Fernando Díaz Santiago (Fauna Clínica Veterinaria)
URGENCIAS: Jordi Manubens (HV Molins)
COLABORADORES: Luis Javier Yus Cantín (Gerente del Col. de Veterinarios de Zaragoza)
La responsabilidad de los artículos, reportajes, comunicados, etc. recae exclusivamente sobre sus autores. El editor sólo se responsabiliza de sus artículos o editoriales. La ciencia veterinaria está sometida a constantes cambios. Así pues es responsabilidad ineludible del veterinario clínico, basándose en su experiencia profesional, el correcto diagnóstico de los problemas y su tratamiento. Ni el editor, ni los autores asumen responsabilidad alguna por los daños y perjuicios, que pudieran generarse, cualquiera que sea su naturaleza, como consecuencia del uso de los datos e información contenidos en esta revista. De acuerdo con la normativa vigente en materia de protección de datos Grupo Asís Biomedia, SL., es responsable del tratamiento de sus datos personales con la finalidad de enviarle comunicaciones postales de nuestras revistas especializadas, así como otras comunicaciones comerciales o informativas relativas a nuestras actividades, publicaciones y servicios, o de terceros que puedan resultar de su interés en base a su consentimiento. Para ello, Grupo Asís podrá ceder sus datos a terceros proveedores de servicios de mensajería. Podrá revocar su consentimiento, así como ejercer sus derechos de acceso, rectificación, supresión, oposición, limitación y portabilidad enviando un correo electrónico a protecciondatos@grupoasis.com, o una comunicación escrita a Grupo Asís en Centro Empresarial El Trovador, planta 8, oficina I, Plaza Antonio Beltrán Martínez 1, 50002, Zaragoza (España), aportando fotocopia de su DNI o documento identificativo sustitutorio e identificándose como suscriptor de la revista. Asimismo, si considera que sus datos han sido tratados de forma inadecuada, podrá presentar una reclamación ante la Agencia Española de Protección de Datos (C/ Jorge Juan, 6.

